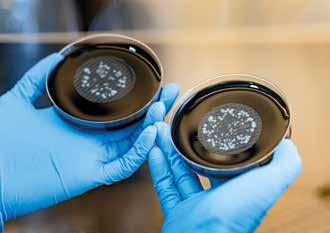

Geometrie semplici e lineari: Alubel Linea permette di rivestire con design il tuo tetto, rendendolo unico e resistente nel tempo.
Bastano 3 veloci passaggi per montare il sistema Linea sulla tua struttura.
Posiziona la lastra, fissa con due viti le staffe alla struttura in legno in modo che sia ben ancorata, installa la seconda lastra semplicemente premendo.








DA ANNI UNA QUESTIONE DI ESTREMA IMPORTANZA SIA
PER LA SALUTE PUBBLICA CHE PER LA SICUREZZA AMBIENTALE.
Intervenire per bonificare gli edifici costruiti con materiali contenenti amianto è una delle aree specifiche nelle quali opera AT Group, regolarmente iscritta all’Albo Gestori Ambientali.Grazie a uno staff qualificato e costantemente aggiornato, il processo di bonifica e smaltimento è eseguito secondo rigidi standard di sicurezza, per garantire la massima protezione per la salute dei lavoratori e degli abitanti delle zone interessate.
AT Group utilizza tecnologie all’avanguardia e segue protocolli rigorosi per il trattamento e la rimozione dell’amianto, assicurando che ogni intervento sia effettuato in conformità con le normative vigenti.
L’impegno di AT Group nella tutela dell’ambiente e della salute pubblica è testimoniato dai numerosi progetti portati a termine con successo. E dalla fiducia che molte aziende e amministrazioni locali ripongono in essa.
La continua formazione del personale e l’adozione di pratiche innovative sono alla base della mission di AT Group: creare un ambiente più sicuro per tutti.
Editoriale

è stato un tempo in cui il ruolo dell’amministratore di condominio si esauriva nella gestione ordinaria, nella convocazione delle assemblee, nella contabilità precisa. Un tempo in cui bastavano prontezza e onestà per conquistare la fiducia dei condòmini. Quel tempo è finito. Il ruolo dell’amministratore di condominio si è trasformato: da semplice gestore a garante di legalità, sicurezza e mediazione. La professionalità oggi si misura nella capacità di aggiornarsi e gestire tematiche complesse come affitti brevi, codici Ateco e Registro anagrafe sicurezza. Gli affitti brevi impongono al locatore di comunicare tempestivamente i dati all’amministratore, rispettando tempi e modalità previste dalla legge. La gestione di queste informazioni è essenziale per evitare contestazioni e garantire la sicurezza del condominio. La classificazione Ateco 2025 ha modificato il ruolo fiscale e previdenziale dei condomìni, rendendoli, di fatto, datori di lavoro. Gli amministratori devono aggiornare la propria posizione fiscale per evitare errori contributivi e assicurativi. Il Registro Anagrafe Sicurezza impone agli amministratori la verifica della documentazione per garantire la sicurezza degli immobili. La mancata gestione può generare responsabilità dirette e conseguenze legali. Su questo numero di Condominio trovate ancora tanti altri temi.
Crisi Superbonus e diritto al compenso. Molti professionisti e amministratori si sono ritrovati senza pagamento per lavori mai iniziati. La giurisprudenza riconosce oggi il diritto al compenso anche per attività preliminari, purché documentate e deliberate.
Lista dei condomini morosi e nuove responsabilità. La Cassazione ha stabilito che l’amministratore risponde personalmente per la mancata comunicazione dei morosi al creditore, aumentando i rischi di richieste risarcitorie.
Prorogatio imperii e continuità gestionale. Se la nomina dell’amministratore è dichiarata nulla, gli atti da lui compiuti restano validi fino alla nomina del successore, evitando la paralisi amministrativa. Riparto delle spese e vendita di immobili. Le spese condominiali dell’anno in corso e precedente sono solidalmente a carico di venditore e acquirente. Per i lavori straordinari, invece, l’obbligo grava su chi era proprietario al momento della delibera assembleare.
In conclusione, l’amministratore di oggi non è solo un tecnico, ma un esperto giuridico e un organizzatore preciso. La sua evoluzione professionale non è una scelta, ma una necessità per garantire una gestione efficace e sicura del condominio.
Avv. Carlo Pikler Vicepresidente de Il Foro Immobiliare e consulente editoriale
& certificato
Periodico di informazione sul mondo del condominio
Anno 13 - Numero 62 - Aprile/Maggio 2025 Direzione, Redazione, Abbonamenti, Amministrazione e Pubblicità
Head office, Editorial office, Subscription, Administration and Advertising Virginia Gambino Editore S.r.l.
Sede legale: Viale Monte Ceneri, 60 20155 Milano - Italy
Sede operativa: Via San Benedetto, 6 24122 Bergamo - Italy Tel. +39 02 47761275 condominio@vgambinoeditore.it
Direttore responsabile / Publisher Virginia Gambino / virginia@vgambinoeditore.it
Direttore editoriale
Livia Randaccio / livia@vgambinoeditore.it
Consulente editoriale Avv. Carlo Pikler
Ufficio commerciale - Vendita spazi pubblicitari
Commercial department - Sale of advertising spaces Via San Benedetto, 6 - 24122 Bergamo - Italy
Tel. +39 02 47761275 - cell. +39 340 1761951 info@vgambinoeditore.it
Collaboratori / Contributors
Rebecca Alberti, Stefano Bianchi, Luca Bridi, Paolo Caliari, Matteo Cazzaniga, Gaia Cigognini, Jessica Collu, Stefano Dionisi, Alice Fugazza, Federico Massoli, Veronica Monaco, Vincenzo Nasini, Marco Noviello, Carlo Pikler, Fabrizio Plagenza, Franco Saro, Giulia Testa, Roberto Tomassoni
Impaginazione e grafica- Layout and graphics
Gaia Avallone, Raffaella Sesia
Periodicità / Frequency of publication
Bimestrale - sei numeri /anno Poste Italiane S.p.A. - Spedizione in abbonamento postale - D.L. 353/2003 (conv. in L. 27/02/2004 n.46) art. 1, comma 1 NE/TN
Registrazione / Registration: N. 224 del 2-07-2013 del Tribunale Civile e Penale di Milano Ai sensi del D. Lgs. 196/2003, informiamo che i dati personali vengono utilizzati esclusivamente per l’invio delle pubblicazioni edite da Virginia Gambino Editore Srl. Telefonando o scrivendo alla redazione è possibile esercitare tutti i diritti previsti.
Come abbonarsi / How to subscribe
Come abbonarsi / How to subscribe Italia annuo
Abbonamento annuo Euro 31,00
Copia singola Euro 8,00
Per abbonarsi è possibile sottoscrivere l’abbonamento online al link: https://www.virginiagambinoeditore.it oppure, fare richiesta ad abbonamenti@vgambinoeditore.it o telefonando al numero +39 02 47761275 Spedizione in contrassegno
Stampa / Printing Pixartprinting S.p.A. stabilimento di Lavis (TN)

Protezione e manutenzione del cappotto termico
Efficienza e sicurezza Per l’involucro edilizio
Responsabilità / Responsability: la riproduzione delle illustrazioni e articoli pubblicati dalla rivista è riservata e non può avvenire senza espressa autorizzazione della Casa Editrice. I manoscritti e le illustrazioni inviati alla redazione non saranno restituiti, anche se non pubblicati, e la Casa Editrice non si assume responsabilità per il caso che si tratti di esemplari unici. La Casa Editrice non si assume responsabilità per i casi di eventuali errori contenuti negli articoli pubblicati o di errori in cui fosse incorsa nella loro riproduzione sulla rivista.
Accesso ai dati condominiali: cosa occorre sapere
Soluzioni avanzate per il ripristino del calcestruzzo
Immaginate New York senza ascensori e senza grattacieli?
Rivestimento di facciata con pannelli bifacciali Hpl
Evoluzione tecnologica e professioni
Più sostenibilità nel condominio
VeryFastPeople. Gestione facile per il condominio
50 Infinity Control Service. Monitoraggio e progetto degli impianti
51
Hdb - Ict Genesia
Csdm - IeS Degasperi
Eurocert. Ict Genesia con Eurocert per la sicurezza
52 Soquick. Un aiuto rapido per amministratori
53 Crotti. Una strategia contro gli incendi
54 Duelle. Ascensori sicuri e intervento rapido
56
Duferco Energia. Un partner solido per 14 mila studi
57 Sinecom. Servizi ad hoc e fotovoltaico
58 Mocit. Soluzioni per la salubrità del condominio 61 Csdm. Tutti al riparo dalla legionella
62 Bergamo gas e luce. Più energia in condominio 66 360Group. Partner totali per la gestione
IMMOBILIARE
Rischi e responsabilità a carico del locatore
Obblighi e gestione
Nel Registro Anagrafe Sicurezza
DIRITTO & ROVESCIO
Nullità della nomina per mancata formazione
Rischio di responsabilità per l'amministratore

Validità degli atti e continuità gestionale
Agente immobiliare e amministratore di condominio
Il dramma silenzioso dei professionisti
Esempio di professionalità nella "giungla romana"
Da non sottovalutare per condomìni e amministratori

L’amministratore custode del regolamento
Con un modulo ridotta la bolletta

Risponde l’avv. Carlo Pikler – Centro Studi Privacy and Legal Advice - Vicepresidente de il Foro Immobiliare
I còndomini possono chiedere all’amministratore l’accesso ai dati personali che li riguardano, in conformità al Gdpr. Ecco le modalità di richiesta, i tempi di risposta e le regole per la gestione delle informazioni.

Un condomino può esercitare il diritto di accesso ai dati che lo riguardano detenuti dall’amministratore di condominio?
Sì. Ai sensi dell’articolo 15 del Gdpr, ogni interessato, dunque anche il condomino, ha il diritto di ottenere dal titolare del trattamento la conferma che sia o meno in corso un trattamento di dati personali che lo riguardano. Se tale trattamento è in corso, il condomino può accedere ai dati personali e ricevere informazioni sulla loro origine, sulle finalità e modalità del trattamento, sui destinatari o categorie di destinatari a cui i dati sono comunicati, e sui tempi di conservazione previsti.
Chi è il titolare del trattamento dei dati in condominio?
Nel contesto condominiale, il titolare del trattamento è il condominio stesso, in persona dei suoi contitolari, ossia i còndomini. L'amministratore agisce invece come responsabile del trattamento, nominato con apposita delibera assembleare o considerato tale per le attività derivanti dal suo mandato.
Come dev’essere formulata la richiesta di accesso da parte del condomino?
La richiesta dev’essere formulata in modo chiaro, preferibilmente
per iscritto, e deve specificare quali dati si desiderano conoscere. Non è necessario motivare la richiesta: il diritto di accesso è riconosciuto dall’art. 15 Gdpr senza necessità di una giustificazione da parte dell’interessato.
Entro quanto tempo
l’amministratore deve rispondere alla richiesta di accesso?
L’amministratore, in qualità di responsabile del trattamento, deve fornire riscontro senza ingiustificato ritardo e comunque entro un mese dal ricevimento della richiesta, come previsto dall’art. 12 del Gdpr. Questo termine può essere prorogato di due mesi nei casi di particolare complessità,
ma in tal caso l’interessato deve essere informato della proroga e dei motivi del ritardo entro il primo mese.
Quali informazioni deve fornire l’amministratore in risposta alla richiesta?
L’amministratore deve fornire:
• La conferma che sia in corso o meno il trattamento dei dati personali.
• L’accesso ai dati personali stessi.
• Le finalità del trattamento.
• Le categorie di dati personali trattati.
• I destinatari o le categorie di destinatari a cui i dati sono stati o saranno comunicati.
• Il periodo di conservazione previsto o, se non possibile, i criteri utilizzati per determinarlo.
• L’esistenza del diritto di chiedere la rettifica o la cancellazione dei dati o la limitazione del trattamento o di opporsi allo stesso.
• L’esistenza del diritto di proporre reclamo a un’autorità di controllo.
• L’origine dei dati personali se non raccolti presso l’interessato.

Da dove può l’amministratore trarre rapidamente queste informazioni?
L’amministratore dovrebbe aver predisposto il Registro delle Attività di Trattamento ai sensi dell’art. 30 del Gdpr. In questo documento sono descritte in modo sistematico le categorie di dati trattati, le finalità, i destinatari, le basi giuridiche e i tempi di conservazione. Consultando il registro, l’amministratore può fornire risposte puntuali ed esaustive alle richieste di accesso.
L’amministratore può negare l’accesso ai dati?
In linea di principio, l’accesso ai dati dev’essere sempre garantito. Tuttavia, può essere rifiutato o limitato se la divulgazione comporterebbe la violazione dei diritti e delle libertà di terzi, ad esempio se la documentazione contiene dati personali di altri còndomini che non possono essere legittimamente divulgati. In questi casi, il Gdpr consente di oscurare o anonimizzare le informazioni non pertinenti.
È necessario conservare traccia delle richieste di accesso ricevute e delle risposte fornite? Sì. Per finalità di accountability (responsabilizzazione), prevista dall’articolo 5, par. 2, del Gdpr, è opportuno che l’amministratore conservi copia della richiesta ricevuta e della risposta inviata, annotando anche nel Registro delle Attività di Trattamento che è stata gestita una richiesta di accesso.
Cosa succede se l’amministratore non risponde o viola il diritto di accesso?
Il condomino può rivolgersi al Garante per la protezione dei dati personali, presentando un reclamo ai sensi dell’art. 77 Gdpr, oppure può adire l’autorità giudiziaria per ottenere tutela ai sensi dell’art. 79 Gdpr. La mancata risposta o un’inadeguata gestione del diritto di accesso può esporre il condominio, e indirettamente l’amministratore, a responsabilità civili e amministrative.


La Epbd Case Green ha prorogato al 2040 l’installazione di nuove caldaie a metano, favorendo sistemi più sostenibili. Le caldaie a condensazione restano valide, ma si aprono alternative come pompe di calore e impianti ibridi. Ecotech analizza sfide, opportunità e rischi di conformità
Veronica Monaco

Con la Epbd Case Green a marzo 2024 il Parlamento Europeo ha prorogato dal 2030 al 2040 il termine per l’installazione di nuove caldaie a gas metano, al fine di consentire ai consumatori di accedere a sistemi più sostenibili e performanti dal punto di vista tecnologico e costi meno gravosi in termini di adeguamento. La proroga riguarda solo le nuove installazioni di caldaie a condensazione, che devono essere in classe energetica A o superiore, mentre per le caldaie tradizionali, e con classe energetica inferiore alla G, la dismissione resta obbligatoria (per quelle in classe inferiore alla F l’obbligo scatterà invece dal 2030, mentre per i modelli sotto la classe E la sostituzione sarà imposta dal 2035). Ma le caldaie a condensazione non sono l’unica opzione per efficientare l’impianto di riscaldamento: sono infatti a disposizione sul mercato anche alternative, quali le pompe di calore o gli impianti ibridi che combinano anche sistemi fotovoltaici. Non tutte le soluzioni però sono intercambiabili, spiega Massimo Chirico, amministratore delegato di Ecotech, azienda di Cormano (Milano) specializzata nell’installazione di canne fumarie, impianti a gas e idraulici, manutenzione caldaie e verifiche antincendio.
Per le caldaie si apre un nuovo orizzonte normativo: cosa cambia?
Per quanto riguarda gli impianti autonomi, o gestiti da impianti a metano, l’ultimo aggiornamento normativo è fermo al 2015, con la norma 7129, in cui sostanzialmente venivano delineate nuove disposizioni per la rimozione delle caldaie a camera stagna, le cosiddette turbo, accelerando di fatto l’avvento delle caldaie a condensazione. Sono quasi dieci anni che, quando si parla di riqualificazione dell’impianto termico, si pensa solo all’installazione di caldaie a condensazione o di caldaie centralizzate. La direttiva europea Ecodesign, e la successiva direttiva europea Casa Green, hanno messo in crisi questo sistema, generando delle preoccupazioni. In realtà, più che le caldaie a condensazione, si è esplicitata la necessità di eliminare gli impianti alimentati da combustibili fossili.


Caldaietta a Condensazione
Modello R2k Condens
Combi-Tech.
Display touch screen e design rinnovato


Cosa si intende per caldaie a premiscelazione?
Si tratta di caldaie a condensazione a camera stagna che presentano al loro interno uno scambiatore che ha la capacità di recuperare il calore prodotto dalla generazione dei fumi e trasmettere questa energia al circuito di riscaldamento fino a diventare condensa. Su questo devo aggiungere che la canna fumaria ha una valenza non secondaria sulla sicurezza, sull’efficienza e sul rispetto delle norme. Di fatto la canna fumaria è molto più importante del generatore e deve rispettare determinate disposizioni progettuali e normative. Purtroppo, nella realtà non è sempre così.
Quali sono i problemi connessi con questo nuovo quadro regolamentare?
Si è creata una forte incertezza. Tutti gli operatori, compresa la Ecotech, sono molto attenti alle innovazioni tecnologiche, come i sistemi ibridi e le pompe di calore, ma di fatto c’è un riscontro molto basso in termini di installazioni reali e di costi, senza contare la durabilità di questi sistemi nel tempo. Alcune tipologie di impianti, come il fotovoltaico collegato ad esempio a una pompa di calore, a oggi hanno un’aspettativa di vita che, molte volte, non riesce ad ammortizzare del tutto i benefici. C’è un altro aspetto di cui si parla poco

legato all’imprevedibilità degli eventi atmosferici. Insomma, la necessità di migliorare gli impianti termici si scontra con la concretezza delle proposte che oggi è fondamentalmente più commerciale che tecnica. Ci sono macchine innovative ma nella realtà trovano difficoltà attuative, sia in termini di risorse economiche che di prestazioni a livello energetico.
Che cosa rischia un condominio che non si mette in regola?
I rischi per un condominio sono rimasti invariati dall’entrata in vigore della legge 46/90, in cui c’è stata una svolta in termini di individuazione delle responsabilità ed è stata introdotta per la prima volta la dichiarazione di conformità. Il rischio in un condominio fa capo nelle parti comuni all’amministratore e prevede una responsabilità penale. Laddove c’è una difficoltà di funzionamento dell’impianto, per mancanza di manutenzione periodica, per negligenza del condomino o dell’amministratore nel caso di impianto centralizzato, il rischio si traduce in un aumento delle possibilità di intossicazione da monossido di carbonio. Questo pericolo è più accentuato in presenza di impianti di vecchia generazione a camera aperta, sia caldaie per uso promiscuo sia scaldabagni per la produzione di acqua calda sanitaria. In quest’ultimo caso c’è una lacuna normativa spaventosa, in quanto non è prevista manutenzione periodica nonostante si tratti di impianti a gas. Rispetto al passato, è aumentata la sensibilità al pericolo di intossicazione da monossido di carbonio, ma ci sono ancora molti impianti che


non vengono manutenuti e controllati, se non a seguito di una ordinanza comunale o dell’Asl, o quando c’è necessità di cambiare il sistema.
C’è anche un pericolo di incendio?
Il pericolo incendio legato a un impianto autonomo con caldaia è scarso. Generalmente questo rischio riguarda altri tipi di impianti, come stufe a pellet o caminetti a legna di vecchia generazione, ma anche in questi casi la manutenzione riveste un ruolo fondamentale. Spesso i residui di resina e legna si depositano nella canna fumaria e, se non viene pulita, possono subire un processo di carbonizzazione e generare un incendio. Ci sono stati diversi casi di tetti che hanno preso fuoco proprio perché è stata trascurata la manutenzione dell’impianto e dello stesso camino. Una adeguata manutenzione degli impianti a legna è indispensabile per scongiurare il pericolo di incendi, mentre nel caso delle caldaie a condensazione la manutenzione è legata all’efficienza del sistema e a scongiurare il rischio di intossicazione da monossido di carbonio.
Ogni quanto va effettuata la manutenzione?
Ad eccezione del periodo di garanzia, in cui ogni casa madre richiede un controllo annuale, la manutenzione dell’impianto termico, in particolare di quello autonomo, è da effettuarsi ogni due anni e comprende la cosiddetta prova fumi. La consuetudine in ogni caso prevede di fare un controllo ogni anno
e la prova fumi ogni due anni: in questo modo il cliente si assicura il buono stato di salute dell’impianto termico, oltre alla propria sicurezza.
Che cosa rischia un amministratore condominiale in caso di mancata manutenzione?
L’amministratore è responsabile della gestione delle parti comuni. Per parti comuni intendo canne collettive, canne collettive ramificate e canne centralizzate per le centrali termiche. La canna fumaria a tutti gli effetti è una parte comune che fa capo come responsabilità di verifica all’amministratore del condominio: in caso di segnalato pericolo o non intervento, l’amministratore è il primo indiziato.
Cosa rischiano i proprietari?
La manutenzione dell’impianto autonomo che viene allacciato alla canna collettiva fa capo al condomino, quindi ne risponde il conduttore, mentre sull’impianto condominiale è responsabile l’amministratore. Qualora non venga fatta manutenzione, i proprietari si espongono a sanzioni amministrative di centinaia di euro, ma soprattutto possono rischiare il blocco dell’impianto laddove si dovessero effettuare delle
verifiche. Il conduttore ha l’obbligo di fare la manutenzione o il rischio anche per loro è molto alto.
In quali zone operate?
Il nostro raggio d’azione si estende su Milano città e provincia. Abbiamo eseguito lavori anche a Lodi e Monza.
Che cosa comporta mettere a norma una caldaia?
Per mettere a norma una caldaia non funzionale, sia a livello di efficienza della stessa che dello scarico, paradossalmente la prima cosa è verificare il sistema fumario. Purtroppo, lo fanno in pochi. È molto più importante, cavilloso e responsabile verificare come adeguare una canna fumaria, che non installare una caldaia autonoma. Ancora oggi, a causa di un pregiudizio legato alla buona fede o a un ottimismo di superficialità, si pensa che installare una caldaia sia una semplice attività idraulica, ma così non è. Oggi per installare una caldaia a condensazione è necessario conoscere anche l’elettronica, avere competenze per poter inquadrare correttamente l’intervento che si deve fare, quindi conoscere la tipologia di canna fumaria a cui la caldaia andrà collegata. È anzi la prima domanda da porre. Alla fine di ogni intervento viene poi


Radiant Combi-Tech è una gamma di caldaie a condensazione istantanee murali prodotte da Radiant. Queste caldaie sfruttano uno scambiatore a condensazione progettato internamente, garantendo elevati rendimenti sia nel riscaldamento che nella produzione di acqua calda sanitaria
rilasciato un documento, la dichiarazione di conformità, che deve rispettare delle norme ben precise.
Quindi, oltre ad avere competenze idrauliche, che tipo di preparazione deve avere l’installatore?
L’impianto ha una complessità nel suo insieme che va gestita nella sua progettualità. Quindi sicuramente oltre alle competenze idrauliche, l’installatore deve avere competenze termotecniche ed elettroniche. Rispetto a qualche anno fa, l’attività dell’installatore è molto più complessa.
C’è una certificazione sugli installatori?
I requisiti per svolgere questa attività sono diventati più restrittivi e fanno capo alla Camera di Commercio di riferimento. Si tratta delle cosiddette abilitazioni di settore: per operare nel comparto dell’installazione di sistemi termici il professionista deve possedere le lettere C (attività di riscaldamento, di climatizzazione, di condizionamento e di refrigerazione di qualsiasi natura o specie, comprese le opere di evacuazione dei prodotti della combustione e delle condense, e di ventilazione ed aerazione dei locali ndr) ed E (attività per la distribuzione e l’utilizzazione di gas di qualsiasi tipo, comprese le opere di evacuazione dei prodotti della combustione e ventilazione ed aerazione dei locali, che sono tra riscaldamento e impianto termico ndr). Più che una certificazione è un’abilitazione camerale, tant’è che uno degli allegati obbligatori della dichiarazione di conformità è proprio la copia della visura camerale che certifica i requisiti tecnico-professionali del responsabile tecnico dell’azienda installatrice. Oggi per alcuni tipi di impianto non è più sufficiente l’abilitazione, ma è necessario produrre anche il progetto con lo schema dell’impianto e normativo. Purtroppo, in alcuni casi, le dichiarazioni di conformità rilasciate non producono anche gli allegati, che invece costituiscono un aspetto importantissimo. La progettualità non si può fermare all’abilitazione.

Dettaglio Radiant
Quali sono gli impianti che sono soggetti all’obbligo di progetto?
Il progetto è sempre obbligatorio. Possiamo però dire che per gli impianti sotto i 50 kW può essere prodotto direttamente da un responsabile tecnico, che può essere anche una persona esterna alla società di installazione, mentre per gli impianti oltre i 50 kW deve essere redatto direttamente da un professionista iscritto all’albo. La dichiarazione è molto importante e non va sottovalutata nella compilazione perché, in caso di problematiche, è il primo documento ufficiale che può essere contestato.
Quali sono dunque le prospettive per le caldaie a gas?
Per ora la prospettiva è legata esclusivamente al 2040,
Grazie all’esperienza sul campo Ecotech ha partecipato, anche in collaborazione con altre aziende, alla riqualificazione di interi condomini per quanto riguarda la parte impiantistica. L’azienda è in evoluzione tant’è che ha abbinato un piano di gestione degli impianti, proponendo un servizio di manutenzione dei prodotti che installa. Inoltre, non ha mai abbandonato la verifica delle canne fumarie. A oggi,
nonostante ci siano delle responsabilità dirette da parte dei proprietari, degli amministratori, dei progettisti e degli installatori, la necessità di progettazione, verifica e collaudo degli impianti nel loro insieme è ancora sottovalutata. Ecotech, all’attività di verifica e manutenzione, ha deciso di affiancare e sviluppare anche l’attività di riqualificazione antincendio, altro settore sottovalutato nei condomini.
L’immagine si riferisce all’intubaggio di una canna fumaria realizzata con guaina termoindurente non a norma. In molti casi, si deve procedere a un nuovo intervento di messa a norma

data che è stata fissata dalla Comunità europea come termine ultimo per la dismissione di questi impianti.
La nostra esperienza sul campo ci permette di allargare questo orizzonte temporale oltre questi 15 anni: per ora non ravvisiamo criticità legate alla non installazione, e
A Milano più del 60% degli edifici esistenti ha la necessità di attuare interventi atti a mettere il condominio in sicurezza in caso di incendio. Questi interventi riguardano box condominiali, manutenzione delle porte tagliafuoco, adeguamento del filtro fumi, compartimentazione antincendio. Non sempre questi interventi sono di facile esecuzione, anche perché le norme sono diventate molto più restrittive e richiedono una progettualità accurata e un’esperienza da parte del progettista che, a mio parere, deve essere anch’essa soggetta a verifica.
chiunque abbia un problema di riscaldamento o acqua calda sanitaria intende comunque mantenere un impianto autonomo o centralizzato.
Quindi qual è la scelta giusta da fare oggi?
In caso di rinnovamento dell’impianto termico o centralizzato, la scelta è sempre legata allo studio della situazione esistente. Spesso nei condomini che montano scaldabagni solo per la produzione di acqua calda sanitaria viene proposto il passaggio a un impianto elettrico come alternativa, ma alla fine la scelta ricade sempre sull’impianto a gas perché a oggi risulta ancora la soluzione più efficiente, economica e sicura. Per quanto riguarda invece impianti che necessitano anche di riscaldamento, c’è sicuramente una propensione a passare alle caldaie a condensazione, sia che gli apparecchi preesistenti siano a camera stagna, fuori produzione dal 2015, o a camera aperta. Devo dire che anche su questo argomento c’è molta confusione da parte degli operatori, perché molti condomini sono convinti che le caldaie a camera aperta non siano più in produzione, quindi, molte volte si vedono costretti a fare scelte obbligate anche quando non è necessario. In molti casi è infatti possibile installare caldaie a camera aperta. La professionalità è il nocciolo della questione: è importante studiare e considerare il progetto nel suo complesso.
Si parlava prima della lacuna normativa che riguarda gli scaldabagni: ci può spiegare meglio cosa intende?
Da diversi anni si parla di rendere obbligatorio il libretto di impianto anche per gli scaldabagni in modo da avere una periodicità di manutenzione, ma nella sostanza questo non è ancora avvenuto. Sugli scaldabagni c’è uno scarso investimento da parte delle società produttrici a migliorare i propri prodotti. Da diversi anni Radiant ha lanciato sul mercato uno scaldabagno a condensazione omologato, ottimo in termini di efficienza e affidabilità, creando a mio parere un’innovazione sostanziale. Oltretutto questo prodotto ha anche dimensioni compatte che agevolano l’installazione. Per la sola produzione di acqua calda sanitaria, in un condominio o nelle realtà plurifamiliari si presta molto più l’installazione dello scaldabagno a condensazione.
C’è anche una terza via, quella ibrida, di cosa si tratta? Sostanzialmente è l’evoluzione delle caldaie a condensazione. Si tratta di una caldaia integrata a sistemi quali pompe di calore e/o fotovoltaico. È un passo importante legato al risparmio energetico e all’inquinamento atmosferico, ma anche qui è necessario uno studio di fattibilità e una verifica. Spesso si va infatti a cozzare con il sistema fumario esistente. In sintesi, l’ibrido è assolutamente un’evoluzione dell’impianto tradizionale ma nella realtà dei fatti trova importanti difficoltà di installazione nei condomini plurifamiliari, mentre può rappresentare una valida soluzione per le case indipendenti.
Il taglio agli incentivi per le caldaie rischia di pesare significativamente sul settore?
Sicuramente ha creato una reale preoccupazione tra novembre e dicembre 2024, che però è andata lentamente a scemare. Sicuramente lo sconto in fattura, soluzione che esisteva anche prima dell’entrata in vigore del superbonus 110%, sarebbe stata ancora un’ottima formula per incentivare l’installazione di nuovi sistemi più efficienti e migliorare progressivamente la situazione. Ritengo la sua eliminazione un eccesso di severità nei confronti degli utenti. I prezzi si sono abbassati, ma per molti fare un investimento per la sostituzione dell’impianto rappresenta comunque un impegno economico importante.
Qual è l’impatto della direttiva europea Case Green?
C’è una forte aspettativa da parte degli operatori, non quelli che si occupano del settore impiantistico, ma anche tra le imprese che hanno una vocazione esplicita nella riqualificazione esterna delle facciate e dei tetti. C’è anche un grande lavoro di studio e preparazione per quanto riguarda la proposizione di sistemi globali di servizio, ma come ogni novità ha bisogno di tempo per essere assorbita, quindi, probabilmente serve ancora una attività di sensibilizzazione.

Quindi quale tecnologia scegliere per il riscaldamento in condominio?
Come detto prima, bisogna valutare soluzioni su misura. Paradossalmente tecnologie troppo innovative potrebbero essere controproducenti per alcuni impianti, perché non supportate dai preesistenti. Innovare troppo un edificio che non riesce a supportarlo è un errore, sottovalutare la sostituzione di alcuni impianti è un errore: il giusto compromesso è quello di analizzare lo stato di salute di un edificio e fare scelte prudenziali. Non esiste tecnologia che possa essere proposta senza un’accurata diagnosi strutturale e impiantistica.
Quali servizi offre Ecotech rispetto a canne fumarie e caldaie?
Opero nel settore delle canne fumarie dal 1995. L’ attività è rivolta alla verifica e riqualificazione di canne fumarie e caldaiette. Gli impianti non riguardano solo quelli antecedenti alla legge 46/90 ma anche quelli successivi. In molti casi, si è reso necessario intervenire su lavori già eseguiti (per esempio, utilizzo di guaina termoindurente). Oltre alle canne ci occupiamo anche di riqualificazione di impianti autonomi e centralizzati.
Il progetto è obbligatorio anche per le canne fumarie?
Il progetto è necessario anche se un impianto comprende solo la canna fumaria sia essa singola che collettiva. La di.co infatti riporta tra gli allegati obbligatori proprio il progetto. Dopo 35 anni dall’ entrata in vigore della legge 46/90 si sono ridotte notevolmente le irregolarità ma tuttavia molti impianti sono stati realizzati senza il rispetto delle norme.
Involucro e impianti, sistemi passivi e sistemi attivi: l’adeguamento energetico di un edificio è molto spesso il frutto di un corretto bilanciamento di più variabili. Non esiste una soluzione per tutte le situazioni, piuttosto una corretta scelta tra le molteplici tecniche disponibili, in funzione degli obiettivi da perseguire
Il tema dell’energia è un nodo fondamentale dei nostri tempi e lo sarà con tutta probabilità nei decenni a venire. Da un lato, la maggior consapevolezza di un necessario cambiamento di modello di sviluppo, rispetto a quello basato sulle fonti non rinnovabili che, in quanto tali, sono destinate ad aumentare il loro valore in maniera inversamente proporzionale alla loro diponibilità sul mercato, incrementando sempre di più i costi per gli utenti finali; dall’altro una differente sensibilità nei confronti delle tematiche ambientali, che ha determinato un avvicinamento generalizzato ai concetti di “energia pulita” e “sostenibilità”.
Matteo Cazzaniga
Questi due aspetti hanno pesantemente influenzato in tempi recenti il nostro modo di pensare comune, riflettendosi su tutti i settori della nostra economia, non da ultimo l’edilizia. L’industria delle costruzioni è uno dei settori produttivi più importanti da un punto di vista economico: l’indotto che ruota attorno ad essa in termini di materiali, attrezzature e


forza lavoro ha pochi pari. Un processo produttivo che si avvale di componenti semilavorati che consumano energia per essere creati e che ne consumano un’ulteriore quantità per essere assemblati o messi in opera in cantiere. Il suo prodotto inoltre (gli edifici, di qualsiasi destinazione d’uso) è esso stesso un’entità che, durante tutto il suo ciclo di vita utile, consuma energia e lo fa generalmente in maniera non costante: incrementando cioè i propri consumi con il passare degli anni, quando l’efficienza delle sue componenti tende a una naturale decrescita.
IL BINOMIO ENERGIA - COSTRUZIONI
È facile comprendere, quindi, come il tema dell’energia occupi un posto davvero rilevante quando si parla di costruzioni e sapere come e dove intervenire per ottimizzarne l’utilizzo è una capacità che fa la differenza in mercati così competitivi come il nostro. Se la riduzione dei consumi nel processo produttivo che porta alla realizzazione di un edificio è un obiettivo molto ambizioso, che coinvolge non solo il mondo delle costruzioni ma intere filiere manifatturiere (pensiamo al progetto “Cantiere Sostenibile” messo in campo da Ance), oggi ci concentreremo piuttosto su metodi e tecnologie finalizzate all’adeguamento e al contenimento energetico del prodotto finito: gli edifici. Quando si parla di energia in un edificio, prodotta o consu-
mata, o più genericamente di fabbisogno energetico di un edificio, ci si deve sostanzialmente focalizzare su due aspetti fondamentali: involucro e impianti.
INVOLUCRO
L’involucro è quell’insieme di elementi tecnologici che proteggono e definiscono da un punto di vista spaziale l’interno di un edificio dall’esterno e che, nel contempo, contribuiscono a creare le condizioni ideali di benessere abitativo in funzione delle condizioni climatiche che si verificano all’esterno (temperatura, rumore, vento). L’involucro è in pratica una sorta di barriera che si frappone tra lo spazio abitato e il mondo esterno.
IL RAGGIUNGIMENTO
DELLE IDEALI CONDIZIONI
DI COMFORT ABITATIVO
PASSA OGGIGIORNO
ATTRAVERSO UN’ATTENTA
ANALISI DEL FABBISOGNO
ENERGETICO DELL’EDIFICIO
NEL SUO INSIEME
Proprio il concetto di barriera ci porta a individuare l’involucro edilizio come quell’insieme di soluzioni passive che contribuiscono a contenere il fabbisogno energetico di un edificio.
In tal senso, tra le principali soluzioni adottate per l’adeguamento energetico di un edificio possiamo individuare: Isolamento a cappotto esterno: è la metodologia attualmente più utilizzata sia nelle nuove costruzioni, sia negli interventi di riqualificazione energetica di edifici esistenti. Prevede l’applicazione di un materiale isolante, generalmente sotto forma di pannelli rigidi, sulla faccia esterna della muratura perimetrale di un edificio. Il tutto viene poi completato con una doppia rasatura cementizia con interposta rete antifessurazione e in-

tonachino di finitura. I materiali isolanti più utilizzati sono l’Eps (polistirene espanso), la lana di roccia o la fibra di legno. Vantaggio principale del cappotto esterno è l’uniformità della coibentazione che viene applicata; particolare attenzione deve però essere riservata a eventuali fenomeni di condensa interstiziale nelle murature.
Isolamento a cappotto interno: laddove intervenire in facciata non sia consentito per motivi architettonici o di regolamentazione normativa, è possibile intervenire dall’interno. Il sistema a cappotto interno consiste nella placcatura del lato interno delle murature perimetrali con materiale isolante. In questi casi un fattore importante è anche la resistenza meccanica superficiale del pacchetto di isolamento, per questo la metodologia più utilizzata è quella delle contropareti coibentate (generalmente lana di roccia) con finitura in lastra di cartongesso.
Insufflaggio: applicazione di materiale coibente sfuso (fibra di vetro in fiocchi, poliuretano) nell’intercapedine di paramenti murari a doppia camera oppure sull’estradosso di solai di sottotetti non accessibili o comunque non abitabili.
Facciata ventilata: è una tecnica simile al cappotto esterno dove l’isolamento è sempre applicato al lato esterno della muratura perimetrale, ma viene poi nascosto da un rivestimento ancorato ad una sottostruttura metallica che crea un’intercapedine naturalmente ventilata tra isolamento e
rivestimento di facciata. Oltre alla grande libertà architettonico/compositiva, il rivestimento può essere scelto tra svariati materiali (ceramica, laterizio, alluminio): il vantaggio di questo sistema, benché abbastanza costoso, è di garantire un buon apporto in termini di contenimento energetico nel doppio ciclo invernale/estivo, proprio grazie alla ventilazione naturale.
Nel caso di nuove costruzioni, elevati livelli di contenimento energetico raggiunti grazie all’apporto dell’involucro edilizio possono essere raggiunti con la scelta di pacchetti murari particolarmente performanti (blocchi di calcestruzzo autoclavato, sistemi stratificati a secco, ecc.).
Allo stesso modo è opportuno non dimenticare come anche le coperture sono una parte fondamentale dell’involucro, siano esse piane o inclinate. Per le coperture in pendenza, la soluzione del tetto ventilato è sempre la più consigliabile: del tutto simile ad una facciata ventilata, fonda il proprio principio di funzionamento sull’intercapedine ventilata che si crea tra manto di copertura e pacchetto d’isolamento. In ogni caso, quando si parla di coperture, la scelta dell’isolante dev’essere sempre fatta con particolare attenzione al fattore irraggiamento solare, essendo le stesse molto esposte, e quindi al conseguente fenomeno dello sfasamento termico.
Gli impianti tecnologici sono quell’insieme di dispositivi che forniscono un apporto attivo nella creazione di un determinato comfort abitativo degli spazi interni. Se mediante l’involucro, infatti, in un certo senso definiamo volumetricamente uno spazio, delineandone il perimetro e quindi automaticamente determinandone una condizione climatica differente rispetto al mondo esterno, con gli impianti tecnologici interveniamo in maniera diretta nella termoregolazione degli ambienti abitati, arrivando a definirne i parametri fin nei minimi dettagli.
È evidente come involucro e impianti siano elementi tra di loro complementari, che non possono prescindere uno dall’altro: il corretto bilanciamento di queste due componenti è la chiave per il raggiungimento di un’efficienza energetica di buon livello a fronte di costi di costruzione e di gestione sostenibili.
Quando parliamo di impianti tecnologici in ambito di adeguamento energetico di un edificio, il primo pensiero corre automaticamente al riscaldamento degli ambienti nella stagione invernale. La tendenza più diffusa, un po’ come in altri settori produttivi, è l’elettrificazione dei processi: l’utilizzo di pompe di calore, in grado anche di gestire anche i cicli di climatizzazione estiva è ormai sempre più diffuso. Le maggiori limitazioni di questi sistemi sono date dallo scarso rendimento in presenza di temperature

molto rigide: proprio per questo, la soluzione più efficace è in molti casi rappresentata da generatori di calore ibridi, che uniscono la sostenibilità dell’elettrico all’immediatezza di risposta del gas metano. Fondamentalmente, quest’ultimo agisce principalmente da backup del sistema elettrico, nelle situazioni in cui l’efficienza delle prime tende a diminuire. Nelle nuove costruzioni, così come negli interventi sul costruito, la metodologia di riscaldamento maggiormente diffusa è del tipo a pavimento radiante: l’omogeneità del calore trasmesso e percepito è divenuta ormai insostituibile rispetto ai tradizionali radiatori puntuali. Talvolta si ricorre anche al ciclo inverso di raffrescamento, che però deve essere attentamente studiato, in particolar modo in riferimento alla gestione della deumidificazione degli ambienti. Al di là della tematica caldo/freddo, l’adeguamento energetico di un edificio passa sempre attraverso un’analisi energetica che metta in evidenza i punti critici e i fattori di miglioramento: il fine ultimo è sempre il contenimento dei consumi.
Non sorprende, quindi, la sempre maggior diffusione di
impianti fotovoltaici, anche per uso domestico. La grande differenza in questo senso potrebbero farla le Comunità Energetiche Rinnovabili. Nate sulla scorta delle direttive Ue in materia di sostenibilità energetica, si propongono come dei soggetti giuridici a cui fanno capo impianti delocalizzati in grado di produrre determinate quantità di energia elettrica che viene messa a diposizione per il fabbisogno locale. L’adesione, come privato cittadino o azienda, non presuppone la disponibilità diretta di un impianto ma consente l’affiliazione ai fini dell’utilizzo a tariffe agevolate di energia in surplus prodotta da altri impianti presenti nel territorio. Si tratta di un approccio diverso, che potrebbe influire anche sulle pratiche operative di adeguamento energetico di un edificio: l’utilizzo di energia prodotta da una Cer, infatti, non implica alcun allacciamento fisico o installazione di qualsivoglia dispositivo essendo, infatti, un’operazione di carattere amministrativo. La complementarità tra diverse tecnologie e soluzioni disponibili sul mercato è pertanto la migliore chiave per approcciare un processo di adeguamento energetico di un edificio, accettando la sfida per la sostenibilità che il mercato ci chiede sempre più insistentemente.

L’agenzia di rating americana Standard and Poor’s ha stimato gli oneri per il settore immobiliare dell’applicazione della direttiva europea che prevede il miglioramento della classe energetica degli edifici. Risultato: per i proprietari una media da 10 mila a 30 mila euro
La bella addormentata attende il risveglio. Per legge. Perché la direttiva europea Case green, che impone a tutti gli Stati europei di rendere meno energivori gli edifici, a partire da quelli residenziali, al momento è dormiente, ma è stata approvata in via definitiva e dovrà (o dovrebbe) essere risvegliata. Secondo quanto previsto dal provvedimento, ora sono i diversi governi che devono rendere operativa questa profonda trasformazione, che coinvolge migliaia di condomini. E, in attesa che l’attenzione del governo torni su questo grande argomento, c’è anche chi, come la società di rating Standard and Poor’s, ha calcolato quali saranno (o sarebbero per chi non è coinvolto) i costi per attenersi alle norme previste dalla direttiva.
CHE COSA PREVEDE
Riassumiamo: per il recepimento vero e proprio della direttiva l’Italia può aspettare il 2026. Mancano circa sei mesi. La direttiva, che tecnicamente è la Energy Performance of Buildings Directive o, in sintesi, Epbd,
ha concesso due anni ai Paesi membri per adeguarsi al testo. Uno è passato. L’anno prossimo l’Italia (come gli altri membri dell’Ue) dovrà presentare il proprio piano di rinnovamento degli edifici residenziali a Bruxelles. E, sempre nel 2026, darà il via al calendario di scadenze legate agli impianti solari. Va detto che il governo italiano è piuttosto riottoso a rispettare l’impegno assunto dal parlamento di Strasburgo, approvato anche con i voti dei deputati italiani, compresi quelli di una parte della maggioranza. Ma questo è un aspetto politico. Dal punto di vista tecnico, la direttiva Epbd indica che dal 2030 tutti gli edifici di nuova costruzione dovranno essere a zero emissioni, in base ai parametri tecnici fissati. Contemporaneamente, entrerà negli attestati di prestazione energetica il Gwp (Global warming potential), una misura del totale delle emissioni che un edificio genera in tutto il suo ciclo di esistenza. Sempre nel 2030 scatterà il primo target per il taglio di consumi medi degli edifici residenziali. E qui viene il bello: dovranno essere ridotti i consumi del 16% degli edifici, quelli più energivori. Per andare avanti fino al 2050, quando tutti gli edifici (sia quelli nuovi sia quelli esistenti) dovranno essere a emissioni zero e a basso consumo di energia. I condomini in classe G e F, insomma, entro il 2030 dovranno decidere opere come applicare un cappotto termico, cambiare cal -
daia, rifare il tetto: tutto quello che occorre per passare in una classe energetica meno sprecona.
Dato, però, che il governo ha detto chiaro e tondo che non se ne parla di ritornare al superbonus e che anche l’attuale sconto fiscale del 50% il prossimo anno sarà ridotto al 36%, per i proprietari di unità immobiliari si profila una bella stangata. Di quanto? Ovviamente il costo varia da un edificio all’altro. Ma, come accennato, l’ultimo report di S&P Global Ratings, dedicato al settore immobiliare residenziale europeo, ha cercato di stimare gli oneri della decarbonizzazione immobiliare. Per comprendere le reali esigenze e gli investimenti necessari, l’agenzia si è basata su un sondaggio a cui hanno partecipato 20 società immobiliari residenziali europee con rating e asset residenziali lordi per un valore superiore a 4 miliardi. E questo spiega anche perché a occuparsene è S&P, una società che si occupa del merito di credito di aziende, gruppi e Stati (una loro revisione al ribasso è temuta da tutti i governi e fa aumentare il famoso spread). Si tratta, insomma, di grandi società proprietarie di molti immobili, ai cui bilanci sono interessati banche e azionisti. E, proprio per questo, con strumenti a disposizione per calcolare l’impatto finanziario dei lavori.


Risultato: secondo l’analisi di Standard and Poor’s, per un appartamento di 80-100 metri quadrati, le ristrutturazioni finalizzate a soddisfare i requisiti normativi, in termini di efficienza, potrebbero costare ai proprietari da 10 mila a 30 mila euro per unità residenziale. Il report sottolinea l’ovvia considerazione che si tratta di medie variabili secondo le condizioni e l’ubicazione dell’immobile. Ma anche che per unità abitative particolarmente obsolete e inefficienti la cifra sale anche a 50 mila euro.
A questi costi potrebbero aggiungersi, su larga scala, l’adozione, in diversi Paesi europei, di tasse e prelievi nazionali sulle emissioni di carbonio, che andrebbero a pesare proprio sulle società immobiliari che amministrano altre società real estate, per l’aumento di costi operativi per il riscaldamento e l’elettricità. Anche se il riflesso immediato, per questo aspetto, riguarda le grandi società, è atteso anche per i condomini. Per esempio, con un aumento dei costi di gestione e dei canoni per chi è in affitto.
POSSIBILE RINVIO?
Ma ci sono anche altri calcoli da considerare. Secondo alcune valutazioni della Commissione europea, gli edifici esistenti dovrebbero essere ristrutturati a un tasso del 2-5% annuo per raggiungere gli obiettivi di decarbonizzazione a breve e lungo termine fissati. Secondo un’al -
tra stima, quella del centro studi di economia Bruegel di Bruxelles, per le ristrutturazioni degli edifici residenziali entro il 2030 la spesa aggiuntiva sarà complessivamente di 76 miliardi di euro all’anno.
Di questa somma sarebbero necessari circa 42 miliardi di euro per il 15% degli edifici peggiori. Certo, poi i proprietari di immobili beneficeranno di un risparmio consistente sulla bolletta di gas ed elettricità. Ma è inutile farsi illusioni: secondo S&P, potrebbero essere necessari dai 10 ai 25 anni per recuperare i soldi spesi per la ristrutturazione degli edifici.
Quindi i proprietari di immobili devono rassegnarsi a mettere mano al portafogli in nome della sostenibilità energetica? Anche se l’obiettivo di edifici meno energivori rimane indiscusso, non è detto che la direttiva Case green non faccia la fine di quella che riguarda il mercato automotive. L’aumento di spese previste per la difesa, di fronte alle tensioni belliche, la guerra dei dazi e un incerto destino dell’economia europea, potrebbero spingere la Commissione a rivedere le scadenze, concedendo una proroga, proprio come si profila per la transizione delle automobili verso l’elettrico. Non sarebbe sorprendente, insomma, anche perché è già previsto che nel 2028 i contenuti del testo della direttiva Casa green saranno sottoposti a revisione da parte della Commissione. Che nel frattempo è cambiata.





Solo 15 mm! 15 mm di Vacunanex® equivalgono a 140 mm di polistirolo/XPS




Nonostante la legge ne proibisca l’utilizzo, ci sono ancora
1,3 miliardi di metri quadrati di materiale nocivo sulle coperture delle abitazioni. Un problema sottovalutato, ma che i condomini devono risolvere Ne va della salute
Paolo Caliari
In Italia c’è un’emergenza, colpevolmente dimenticata, per centinaia di condomini. Eppure, c’è una legge da rispettare. Il problema è noto: secondo una valutazione del Cnr, restano ancora almeno 2,5 miliardi di metri quadrati di tetti realizzati con eternit. Cioè circa 32 milioni di tonnellate di cemento-amianto da smaltire. Di queste, ci sono «molte tonnellate di amianto friabile». Ma un’associazione no-profit, lo Sportello Amianto Nazionale, pensa che ce ne siano ancora di più: 40 milioni. La verità è che non esiste un censimento che dia numeri certificati. Secondo l’Istituto superiore per la prevenzione e la sicurezza del lavoro (Ispesl) ci sono da bonificare ancora circa 1,3 miliardi di metri quadrati di lastre di copertura in cemento-amianto sui tetti di edifici adibiti ad abitazione, in gran parte si tratta di condomini. Inoltre, non sono solo i tetti e i condotti il problema: alle coperture si aggiungono tra i 50 e i 100 milioni di metri quadrati di altre superfici rivestite con amianto spruzzato.
CHE COSA PREVEDE LA LEGGE
L’aspetto più sorprendente è che la bonifica di tutte le coperture che contengono amianto è stabilita da una legge del 1992. Secondo quanto deciso dal Parlamento, devono essere le Regioni a mettere a punto una mappatura dei tetti in eternitamianto. Risultato: nel nome dell’autonomia, ognuno è andato per la sua strada. Ci sono, quindi, Regioni che si sono date da fare, come Lombardia, Emilia-Romagna, Toscana, Umbria e Sardegna, e quelle che, invece, sono in ritardo di una trentina d’anni, come le Regioni meridionali, che non forniscono dati da quando in televisione regnava Pippo Baudo. Non solo: le Regioni hanno utilizzato nella raccolta dei dati criteri non omogenei e, di conseguenza, secondo il ministero dell’Ambiente moltissime aree di impianto particolarmente rilevanti in termini di necessità di intervento non rientrano tra i dati censiti. Magie del desiderio di indipendenza.
ATTENTI ALL’ACQUA
Come se non bastasse, c’è un ulteriore problema rilevato dall’Ona, l’Osservatorio nazionale amianto: la rete idrica che porta acqua nelle case. L’amianto non regna solo sui tetti, ma anche nelle tubature che portano l’acqua: su 500 mila chilometri di condotte, circa 300 mila (allacciamenti inclusi) mostrano la presenza di materiale con amianto. È un’infrastruttura vecchia, obsoleta, in gran parte realizzata prima dell’entrata in vigore della legge anti amianto. Tra l’altro, l’amianto in passato è stato utilizzato allegramente, prima che se ne conoscesse il lato oscuro cancerogeno e, qualche volta, paradossalmente è stato utilizzato anche per le strutture sanitarie. Ci sono 250 ospedali costruiti con amianto. Per non parlare delle scuole: sono 2.400 gli istituti scolastici che contengono amianto. Non ditelo ai 352 mila studenti, ai loro genitori e ai 50 mila membri del personale scolastico. Ma questa è un’altra storia.
L’amianto, insomma, è un pericolo dimenticato, ancora più colpevolmente visto che per l’edilizia si parla di sostenibilità, comfort e benessere. E la salute? Dovrebbe venire prima di tutto. Eppure, le tecniche per lo smaltimento dell’amianto sono collaudate, come l’incapsulamento e la vetrificazione, anche se gli esperti consigliano di ricorrere soprattutto alle discariche speciali. Il condominio che vuole intervenire per una bonifica, insomma, può contattare le imprese specializzate, che porteranno il materiale nocivo nelle apposite discariche: per fortuna, gli impianti ci sono. Se ne contano 19 con tutte le autorizzazioni del caso: nove si trovano al Nord (i più grandi), due al Centro e otto al Sud. In Lombardia sono quelle più efficienti e capienti, mentre altri centri di dismissione sono ormai saturi. Ne occorrerebbero quindi altri, anche perché per quelli ancora attivi la capacità è in costante diminuzione e non sufficiente a soddisfare il fabbisogno stimato.
Un problema riguarda l’aumento dei costi di smaltimento. Trasportare macerie costa e il prezzo del trasporto varia, ovviamente, con l’aumentare della distanza. Le stime attuali per lo smaltimento di amianto oscillano quindi dai 15 euro ai 25 per metro quadrato da portare in discarica. Premesso questo, non stupisce che Ispra nell’ultimo rapporto sulla produzione e gestione dei rifiuti speciali indichi che le quantità di rifiuti contenenti amianto generate dalle attività di smantellamento di manufatti contaminati siano scese in dieci anni dalle oltre 530 mila tonnellate del 2012 alle 385 mila nel 2020. Bastano due calcoli per comprendere la strada che ancora c’è da fare per una completa bonifica: a questo ritmo ci vorranno altri 103 anni. «La priorità deve essere la bonifica del Paese. È assurdo che a 33 anni dalla legge che lo ha messo al bando ci siano ancora 32 milioni di tonnellate di amianto, e che scuole e ospedali siano ancora luoghi dove ci si ammala», ha spiegato l’ex ministro dell’Ambiente, il generale dei carabinieri forestali Sergio Costa. «E questo nonostante i milioni di euro erogati per le bonifiche, nel 2020 quando ero ministro ne furono stanziati 385 milioni. Molto in questa fase è in capo alle regioni e ci sono disparità Nord-Sud da sanare. Inoltre, il tema urgente è il confinamento dell’amianto smaltito: l’unico sistema collaudato a oggi sono le discariche, iniquamente distribuite nel Paese oltre a essere quasi sature. Bisogna intervenire subito».
Vale la pena, in ogni caso, di fare un ripasso e ricordare che cosa è l’amianto e che cosa prevede la normativa. Secondo un documento della Camera dei deputati, «l’amianto è un minerale naturale a struttura fibrosa con buone proprietà fonoassorbenti e termoisolanti che, anche per via dell’economicità, è stato largamente utilizzato in passato in innumerevoli ap-


plicazioni industriali ed edilizie». Con il tempo, però, il materiale si è rivelato nocivo per la salute dell’uomo per la sua proprietà di rilasciare fibre che, se inalate, possono provocare patologie gravi ed irreversibili a carico dell’apparato respiratorio (asbestosi, carcinoma polmonare) e delle membrane sierose, principalmente la pleura (mesoteliomi). L’amianto è quindi sicuramente pericoloso soltanto quando può disperdere le sue fibre nell’ambiente circostante.
La legge 257 del 1992 e le principali norme emanate successivamente hanno riconosciuto la pericolosità dell’amianto e in attuazione di specifiche direttive comunitarie sono state dettate norme per la cessazione dell’impiego dell’amianto e per il suo smaltimento controllato. La legge stabilisce il divieto di estrazione, importazione, esportazione, commercializzazione e produzione di amianto. In attuazione, sono stati emanati numerosi provvedimenti per definire le modalità di predisposizione dei cosiddetti piani regionali amianto, di valutazione del rischio, di gestione dei manufatti contenenti questo minerale, nonché le tipologie di interventi per la bonifica. Per quanto concerne l’inquinamento ambientale, inoltre, con il decreto legislativo del 1995 sono stati fissati limiti per le emissioni in atmosfera e negli effluenti liquidi. In seguito, inoltre, sono state emanate nuove norme per lo smaltimento dell’amianto, nell’ambito della nuova disciplina delle discariche di rifiuti, nonché le regole per la mappatura e le bonifiche urgenti.
I PROVVEDIMENTI
Bisogna aggiungere che, a suo tempo, la politica aveva compreso l’urgenza e la rilevanza della bonifica dell’amianto. Tanto che per la mappatura completa della presenza di amianto sul territorio nazionale e per consentire la realizzazione degli interventi di bonifica urgenti, nel 2001 con una legge apposita il Parlamento ha stanziato 22 miliardi di lire per il triennio 2000-2002 (cioè circa 11,4 milioni di euro). Non molto per bonificare, ma probabilmente un buon con-
tributo per arrivare a una mappatura. Un successivo decreto ministeriale del 2003 ha definito i soggetti, gli strumenti e le fasi per la realizzazione della mappatura, affidando alle regioni e alle province autonome il compito.
Per facilitare il raggiungimento dell’obiettivo, è stata predisposta da Inail, in convenzione con il ministero dell’Ambiente, una Banca Dati Amianto in cui rientrano circa 108 mila siti interessati dalla presenza di amianto. Il ministero precisa, però, che la banca dati non consente ancora una copertura omogenea del territorio nazionale.
Nel 2013, inoltre, il Governo ha approvato il Piano nazionale amianto, che va in tre direzioni: tutela della salute, dell’ambiente e aspetti di sicurezza sul lavoro e previdenziali. Un po’ è rimasto sulla carta, un po’ il piano è andato avanti. Nel 2018 era stato introdotto il credito d’imposta «del 65% delle erogazioni liberali per interventi su edifici e terreni pubblici di bonifica ambientale, compresa la rimozione dell’amianto dagli edifici, prevenzione e risanamento del dissesto idrogeologico, realizzazione o ristrutturazione di parchi e aree verdi attrezzate e recupero di aree dismesse di proprietà pubblica». Incentivo che, poi, era rientrato anche nel pacchetto superbonus, ormai estinto. Ora però i bonus sono visti come fumo negli occhi dal ministro dell’Economia. E nel 2019 il Cipe (Comitato interministeriale per la programmazione economica) aveva approvato un cosiddetto addendum al provvedimento, nel quale è prevista tra l’altro l’attuazione di un Piano di bonifica da amianto negli edifici pubblici «finalizzato, in particolare, alla rimozione e allo smaltimento dello stesso negli edifici scolastici e ospedalieri», con una dotazione finanziaria di 385 milioni di euro, quelli citati dall’ex ministro Costa. E anche se negli interventi del Pnrr non sono previste misure specifiche a favore di interventi di bonifica di beni contaminati da amianto, nel Piano è compreso un investimento di 500 milioni da destinare alla bonifica dei siti orfani con l’obiettivo della loro riqualificazione. Meglio di niente.
Il 27 marzo del 1992 l’Italia, primo Paese in Europa, si è dotata di una legge che metteva al bando l’amianto. Sono trascorsi 33 anni, ma l’amianto è ancora un pericolo diffuso. L’allarme è nato con l’emergere del caso Eternit di Casale Monferrato, con il processo per l’imprenditore svizzero Stephan Schmidheiny che si è prolungato fino ai giorni nostri. Un altro caso è stato quello della Fibronit di Bari. In tutti e due i casi l’amianto utilizzato, non solo inconsapevolmente, ha provocato oltre 6 mila vittime, secondo i dati riportati dalla Camera in base al registro nazionale mesoteliomi. Sono le persone che ogni anno muoiono a causa di malattie asbestocorrelate, come il mesotelioma, il carcinoma polmonare e l’asbestosi provocate dal contatto con le microfibre di amianto.





L’isolamento a cappotto termico migliora l’efficienza energetica degli edifici, ma la sua realizzazione deve seguire rigorose regole tecniche per evitare difetti e danni. L’appaltatore ha l’obbligo di consegnare un’opera immune da vizi e difformità, garantendo la qualità del rivestimento

Irivestimenti posti sulla facciata sono uno strato esterno che viene applicato sugli edifici per proteggerli dagli agenti atmosferici e migliorarne l’aspetto estetico. Questi elementi svolgono un ruolo fondamentale nell’isolamento termico (ad esempio il cappotto termico, sistema di isolamento che permette di ottimizzare le prestazioni energetiche degli edifici) e acustico, contribuendo così al risparmio energetico e al comfort abitativo. I rivestimenti di facciata possono essere realizzati con molteplici materiali, ognuno con caratteristiche specifiche.
Nella realizzazione di questi elementi edili occorre procedere da parte dell’appaltatore con grande perizia e secondo le regole dell’arte. Il contratto di appalto, comunemente ricondotto nell’ambito della categoria dei contratti fonti di obbligazioni di risultato, determina il sorgere, in capo all’appaltatore, dell’obbligo di eseguire l’opera a esso commissionata, garantendo la realizzazione della stessa immune da vizi e difformità. In tal senso, infatti, depone il disposto dell’art. 1667 c.c., a mente del quale “l’appaltatore è tenuto alla garanzia per le difformità e i vizi dell’opera” sia l’art. 1669 c.c., secondo il quale “L'appaltatore è responsabile nei confronti del committente e dei suoi aventi causa”. Sul punto la giurisprudenza ha aperto alla possibilità, per il danneggiato, di chiedere il risarcimento del danno derivante dalle difformità e dai vizi dell’opera commissionata, nella forma dunque del c.d. risarcimento per equivalente. Ritiene in particolare la giurisprudenza di legittimità che “nel contratto di appalto il committente, che lamenti difformità o difetti dell’opera, può richiedere, a norma dell’art. 1668, primo comma, cod. civ., che le difformità o i difetti siano eliminati a spese dell’appaltare mediante condanna da eseguirsi nelle forme previste dall’art. 2931 cod. civ., oppure che il prezzo sia ridotto e, in aggiunta o in alternativa, che gli venga risarcito il danno derivante dalle difformità o dai vizi” (Cass.

n. 6181/2011). Applicando tale regola occorre evidenziare in primo luogo che la norma che viene in rilievo è principalmente quella di cui all’art. 1669 c.c. La norma in esame è ritenuta dalla giurisprudenza configurare un’ipotesi di responsabilità extracontrattuale, sancita per finalità di interesse generale, come quelle della stabilità, sicurezza e funzionalità degli edifici, e della incolumità personale dei cittadini (Cass. Civ., sent. n. 35931/2022; Cass. Civ., sent. n. 4319/2016; T. Milano 24.9.1990); inoltre introduce una presunzione iuris tantum di responsabilità, la quale può essere vinta dall’appaltatore con la prova dell’ascrivibilità del fatto al fortuito o all’opera di terzi (Cass. Civ., sent. n. 15488/2000).
DIFETTI E SOLUZIONI PER IL RIPRISTINO
La giurisprudenza di legittimità è pacifica nell’affermare che i “gravi difetti” della costruzione non si identificano con quei fenomeni che influiscono sulla stabilità dell’edificio, poiché, in tal caso, finirebbero con l’identificarsi con l’ipotesi del “pericolo di rovina”; possono invece consistere in tutte quelle alterazioni che, pur riguardando direttamente anche solo una parte dell’opera, incidono sulla sua funzionalità globale, menomandone in modo apprezzabile il godimento, sì da renderla inidonea a fornire l’utilità cui è destinata. E ciò indipendentemente dalla somma di denaro necessaria per la loro eliminazione (Cass. Civ., sent. n. 3752/2007): può dun-
que trattarsi di lesioni alle strutture, di imperfezioni o di difformità tali da diminuire sensibilmente il valore economico dell’edificio nel suo complesso, o di singole sue parti, senza che debba sussistere anche il pericolo di un crollo immediato (Cass. Civ., sent. n. 2977/1998), ovvero di alterazioni che attengano a quegli elementi, accessori o secondari, che consentono però l’impiego duraturo cui l’opera è destinata, (Cass. Civ., sent. n. 11740/2003), quali, ad esempio, le condutture di adduzione idrica, i rivestimenti, l’impianto di riscaldamento, la canna fumaria (Cass. Civ., sent. n. 11740/2003).
Analizzando, più nello specifico, la giurisprudenza sul punto, emerge come siano numerose le fattispecie nelle quali sono stati ravvisati i gravi difetti. Tra di esse il distacco di una notevole parte dell’intonaco esterno del fabbricato (Cass. Civ., sent. n. 10624/1996). A tal proposito giova ricordare un caso recente di una sentenza del Tribunale di Spoleto n 610/2024, laddove la relazione peritale agli atti conferma la sussistenza dei vizi lamentati. Si legge infatti nel suddetto elaborato che: “i fenomeni esterni all’unità immobiliare e presenti nelle facciate possono riassumersi in cavillature e fessurazioni all’intonaco-rasatura del cappotto termico di facciata, presenti in corrispondenza di aperture (soglie e architravi di porte e finestre) e lungo tutta la trama dei pannelli e delle tassellature sottostanti all’intonaco-rasatura stesso. Tale fenomeno è presente su tutte e tre le facciate interessate dall’unità im-
mobiliare. Per questo, è stato accertato che i suddetti vizi e difetti incidono sulla fruibilità e funzionalità dell’immobile nel seguente modo: “Esternamente all’unità immobiliare, le cavillature, fessurazioni e crepe, presenti negli intonaci rasature dei rivestimenti di facciata, inibiscono il venir meno della funzione impermeabilizzante dell’intonaco, costituendo punti d’ingresso per eventuali infiltrazioni d’acqua. Esternamente all’unità immobiliare, i vizi relativi al rivestimento termico del cappotto di facciata e al timpano di copertura potrebbero incidere sulla funzionalità isolante e certificata in “classe energetica A”. Internamente all’unità immobiliare, si sono riscontrate la presenza di efflorescenze con macchie ed è stato accertato che la causa dei suddetti vizi è ascrivibile all’opera realizzata dalla ditta appaltatrice. In particolare:
• per eliminare l’insorgenza di umidità all’interno dell’abitazione, si dovrà realizzare correttamente l’impermeabilizzazione del giunto di attacco a terra parete-marciapiede, eseguendo l’impermeabilizzazione dietro al cappotto, anziché davanti;
• per eliminare l’insorgenza di cavillature e fessurazioni agli intonaci-rasature dei cappotti, si dovrà, una volta rimosso tutto il rivestimento, analizzare la corretta applicazione del collante e della schiuma su tutti i pannelli;
• verificare poi, lo stato e la corretta realizzazione del supporto e intervenire con la tipologia di intervento, che in fase di verifica si riterrà più idonea;

• Protezione dagli agenti atmosferici e risparmio energetico
• Obblighi contrattuali dell’appaltatore per difetti e difformità
• Responsabilità extracontrattuale per difetti gravi
• Possibili richieste di risarcimento per danni riscontrati
• Un’errata posa può causare cavillature, infiltrazioni e perdita di funzionalità. La giurisprudenza tutela il committente, prevedendo rimedi come la riparazione a spese dell’appaltatore o il risarcimento per il danno subito
• per eliminare la presenza di cavillature e fessurazioni agli intonaci-rasature dei pannelli in cemento rinforzato del “timpano” di copertura, si dovrà, non essendo in possesso di dettagli esecutivi, rimuovere tutto il rivestimento, verificare la tipologia costruttiva di realizzazione dello stesso, ed intervenire con la tipologia di intervento che in fase di verifica si riterrà più idonea.
Il costo totale di realizzazione degli interventi descritti è stato quantificato in una spesa variabile tra € 62.215,50 ed € 64.715,50 (iva e oneri di cassa esclusi) a carico della dell'appaltatore.
In un caso analogo presso il Tribunale di Lodi (sentenza n. 450/2020) il consulente tecnico ha attribuito la causa delle efflorescenze diffuse sulle parteti degli edifici “da un lato alla trasudazione delle murature umide (probabilmente i pannelli sono stati fissati sulla muratura esterna ancora umida), dall’altro dalla mancanza della finitura superficiale a spessore del tipo “colorata”, la quale per sua stessa definizione e composizione è antimuffa ed è la finitura necessaria a garantire la durabilità del sistema cappotto”. Ciò premesso, i vizi riscontrati devono essere imputati alla ditta per non aver eseguito a regola d’arte. Come noto, in tema di contratto di appalto, l’appaltatore è tenuto a realizzare l’opera a regola d’arte, osservando nell’esecuzione della prestazione la diligenza qualificata ai sensi dell’art. 1176 co. 2 c.p.c. quale modello astratto di condotta che si estrinseca nell’adeguato sforzo tecnico, con impiego delle energie e dei mezzi normalmente e obiettivamente necessari o utili, in relazione alla natura dell’attività esercitata, volto all’adempimento della prestazione dovuta, al soddisfacimento dell’interesse creditorio nonché ad evitare possibili eventi dannosi. In ragione della specifica natura e della peculiarità dell’attività esercitata, l’appaltatore è quindi tenuto a comportarsi di-

ligentemente, adottando le misure e le cautele necessarie e idonee per eseguire la prestazione, secondo il modello di precisione e di abilità tecnica nel caso concreto richiesto idoneo a soddisfare l’interesse creditorio. La prestazione dovuta dall’appaltatore implica, difatti, senza necessità di una specifica pattuizione, pure il controllo e la correzione degli eventuali errori del progetto (così Cass. Sent. n. 6754/2003 secondo la quale “l’appaltatore è tenuto non solo ad eseguire a regola d’arte il progetto, ma anche a controllare, con la diligenza richiesta dal caso concreto e nei limiti delle cognizioni tecniche da lui esigibili, la congruità e la completezza del progetto stesso e della direzione dei lavori, segnalando al committente, anche nel caso di ingerenza di costui, gli eventuali errori riscontrati, quando l’errore progettuale consiste nella mancata previsione di accorgimenti e componenti necessari per rendere il prodotto tecnicamente valido e idoneo a soddisfare le esigenze del committente”). L’appaltatore va invece esente da responsabilità laddove dimostri di aver manifestato il proprio dissenso e di essere stato indotto a eseguire il progetto come “nudus minister” per le insistenze del committente a rischio del medesimo. La ditta appaltatrice, in mancanza di prova in tal senso, veniva quindi condannata a risarcire i danni patiti pari al costo delle opere necessarie per l’eliminazione dei vizi quantificati in complessivi € 119.700,00.

PROVE DI TENUTA NON DISTRUTTIVE SU SERBATOI E VASCHE INTERRATE
• Bonifica risanamento dismissione serbatoi
Iscrizione Albo Nazionale Gestori Ambientali TO 01399
• Controllo spessore e taratura serbatoi
• Indagini ambientali
• Sicurezza sul lavoro

PROVE ESEGUIBILI SU SERBATOI IN ESERCIZIO A QUALSIASI
LIVELLO DI RIEMPIMENTO
I controlli non richiedono lo svuotamento o la bonifica e non prevedono l’utilizzo di pressione all’interno evitando rotture o cedimenti preservando l’integrità strutturale delle lamiere.
RISULTATI DOCUMENTABILI CON QUANTIFICAZIONE DEL RATEO DI PERDITA
I dati registrati sono inalterabili e consentono di rilevare minime perdite secondo quanto previsto dalle linee guida ARPA.
TECNICI QUALIFICATI PER OPERARE IN SICUREZZA Personale qualificato, formato e informato sui rischi specifici i per operare su serbatoi contenenti prodotti chimici e petrolchimici.
TECNOLOGIE SICURE E COMPUTERIZZATE
Metodi di prova valutati e riconosciuti UNICHIM previsti nel Manuale n.195 Ed. 2000/2003.
Il cappotto termico migliora il comfort abitativo, ma può subire danni nel tempo. Errori di posa, eventi atmosferici e usura ne influenzano l’efficacia. Vengono in soccorso soluzioni innovative per il recupero e la manutenzione, con sistemi certificati, senza rimozione del cappotto

Il cappotto termico dell’edificio, per brevità “cappotto” o “Etics” (External Thermal Insulation Composite System), è quel sistema di elementi applicati all’esterno delle chiusure verticali (e sub-orizzontali rivolte verso il basso) opache degli edifici capace di migliorare il comfort abitativo degli ambienti, riducendo la dispersione di calore verso l’esterno durante il periodo invernale e, conseguentemente, la trasmissione del calore verso l’interno nel periodo estivo. Le problematiche a cui il cappotto nel corso della sua vita può andare incontro sono: danni derivati da errori di posa, danni derivati da eventi esterni o degrado dovuto alla naturale usura generata dalle condizioni atmosferiche e dal succedersi delle stagioni.
MANUTENZIONE E RISPRISTINO
I possibili interventi di recupero e manutenzione da operare sui sistemi a cappotto sono i seguenti:
• pitturazione con nuova pittura silossanica a elevata idrorepellenza e resistente ad alghe, funghi e muffe;
• rifacimento di nuovo strato decorativo mediante applicazione di rivestimento colorato compatibile sulla finitura colorata esistente;
• realizzazione di nuovo strato di rasatura armata e applicazione di nuovo rivestimento colorato;
• realizzazione di nuovo sistema Etics mediante raddoppio del cappotto o posa di webertherm robusto universal in sovrapposizione al cappotto esistente;
• realizzazione del sistema webertherm renovETICS in sovrapposizione al cappotto esistente;
• realizzazione di nuovo sistema Etics previa rimozione del cappotto esistente.
TIPOLOGIE DI DANNO
Sulla base delle analisi dello stato del sistema d’isolamento a cappotto è possibile rilevare eventuali danni più o meno gravi. L’evoluzione di questi aspetti può dare origine a danni estetici o funzionali del sistema d’isolamento a cappotto che, in base all’entità, possono essere distinti in:
• degrado estetico, dovuto a muffe scolorimento e microcavillature;



In questa foto e a sinistra, problematiche che possono insorgere col passare del tempo.
• danni di lieve entità, dovuti a scarsa planarità della superficie, cavillature superiori a 0,2 mm, evidenza della pannellatura in facciata;
• danni di media entità, dovuti a distacchi della rasatura, rigonfiamenti, fessurazioni e crepe con ampiezza superiore a 1 mm;
• danni di grave entità, dovuti a impatti da grandine e urti accidentali, lesioni maggiori o crepe con ampiezza superiore a 2 mm, distacchi dei pannelli, gravi errori di posa in opera o progettazione.
Saint-Gobain Italia fornisce la soluzione più adatta a tutti i danni del sistema di isolamento a cappotto, dal deteriora-
Due i sistemi ideati da Saint-Gobain per ripristinare difetti e danni di grave entità senza la rimozione del cappotto:
• webertherm renovETICS into: sistema che conferisce alle superfici sulle quali è applicato tutta la robustezza, la resistenza e la solidità tipiche delle facciate intonacate in modo tradizionale grazie all’applicazione di intonaco fibrato e idrofugato webertherm into e rasante webertherm into finitura. Inoltre, supera anche i vincoli decorativi dei sistemi standard, come ad esempio l’utilizzo esclusivo di rivestimenti colorati a spessore a base sintetica.
• webertherm renovETICS light: sistema con intonaco termoisolante alleggerito con microsfere di Eps webertherm x-light042 e rasante webertherm AP60 TOP.
mento di tipo estetico fino a quelli più gravi, dovuti ad esempio a impatti da grandine e urti accidentali, lesioni maggiori o crepe, distacchi dei pannelli, gravi errori di posa in opera o progettazione.
Per i problemi più gravi il ciclo di riparazione risolutivo prevede l’applicazione di webertherm renovETICS, un sistema senza rimozione del cappotto, certificato e assicurabile. Il sistema webertherm renovETICS supera i vincoli decorativi dei sistemi standard (ad esempio, l’uso solo di rivestimenti colorati a spessore a base sintetica) e conferisce alle facciate la robustezza, la resistenza e la solidità tipiche delle facciate intonacate in modo tradizionale.
BRIANZA PLASTICA
Il Condominio Cimarosa a Buccinasco (Mi) ha risolto i problemi del vecchio involucro adottando il sistema termoisolante Isotec Parete applicato senza rimozione del rivestimento esistente. Una soluzione versatile e sostenibile che ha elevato comfort abitativo e classe energetica
Rebecca Alberti
Il grande complesso condominiale Cimarosa a Buccinasco, costituito da tre corpi di fabbrica di diverse altezze, ha affrontato importanti problematiche legate al degrado delle facciate e alla sicurezza del rivestimento esterno, che nel tempo aveva mostrato episodi di distacco. Pur essendo stato oggetto di una prima ristrutturazione tra il 2014 e il 2015, il problema del distacco si è ripresentato a distanza di poco tempo. Un’indagine tecnica effettuata tramite prove a strappo a campione ha messo in evidenza più profonde criticità, facendo supporre che la causa fosse riconducibile a possibili movimenti differenziali della struttura portante in cemento armato, aggravati dalle dilatazioni termiche stagionali dei materiali, che compromettevano l’ade -

sione del rivestimento esterno, richiedendo la messa in sicurezza delle facciate con protezioni provvisorie. Per risolvere definitivamente il problema dell’aderenza delle piastrelle, i progettisti hanno scelto di adottare la soluzione di facciata ventilata realizzata con il Sistema Isotec Parete, capace di migliorare l’isolamento e offrire un supporto sicuro e stabile per il nuovo rivestimento in lastre di grès 60x120 cm, preservando l’identità architettonica originale con una rilettura in chiave moderna.
CRITICITÀ DELL’INVOLUCRO EDILIZIO
Il condominio, costruito secondo schemi tipici dell’edilizia economico-popolare e gravato da un basso livello di comfort abitativo dovuto a un isolamento termico non adeguato al clima continentale della pianura padana, presentava inoltre diffusi ammaloramenti delle facciate, evidenziati da disomogeneità cromatiche e segni lasciati dall’umidità.
SOLUZIONE
L’impiego del sistema Isotec Parete ha permesso, con un’unica soluzione e un solo passaggio di posa a secco, sia il miglioramento energetico dell’involucro che la risoluzione delle problematiche di isolamento termico e di stabilità del rivestimento esterno, conferendo una rinnovata eleganza alle facciate. Isotec Parete di Brianza Plastica è un sistema termoisolante composito, costituito da un pannello in poliuretano espanso rigido, rivestito con una lamina di alluminio su entrambe le facce e dotato di un correntino metallico asolato preassemblato in fabbrica. I pannelli sono stati fissati, previ test di resistenza allo strappo effettuati in cantiere, direttamente
«Il Sistema Isotec Parete è un grande alleato delle imprese di costruzione perché è veloce e soprattutto intuitivo da posare, a prova di errore, anche da parte di applicatori che non abbiano mai avuto esperienza con questo prodotto. La sua natura di sistema completo consente di realizzare con un solo passaggio di posa sia l’isolamento che la sottostruttura metallica per agganciare il rivestimento, ottimizzando notevolmente i tempi e la gestione del cantiere».

sul supporto esistente, senza necessità di smantellare il vecchio rivestimento in piastrelline ceramiche di piccole dimensioni, aspetto che ha permesso di contenere i tempi di lavorazione e le spese di smaltimento, rendendo i costi dell’intervento paragonabili a un cappotto tradizionale, ma con prestazioni superiori. Le lastre in grès di grande formato 60x120 cm, scelte nel colore sabbia naturale, sono state fissate meccanicamente ai correntini metallici di Isotec Parete mediante staffe, con morsetti a vista in tinta, eliminando così definitivamente il rischio di distacchi accidentali. Il progetto di ristrutturazione ha




tenuto fede all’intento estetico originario, che prevedeva il basamento in tonalità grigia, i corpi scala e gli ascensori in verde e le facciate e le logge in sabbia, recuperando i caratteri preesistenti del complesso abitativo e del contesto costruito.
ISOLAMENTO TERMICO
E COMFORT ABITATIVO
Grazie ai pannelli Isotec Parete con anima in poliuretano espanso rigido a celle chiuse di spessore 120 mm e densità 38 kg/m³, l’edificio ha beneficiato di una significativa riduzione delle dispersioni di calore in inverno e di un efficace attenuamento dell’irraggiamento solare estivo. La continuità del sistema evita la formazione di ponti termici, migliorando l’efficienza energetica complessiva dell’involucro. All’interno della camera d’aria che si crea tra l’isolante e il rivestimento in grès, si attiva in maniera naturale un effetto camino che favorisce il deflusso del calore in estate e dell’umidità in inverno, agevolando l’azione dell’isolante.
SISTEMA VERSATILE
PER RIQUALIFICARE
Il sistema Isotec Parete è stato studiato per offrire massima versatilità e facilità di installazione, essendo compatibile con tutte le tipologie di supporto e di finitura esterna. La sua doppia valenza di isolante termico e sottostruttura per la facciata ventilata lo rendono una soluzione ideale per interventi su edifici esistenti, in quanto permette di: riqualificare energeticamente l’edificio con

Stratigrafia della facciata ventilata con Isotec Parete



In questa pagina, dettagli del nuovo rivestimento in gres
performance elevate grazie alle caratteristiche del poliuretano di cui è composto, migliorare l’estetica della facciata con un sistema affidabile e versatile, senza porre limiti alle scelte dei progettisti in materia di rivestimenti, consentendo di risparmiare, ottimizzando i tempi e la logistica di cantiere. In questo cantiere dalle estese superfici di facciata di circa 7.000 mq, il sistema Isotec Parete è stato posato per lo più in verticale, con alcune aree in cui, per la geometria della parete, è stata preferita la posa in orizzontale. Il sistema ha dato prova anche in questa realizzazione delle sue doti di semplicità di installazione.
Grazie alla sua facilità di posa, versatilità e prestazioni elevate, il sistema Isotec Parete si conferma una scelta vincente per la riqualificazione degli edifici, combinando innovazione, efficienza energetica e sostenibilità ambientale. In questo intervento, l’installazione del sistema isolante di facciata ventilata, contestualmente agli altri interventi effettuati sull’involucro, ha fruttato il miglioramento dall’iniziale Classe energetica E alla Classe post-intervento A1.
• Intervento: efficientamento energetico ed estetico delle facciate
• Tipologia: condominio - residenziale
• Ubicazione: Buccinasco (Milano)
• Progettazione architettonica: arch. Marco Papagna, Milano; arch. Oriano Valli, Borgo Maggiore (Rsm)
• Strutture e progettazione esecutiva facciate ventilate: ing. Enzo Montini, Polaveno (Bs)
• Isolamento facciata ventilata: Isotec Parete, spessore 120 mm, passo 600 mm
• Rivestimento facciata: lastre in grès color sabbia
• Superficie isolata: 7.000 m2
• Durata lavori: dicembre 2021 – dicembre 2023
• Prestazione energetica: trasmittanza media parete 0,15 W/m2 K con passaggio da Classe E a Classe A1
• Agevolazioni fiscali: Superbonus 110%
Il deterioramento del calcestruzzo è un problema diffuso, specialmente nei condomini e nelle strutture esposte agli agenti atmosferici. Tecniche avanzate ottimizzano la protezione dell’armatura metallica e garantiscono una maggiore resistenza meccanica

Nel mondo dell’edilizia residenziale, l’uso del calcestruzzo armato è una delle tecniche costruttive più utilizzate, dal boom economico degli anni ‘60 fino a oggi. Questa diffusione fa sì che non sia raro trovare condomini con chiari segni di deterioramento del calcestruzzo, soprattutto nelle zone più esposte agli agenti atmosferici, come terrazzi e balconi. Può trattarsi di una gamma di problemi molto varia, da episodi “minori” ma rivelatori, come l’alterazione di colore del calcestruzzo che segnala la presenza di alghe o muffe, al distacco di piccole porzioni di calcestruzzo, fino all’esposizione dei ferri di armatura corrosi. A peggiorare la situazione le dimensioni delle strutture e la difficoltà del processo decisionale nei complessi residenziali, che spesso costringono ad attendere lunghi periodi prima di poter intervenire, col risultato di aggravare ulteriormente i danni.
Nel ripristino del calcestruzzo è importante intervenire con prodotti compatibili, per garantire una soluzione efficace ma al tempo stesso duratura. Fassa Bortolo non offre solo i prodotti, ma il supporto della sua Assistenza Tecnica, anche direttamente in cantiere, per scegliere la giusta strategia di intervento. Per farlo, utilizza diversi tipi di test, come le prove ultrasoniche o prove meccaniche su campioni di materiali, ottenuti più rapidamente grazie al proprio laboratorio interno. L’obiettivo è prima di tutto capire come intervenire, e valutare anche come proteggere le superfici con le giuste soluzioni di finitura.
È soprattutto per queste situazioni che Fassa ha creato due nuovi prodotti della sua linea Geoactive, dedicata al ripristino del calcestruzzo ammalorato: Geoactive R4 10 e Geoactive R4 40 . Si tratta di due nuove malte rapide, particolarmente indicate per interventi localizzati di ripristino strutturale del calcestruzzo, in situazioni in cui sono necessarie una presa rapida ed elevate prestazioni meccaniche: hanno infatti un tempo di lavorabilità stabile di 10 minuti o 40 minuti, come indicato dal nome, e consentono di cominciare il ciclo di finitura dopo 4 ore dall’intervento.
Il Centro Ricerche Fassa I-Lab ha lavorato in modo particolare alla lavorabilità del prodotto, per rispondere alle esigenze di performance in diverse condizioni ambientali e per soddisfare le molteplici necessità di intervento, anche quelle più estreme dell’edilizia acrobatica. Grazie alla presenza in formulazione di polimeri ridisperdibili in polvere, infatti, queste nuove malte hanno una migliore adesione al supporto, riducendo la necessità di “bagnarlo a rifiuto”, semplificando dunque la fase di preparazione. Si tratta di un vantaggio significativo in cantieri dove l’umidificazione del supporto è disagevole, e dove risulta quindi più facile, oltre che notevolmente meno costoso, intervenire rapidamente con un sollevatore a cestello per risolvere i problemi.
Geoactive R4 10 e Geoactive R4 40 sono pensati, ad esempio, per la riparazione rapida di elementi strutturali in calcestruzzo armato quali travi e pilastri, di cornicioni e frontalini di balconi anche in situazioni di urgenza, di elementi prefabbricati in calcestruzzo. Inoltre, servono a

PASSIVARE
ossia migliorare la protezione dell'armatura metallica RIPARARE il calcestruzzo ammalorato
RIFINIRE
con prodotti a grana fine facilmente frattazzabili a civile e pronti per la decorazione
PROTEGGERE in modo duraturo

Riparazione rapida di elemento strutturale con le malte G eoactive R4 10 e G eoactive R4 40
regolarizzare aree di calcestruzzo con difetti superficiali come nidi di ghiaia, fori dei distanziatori, riprese di getto. Non si tratta di solo di prestazioni estetiche: questi prodotti rispondono infatti al requisito R4 (strutturale), fornendo alte performance meccaniche e di resistenza a compressione. Inoltre, contenendo speciali modificatori polimerici all’interno della loro formulazione, sono testate in particolari e specifiche condizioni di stagionatura ( Pcc ), sia in strutture esposte all’aria che costantemente sott’acqua.
In Italia, con 1 milione di impianti, gli ascensori giocano un ruolo chiave nella mobilità urbana e nell’abbattimento delle barriere architettoniche. Le moderne installazioni garantiscono efficienza energetica, sicurezza e maggiore accessibilità
L’a scensore è probabilmente il mezzo di trasporto più utilizzato al mondo. Si stimano, infatti, circa 1 miliardo di utilizzatori all’anno, per un totale di circa 12 milioni di impianti installati a livello mondiale. L’Italia, con il suo milione di impianti installati, rappresenta quindi un dodicesimo dell’intero patrimonio ascensoristico mondiale, posizionandosi al secondo posto in termini assoluti, subito dopo la Cina, che l’ha superata da pochi anni. L’ascensore svolge un ruolo fondamentale, soprattutto nella realtà italiana. Negli ultimi anni, è cresciuta l’importanza del suo ruolo sociale, essendo un elemento che contribuisce all’abbattimento delle barriere architettoniche e garantisce maggiore equità per molte persone: anziani, disabili o anche chiunque torni a casa con borse della spesa o casse d’acqua. Diventa quindi un simbolo di libertà di movimento, comfort abitativo, autonomia e uguaglianza. Le recenti agevolazioni fiscali hanno offerto l’opportunità di installare ascensori in edifici esistenti, in conformità con
la legge 13 del 1989, permettendo di superare le barriere architettoniche rappresentate dalle rampe di scale. Questa possibilità si confronta però con la necessità, da parte delle aziende ascensoristiche, di offrire al cliente un servizio “chiavi in mano”, garantendo un’installazione personalizzata sul fabbricato esistente, nel rispetto delle sue peculiarità, come balconi, tetti, grondaie, percorsi di cavi elettrici o idraulici. Tutte queste condizioni richiedono elevata professionalità e competenze specifiche. Un aspetto importante è la corretta valutazione delle attività di cantiere negli edifici abitati, ad esempio nel caso di applicazione del cappotto termico e installazione dell’ascensore. Questi interventi richiedono una programmazione attenta, finalizzata a limitare i rischi interferenziali derivanti dalla simultaneità di lavorazioni, che potrebbero compromettere la sicurezza di lavoratori e inquilini. Il vantaggio del servizio “chiavi in mano” è permettere al cliente di interfacciarsi con un unico fornitore, semplificando la gestione dell’intera fornitura e assicurando il controllo totale del cantiere da parte dell’azienda ascensoristica.
TIPOLOGIE DI INSTALLAZIONE
Quando si decide di installare un ascensore in un edificio privo di tale impianto, è normale porsi domande sui per-


messi necessari e sulle caratteristiche tecniche da adottare.
L’installazione può essere suddivisa in due principali configurazioni:
• interna, dove l’ascensore viene integrato all’interno della struttura dell’edificio;
• esterna, dove l’ascensore viene posizionato adiacente alle pareti e sostenuto da una struttura metallica che funge da vano corsa.
Per quanto riguarda la tecnologia di movimentazione, l’ascensore può funzionare con:
• argano elettrico, installato nel vano corsa, che offre all’utente una velocità normalmente di 1 m/sec, consumi ridotti ed è più ecologico;
• sistema idraulico, che utilizza un pistone ad olio con una velocità inferiore (generalmente 0,60 m/sec), richiede un locale tecnico per la centralina e necessita di uno smaltimento corretto dell’olio, essendo una sostanza inquinante.
Un ascensore esterno comporta minori interventi edilizi, poiché la struttura viene addossata alla parete, garan -
tendo tempi di installazione più brevi rispetto a quello interno, che può richiedere importanti opere murarie, come il taglio delle scale.
SICUREZZA E MANUTENZIONE
Dopo aver installato un ascensore, è fondamentale definire un piano di sicurezza e manutenzione dell’impianto. La normativa stabilisce l’obbligo di eseguire controlli regolari per garantirne il funzionamento ottimale:
• verifiche obbligatorie: devono essere eseguite ogni 2 anni da tecnici specializzati e autorizzati;
• manutenzione ordinaria: affidata al proprietario dell’edificio o all’amministratore di condominio, che stipula un contratto con una ditta specializzata.
L’ascensore è quindi un mezzo di trasporto che può migliorare la qualità della vita e diventare un elemento di inclusione. La sua installazione in edifici esistenti aumenta il valore immobiliare, riqualifica i piani alti, rendendoli più accessibili e funzionali. Cosa sarebbe New York senza ascensori e, quindi, senza grattacieli?
La residenza Al Vigneto è composta da cinque palazzine, realizzate tra il 2020 e il 2024, rivestite in facciata con pannelli Hpl. Prodotti da BF, i pannelli sono durevoli, resistenti agli agenti atmosferici e mantengono inalterati nel tempo colore e prestazioni
BF nasce dall’esigenza della committenza di poter fare riferimento a un unico partner per la realizzazione di rivestimenti per facciate ventilate e balconi. Da 25 anni l’azienda gestisce i lavori, dal progetto al cantiere, attraverso il proprio ufficio tecnico che dialoga con i progettisti e i clienti e un reparto per la lavorazione dei pannelli in grado di personalizzare ogni progetto prestando grande attenzione al dettaglio architettonico.
PROGETTO, PRODUZIONE E POSA A REGOLA D’ARTE
Il cuore dell’azienda è la rete di professionisti di grande esperienza di cui si avvale. Nel 2013 da un’iniziativa di BF nasce Apox, un consorzio di artigiani certificati per

la posa in opera a regola d’arte. Un’ulteriore garanzia di serietà e perfezione per tutto quello che riguarda l’intervento sull’esterno degli edifici.
Gli artigiani che entrano a far parte di Apox vengono selezionati per abilità tecniche e qualità del servizio, che comprende la continuità e la puntualità nella consegna dei lavori. Si tratta di un sistema di controllo e garanzia che s’inserisce nella più ampia gestione di BF, per la realizzazione di progetti aderenti alle richieste della committenza. Lo studio tecnico e la sinergia tra progettisti e artigiani consente la creazione di facciate dall’alto valore funzionale, che aumenta l’efficienza energetica dell’edificio, l’isolamento termico e acustico, evita l’accumulo di umidità e il deterioramento delle murature.
Ideate per migliorare le prestazioni di isolamento termico ed energetico di un edificio, le facciate ventilate si stanno affermando sempre di più in architettura e in edilizia anche per questioni legate all’uso di materiali innovativi ed ecosostenibili, alla protezione e al mantenimento di murature e isolamento esistenti, così come alla libertà creativa e progettuale.
La facciata ventilata è un rivestimento che si applica sulla superficie esterna dell’edificio, coprendola con pannelli che non aderiscono direttamente alle pareti, ma si distanziano da queste per mezzo di sottostrutture in alluminio
o in legno. L’intercapedine che si viene a creare tra la parete e il rivestimento esterno della facciata innesca, per effetto camino, la circolazione dell’aria e la massima efficienza dell’edificio. Inoltre, lo stato di ventilazione unito al materiale isolante permette di ridurre la dispersione di calore in inverno ed evitarne l ’ accumulo in estate. La facciata ventilata crea un flusso d ’ aria in movimento fra lastra esterna e pannello isolante che permette all ’ aria surriscaldata che si forma nella camera di ventialzione di essere espulsa dalla sommità dell ’ edificio diminuendo gli apporti termici dall ’ esterno. Nel periodo invernale invece questa ventilazione favorisce la rapida eliminazione del vapore acqueo proveniente dall ’ interno. In questo modo vengono drasticamente eliminati gli effetti negativi di eventuali penetrazioni di acqua con conseguente riduzione della quantità di calore che esce dall ’ edificio. Oltre alla capacità di proteggere le strutture da umidità, agenti atmosferici estremi e sbalzi termici, la facciata ventilata si presta alla sperimentazione in campo creativo: non intervenendo direttamente sulla struttura sottostante, i pannelli che la compongono possono essere tagliati, montati, lavorati e finiti in una grande varietà di modi.
BALCONI SU MISURA IN LEGNO E HPL
Se da un lato l’idea di un balcone porta aria e leggerezza all’immobile, dall’altra le implicazioni legate alla sua realizzazione possono essere un deterrente per privati o

Nelle immagini, in sequenza la costruzione delle residenze Al Vigneto. In evidenza le colorazioni di facciata rimaste inalterate nelle palazzine del 2020 come in quelle del 2022 e del 2024




aziende e imprese non specializzate. Tramite rilievi, studi di fattibilità, render e consulenze accurati, l’ufficio tecnico BF progetta balconi e parapetti interni di design. Il primo requisito di ogni progetto è la sicurezza, requisito che ha portato la ricerca BF alla creazione di innovativi montanti per spinte fino a 200 kg, certificati secondo le normative vigenti.
La costruzione dei primi due condomini della residenza Al Vigneto, a Rovereto, in provincia di Trento, è avvenuta nell’anno 2020 con facciate di colore azzurro e grigio, nel 2022 è stata realizzata la palazzina verde e quest’anno sono state concluse le due ultime palazzine, ancora di colore azzurro e grigio. Nelle immagini che proponiamo si può notare che il colore è rimasto invariato nel tempo. Una caratteristica che rende i pannelli Hpl utilizzati per la facciata, che sono bifacciali, particolarmente resistenti agli agenti atmosferici. Sono stati utilizzati pannelli di spessore 6 mm con formati variabili da 650/100/1300 mm, mentre per i parapetti è stato utilizzato lo spessore di 8 mm, con montanti in alluminio certificati per la spinta 200 kg e corrimano in acciaio inox. Complessivamente, sono stati realizzati 1256 mq di balconi e 2297 mq di facciata nelle tinte grigio, verde jeep, silver blu e bianco.

Nella città orobica un evento che punta ad approfondire i temi legati alla sfida hi-tech per l’amministratore di condominio
Franco Saro
Anaci Bergamo ha organizzato per venerdì 16 maggio 2025 ore 9:00 presso la fiera di Bergamo, il convegno annuale Anaci Bergamo Incontra: in questa edizione verranno esaminate l’evoluzione tecnologica e il conseguente traino delle professioni. I temi trattati riguarderanno l’importanza delle aggregazioni e della dimensione (appeal, economie di scala, sicurezza gestionale, continuità), il lavoro di squadra.
IL PROGRAMMA
L’apertura dei lavori è prevista alle ore 9:30 con i saluti istituzionali, alle ore 10:20 interverrà il Segretario Nazionale dott. Andrea Finizio che tratterà «le nuove tecnologie e le forme d'aggregazione nell'etica e nella deontologia associativa», a seguire il Monsignor Giulio Dellavite presenterà il medesimo tema calato però nella vita quotidiana; alle ore 12:30 il dott. Enrico Cazzolino interverrà sul tema della resistenza al cambiamento, delle dinamiche di gruppo e le relative implicazioni. Dopo la pausa per il pranzo, alle ore 14:30, il Tesoriere dott. Matteo Gualandris esporrà alla platea le tipologie societarie
utili per aggregarsi, a seguire il dott. Gianluca Bonanomi introdurrà l’utilizzo dell’Intelligenza Artificiale nelle professioni. Alle 15:30 interverrà Giacomo Angeloni, Assessore al Comune di Bergamo e Presidente di Bergamo Smart City, porterà l’esempio dell ’ Associazione Bergamo Smart City come esempio di aggregazione e collaborazione. Alle 17:15 conclude il dott. Andrea Mapelli che presenterà degli esempi di applicazione dell’A.I. nella professione dell’amministratore di condominio.
EVOLUZIONE
«Importante partecipare», commenta il presidente Anaci Bergamo Bruno Negrini, «in quanto la professione dell’Amministratore di condominio è in continua evoluzione e conoscere le nuove tecnologie sotto ogni punto di vista è di estremo interesse per tutti noi».
L’ accesso all ’evento formativo è consentito a tutti gli amministratori di condominio e alle figure che gravitano intorno al mondo immobiliare quali gli agenti immobiliari, i geometri, gli architetti, gli ingegneri e i periti industriali. Ai partecipanti iscritti ad Anaci, all’Ordine degli Ingegneri, al Collegio dei Geometri e all’Ordine degli Architetti saranno riconosciuti i crediti formativi.

il patrocinio di







09:00 Registrazione presenze
09:30 Saluti istituzionali
Presidente ANACI Bergamo, Bruno Negrini
Presidente ANACI Lombardia, Renato Greca
Consigliere Regionale, Presidente della Commissione speciale “Autonomia e riordino autonomie locali” e membro del Comitato europeo delle regioni, Giovanni Malanchini
Europarlamentare, Onorevole Silvia Sardone
10:20 Le nuove tecnologie e le forme d'aggregazione nell'etica e nella deontologia Associativa
Segretario ANACI, Andrea Finizio
11:05 PAUSA CAFFÈ E NETWORKING
11:30 Nuove tecnologie e aggregazioni nell'etica e nella deontologia
Monsignor Giulio Dellavite

12:30 L’innovazione oltre l’abitudine - Relazioni umane nella trasformazione digitale
Enrico Cazzolino
13:30 PRANZO il pranzo è gratuito e verrà servito in galleria
14:30 Modi di aggregazione - vantaggi economici, finanziari e fiscali
Tesoriere ANACI Bergamo, Matteo Gualandris
15:30 Bergamo Smart City - come esempio di aggregazione e collaborazione
Assessore al Comune di Bergamo, Presidente di Bergamo Smart City, Giacomo Angeloni
16:00 PAUSA CAFFÈ E NETWORKING
16:30 Introduzione all’IA - utilizzo dell’IA nelle professioni
Gianluigi Bonanomi
17:15 Come interrogare l’IA - casi pratici nella professione di Amministratore
Andrea Mapelli
18:00 Dibattito
18:30 Chiusura lavori















Unoenergy Driwe è la soluzione per gestire i punti di ricarica elettrica all’interno di box e posti privati. E per i clienti anche un servizio della misurazione della Co2 all’interno dello stabile.
Franco Saro
Unoenergy, nata nel 2003, da oltre 20 anni è uno degli operatori privati sul territorio nazionale per la fornitura di gas naturale, energia elettrica e servizi di efficientamento energetico nel settore domestico, aziendale e condominiale attraverso un impegno costante e quotidiano. Massimo Bertoni è responsabile Area Lombardia di Unoenergy, che oggi si pone come partner affidabile per la transizione energetica servendo famiglie, aziende e condomini. Domanda. La concorrenza è sempre più agguerrita, come si distingue Unoenergy da tutti gli altri operatori? Risposta. Il nostro percorso di crescita richiede una squadra solida e qualificata e la forza commerciale, composta da circa 900 persone tra dipendenti e collaboratori, oltre a essere presente su tutto il territorio nazionale si distingue per competenza e una necessaria attitudine all’ascolto. Viviamo in un presente dinamico, in continuo cambiamento, e la certezza di avere un consulente vicino e disponibile garantisce una fiducia reciproca con l’amministratore. La squadra è il segreto del nostro successo.
D. Unoenergy come si posizione in tema di sostenibilità?
R. Il focus è costruire un domani sostenibile e noi operatori del mercato dobbiamo dare tutte le soluzioni necessarie per garantire alle generazioni future un mondo migliore. Il primo passo, il più immediato, è stato quello di
scegliere un prodotto di energia elettrica per i condomini che derivi esclusivamente da energia 100% solare certificata a zero emissione Co 2 (Energia Ethica). A questo si aggiungono interventi legati all’efficientamento energetico dell’immobile tra cui l’installazione di impianti fotovoltaici e la progettazione e manutenzione di impianti termici. Soluzioni concrete per raggiungere l’obbiettivo di ridurre le emissioni di gas serra sono richieste dall’Unione Europea entro il 2030 e portano a valorizzare tutto il patrimonio immobiliare.
D. L’offerta per l’associazione Anaci si è ampliata rispetto agli altri anni? Ci sono novità?
R. Rimanendo in ambito sostenibilità, Unoenergy ha voluto integrare ai servizi offerti anche il settore della mobilità elettrica. Unoenergy Driwe propone soluzione innovative, ma soprattutto sicure agli amministratori di condominio per gestire la sempre più alta richiesta di installazione di punti di ricarica elettrica all’interno di box e posti privati. Infine, a tutti i clienti viene offerto il servizio della misurazione della Co 2 per quanto riguarda l’utilizzo di combustibili fossili ed energia elettrica all’interno dello stabile. Un dato fondamentale per dimostrare il proprio impegno di riduzione emissioni come richiesta dalla direttiva Casa Green.

L’azienda si propone come unico interlocutore specializzato nella gestione dei servizi per il condominio, come fornitura di energia elettrica e gas interventi di efficientamento, adempimenti della privacy, polizze assicurative, software per lo studio
Franco Saro

VeryFastPeople è una società di consulenza e assistenza personalizzata rivolta agli amministratori condominiali per una gestione immobiliare sostenibile, tecnologica e semplificata. L’azienda nasce a Varese nel 2006 su iniziativa di tre giovani imprenditori: Andrea Veneziano, Michele Facco e Francesco Paini. L’obiettivo è innovare il settore della consulenza condominiale portando una nuova visione di condominio, che da semplice somma di unità immobiliari assume il valore di un moderno spazio da vivere nel segno dello smart living.
OTRE 8 MILA CLIENTI
Sono oltre 8 mila gli studi di amministrazione condominiale che hanno scelto VeryFastPeople: grazie a un team di esperti qualificati, l’azienda si pone come unico interlocutore specializzato nella gestione di molteplici servizi che vanno dalla fornitura di energia elettrica e di gas agli interventi di efficientamento energetico per l’ottenimento dei bonus fiscali, dagli adempimenti della privacy alla sottoscrizione delle polizze assicurative, fino alla fornitu -
ra di software per semplificare le attività quotidiane dello studio dell’amministratore.
Dalla collaborazione di VeryFastPeople con Illumia, nel 2020 è nata EnergyUp, società specializzata nella fornitura di luce e gas esclusivamente per il settore condominiale con una forte attenzione alla sostenibilità ambientale e alle ultime innovazioni tecnologiche. Per semplificare la gestione delle interazioni in tempo reale tra studio, fornitore e condòmini, VeryFastPeople ha messo a punto Copernico Crm, la prima piattaforma cloud specifica per amministratori di condominio. Inoltre, grazie alla collaborazione con Anaci, VeryFastPeople ha creato soluzioni assicurative che garantiscono il rimborso delle spese legali sostenute dai condomini per attività giudiziali e stragiudiziali, con particolare attenzione alla gestione del credito nei confronti di condòmini morosi. Nel 2025 VeryFastPeople è stata certificata da Great Place to Work Italia qualificandosi tra le migliori aziende in cui lavorare.
L’azienda propone la fornitura di servizi di lettura e ripartizione delle spese. Ma anche l'ideazione, realizzazione e manutenzione dei sistemi di contabilizzazione di riscaldamento, raffrescamento e acqua sanitaria condominiale
Franco Saro

Infinity Control Service offre al mercato la contabilizzazione dei consumi condominiali, affiancandovi un servizio professionale corredato da flessibilità e rapidità di risposta


Infinity Control Service è una società nata nel 2013. Ha come mission principale la fornitura di servizi di progettazione, realizzazione e manutenzione degli impianti di contabilizzazione del calore condominiale. L’azienda è organizzata per gestire la contabilizzazione di sistemi di riscaldamento, di raffrescamento e di consumo di acqua calda e fredda. Si occupa in modo diretto e autonomo della lettura periodica dei consumi, della loro validazione e, attraverso software dedicati, elabora la ripartizione delle spese a fine stagione o secondo le richieste.
CAMBIAMENTI E RISULTATI
La capacità dell’azienda di rimanere al passo dei trend di mercato e adattarsi al cambiamento, unitamente alla stretta collaborazione con imprese primarie che operano nel settore, la competenza e l’affidabilità che sottolinea Infinity Control Service fin dagli inizi, hanno consentito una veloce quanto solida espansione. Piccolo non vuol dire disorganizzato: l’azienda si propone sul mercato per cogliere nuove opportunità, con particolare attenzione all’innovazione tecnologica e digitale costruendo un progetto di sviluppo che ha portato al radicale cambiamento dei processi aziendali e di conseguenza una crescita costante.
IL VERO PROGRESSO
L’obiettivo di Infinity Control Service è presentarsi al mercato come leader nella contabilizzazione del calore condominiale, per offrire ai clienti prodotti e servizi di altissimo profilo tecnologico. A oggi sono pochissime le aziende che operano nel settore a poter competere con i grandi brand. Servizio professionale corredato da flessibilità e rapidità di risposta. Qualità, soluzioni personalizzate, assistenza totale, sono le caratteristiche fondamentali del metodo di lavoro dell’azienda, in costante evoluzione, con un occhio al passato, uno al presente e con la testa che tende al futuro.
L’organismo certificatore entra nel gruppo di cui fanno parte anche Csdm e IeS Degasperi. Obiettivo: fornire ad amministratori di condominio, aziende e clienti un supporto affidabile
Franco Saro
Nuovi scenari ed opportunità per Hdb, società che consolida il suo posizionamento nel settore della sicurezza degli edifici con l’ingresso di Eurocert nel gruppo. Nel percorso di continua crescita che Hdb, holding di proprietà della famiglia Dallagiovanna, sta portando avanti, la società apre un nuovo capitolo nella sua storia. Nel gruppo,
di cui fanno già parte, tra le altre, I ct Genesia , Csdm e IeS Degasperi , entra quindi lo storico organismo nel settore delle certificazioni Eurocert
PUNTO DI RIFERIMENTO
Questa operazione rappresenta un passo strategico per rafforzare la qualità dei servizi offerti, puntando su un’organizzazione ancora più solida ed efficiente. L’obiettivo è fornire ad amministratori di condominio, aziende e clienti un supporto affidabile, innovativo e capace di rispondere alle esigenze normative e di sicurezza. Grazie alla nuova sinergia, il gruppo si posiziona come punto di riferimento a livello nazionale, offrendo un servizio superiore in termini di gestione, consulenza e prevenzione dei rischi.
IL PROGETTO
«Siamo entusiasti di accogliere Eurocert nel nostro gruppo. È un passo importante per rafforzare la nostra leadership e offrire soluzioni sempre più performanti ai nostri clienti. Crediamo fortemente in questo progetto e siamo pronti a investire per alzare ulteriormente i nostri standard qualitativi», afferma Matteo Dallagiovanna, socio di Hdb. Un cambiamento che segna una nuova fase per il gruppo: uniti per una sicurezza più evoluta, con lo sguardo rivolto al futuro.


Una società di consulenza che supporta gli amministratori di condominio nella gestione delle attività quotidiane, ottimizzando i tempi e assicurando la piena conformità normativa: è soQuick. Attraverso un marketplace esclusivo, soQuick seleziona, qualifica rigorosamente e collabora con i migliori fornitori di servizi per condomini, proponendo soluzioni su misura nei settori e nergia e gas, contabilità condominiale, sicurezza, privac y, m anutenzioni ordinarie e straordinarie di i mpianti, efficienza energetica.
INTERLOCUTORE UNICO
Per questo soQuick si propone come interlocutore unico, che coordina tutti i servizi necessari, riducendo sensibilmente gli errori, semplificando le procedure amministrative e garantendo una maggiore efficienza operativa. Il consulente dedicato soQuick diventa un vero punto di riferimento, accompagnando l’amministratore in ogni fase. Inoltre, grazie all’utilizzo di tecnologie avanzate, aiuta gli amministratori nella gestione dei preventivi, contratti e comunicazioni in modo chiaro, semplice e trasparente.
La società di consulenza semplifica la vita dei professionisti nella gestione delle attività quotidiane, ottimizzando i tempi e assicurando la piena conformità normativa
Franco Saro

soQuick rappresenta l’expertise nella gestione tecnica e nella compliance dei condomini, dei patrimoni immobiliari privati e retail
Con oltre 8 mila condomini gestiti attraverso i servizi dei suoi partner e una rete di centinaia di amministratori, soQuick rappresenta un’eccellenza in continua crescita, garantendo vantaggi concreti grazie al proprio potere di acquisto che permette di ottenere condizioni privilegiate. Scegliere soQuick non comporta costi aggiuntivi né vincoli contrattuali per l’amministratore, ma più tempo libero, massima conformità normativa, qualità garantita e soddisfazione dei condòmini.
Per evitare il pericolo e garantire il rispetto della normativa, l’azienda propone un approccio integrato, che consente di ottenere le certificazioni previste, anche grazie a un supporto tecnico qualificato
Franco Saro
La sicurezza nei condomini non è solo una questione di estintori e porte tagliafuoco. Con Condomini Sicuri, Crotti propone un servizio integrato pensato per accompagnare gli amministratori in ogni fase della gestione della sicurezza condominiale: dai sopralluoghi alle certificazioni, fino alla formazione e all’assistenza in caso di emergenze.
« Spesso un amministratore si ritrova in difficoltà per la notevole complessità», racconta Luca Paravisi, tecnico commerciale Crotti e professionista antincendio per Efesto, studio tecnico di Bergamo. «Noi analizziamo la situazione, individuiamo le criticità e proponiamo soluzioni concrete, aggiornate e sostenibili». Il programma include anche l’istituzione del Registro Anagrafe Sicu -


rezza Condominiale (Rasc), una relazione dettagliata che tutela l’amministratore evidenziando carenze, anomalie e manutenzioni non eseguite.
CHECK-UP GRATUITO
Il check-up gratuito degli edifici è il primo passo: utile soprattutto quando si subentra in una nuova gestione, permette di conoscere lo stato di fatto dello stabile, dalle dotazioni antincendio alle condizioni delle vie di fuga. A questo segue un supporto costante per la risoluzione delle non conformità, anche tramite consulenze rapide via telefono, mail o WhatsApp. L’esperienza Crotti dimostra che la cultura della prevenzione è in crescita, ma non priva di ostacoli: «Si sottovaluta il rischio, si confondono normative o si considerano le porte tagliafuoco come porte comuni. Il nostro obiettivo è informare e formare, anche attraverso il supporto di specialisti e la collaborazione con partner come Efesto», prosegue Paravisi.
Crotti ha anche affrontato casi complessi: dall’incendio in un condominio industriale, dove un impianto idranti in perfette condizioni ha fatto la differenza, a situazioni dove è bastata una revisione progettuale per risparmiare migliaia di euro, senza compromettere la sicurezza. Un consiglio per gli amministratori? «Affidarsi a professionisti qualificati, sempre, non solo quando il problema è già emerso».
L’azienda è specializzata nella gestione degli elevatori condominiali e garantisce manutenzione e un eventuale supporto in tempi record, con un servizio sempre attivo, grazie anche a tecnici qualificati
Franco Saro
Gestione e manutenzione degli ascensori è la specialità di Duelle. L’azienda ha oltre 50 anni di esperienza nel settore e offre soluzioni all'avanguardia per garantire sicurezza, efficienza e comfort ai residenti. I motivi che, secondo Duelle, sono alla base della scelta dei suoi servizi da parte degli amministratori sono diversi. Il primo riguarda l’esperienza e la professionalità. Il team di tecnici qualificati è sempre aggiornato sulle ultime tecnologie e normative, assicurando interventi rapidi e risolutivi.


Inoltre, Duelle offre un servizio di manutenzione preventiva, con piani personalizzati per prevenire guasti e prolungare la vita utile degli ascensori, riducendo i costi di riparazione. In caso di guasto l’azienda garantisce interventi rapidi, con una rete di assistenza capillare e tempi di intervento ridotti, minimizzando i disagi per i residenti. Il servizio di assistenza è operativo 24 ore su 24, 7 giorni su 7, per garantire interventi tempestivi in caso di emergenze. Per il proprio lavoro Duelle utilizza strumenti diagnostici di ultima generazione per monitorare costantemente lo stato degli ascensori e intervenire tempestivamente in caso di anomalie. Un addestramento specifico del personale consente di affrontare e risolvere rapidamente situazioni di emergenza.
S UPPOORTO IMMEDIATO
Infine, agli amministratori l’azienda propone un servizio clienti dedicato, sempre a disposizione per rispondere a qualsiasi domanda e fornire supporto immediato, grazie anche a una formazione continua del personale: Duelle investe costantemente nella formazione i tecnici, perché siano sempre aggiornati sulle ultime innovazioni e normative del settore, con corsi su nuove tecnologie e attrezzature.



Sono 100 mila i condomini che utilizzano i servizi del gruppo, tra i maggiori in Italia. Una piattaforma online consente di monitorare consumi. Ma l’azienda offre anche soluzioni per l’efficientamento energetico
Franco Saro
Nel panorama energetico italiano, Duferco Energia si distingue come uno dei principali player del settore, con una leadership consolidata nella fornitura di energia agli amministratori condominiali. Un primato testimoniato da numeri significativi:
oltre 165 mila punti attivi nei condomìni, 450 GWh di energia elettrica erogati e più di 250 milioni di Smc (Standard metro cubo) di gas forniti ogni anno.
TEAM DI ESPERTI
Al centro di questa realtà c’è un modello di servizio innovativo e consulenziale, pensato per rispondere in modo pun-


tuale e personalizzato alle esigenze di oltre 14 mila studi di amministrazione e 100 mila condomìni serviti in tutta Italia. Con il Servizio Condomini, Duferco Energia mette a disposizione un team di esperti che affianca quotidianamente gli amministratori, offrendo molto più di un semplice help center: si tratta di un partner consulenziale, sempre pronto a supportare nelle scelte gestionali e operative legate alla fornitura energetica. La piattaforma online, accessibile 24/7 via app o web, consente ai clienti di monitorare i consumi, consultare le fatture e ricevere assistenza in modo rapido e intuitivo.
RETE CAPILLARE
Una rete capillare composta da oltre 350 consulenti energetici attivi su tutto il territorio nazionale assicura un servizio di prossimità, efficiente e tempestivo. A fianco degli studi amministrativi operano inoltre i business partner locali, che mettono a disposizione un consulente dedicato per ogni studio, un servizio personalizzato di gestione del credito, fatture chiare e compatibili con i principali software gestionali, convenzioni esclusive con le più importanti associazioni di categoria. Duferco Energia guarda anche al futuro dell’energia, offrendo soluzioni per l’efficientamento energetico e la verifica degli impianti, con progetti su misura per condomìni, imprese e abitazioni.
L’azienda, che opera sul mercato da 70 anni, offre condizioni speciali per i condomini, studiate per usufruire di prezzi competitivi. E ora si aggiunge anche la possibilità di installazione di pannelli solari
Franco Saro
Tra le offerte di Simecom dedicate a clienti domestici e partite Iva, ci sono anche quelle studiate nello specifico per il settore dei condomini, da sempre un mondo al quale l’azienda presta particolare attenzione. L’azienda si occupa di fornitura gas e luce da oltre 70 anni. Una storia che ha permesso al gruppo di maturare esperienza, professionalità e capacità di adeguarsi a ogni tipologia di esigenza richiedesse il mercato nel quale operava.
PRESENTI A BERGAMO
Inoltre, Duelle offre un servizio di manutenzione preventiva. Simecom vanta più di 180 mila clienti gas e luce e oltre 50 punti vendita in tutta Italia, ma la tendenza a crescere non si è mai arrestata, tanto che a breve sul territorio ne sono previsti altri due. A Bergamo, da luglio 2024, c’è un punto vendita in piazza Matteotti 8 (passaggio Zeduri). Carlo Ambrosioni, il front office, supportato da Alessandro Gallo e Thomas Marzullo, rispettivamente responsabile commerciale e account manager, sono diventati già punti di riferimento per i cittadini del territorio bergamasco, ma anche per tutti gli amministratori condominiali che, nel tempo, hanno deciso di affidarsi a Simecom come fornitore di energia gli stabili che gestiscono.
CONTRATTI SU MISURA
Le offerte condomini sono studiate per offrire un prezzo su misura, garantendo, a chi decide di affidarsi a Simecom, il miglior prezzo di mercato presente nel settore energia e un consulente energetico dedicato al quale potersi appoggiare in ogni momento e per qualsiasi tipologia di richiesta. Non solo, consapevole dell’importanza e della difficoltà nella gestione dell’immensa mole di dati ai quali spesso sono chiamati a far fronte gli amministratori, Simecom ha creato un portale dedicato al quale l’amministratore può accedere per controllare le fatture, i consumi e altri dati e anche un’offerta specifica per la privacy. Simecom, però, non è solo luce e gas. Da qualche anno offre ai clienti anche altri servizi, tra cui il fotovoltaico. Un’offerta completamente personalizzabile secondo le esigenze di ogni cliente che decide di affidarsi a Simecom per il proprio impianto.

Da oltre 50 anni l’azienda
è specializzata in disinfestazioni: dagli insetti ai roditori, fino alle zanzare sono eliminati con le migliori tecniche.
Ma altrettanto utile risulta la prevenzione in vista della stagione calda
Alice Fugazza

è un'azienda con presenza
Topi, ratti, blatte, piccioni, ma anche zanzare e insetti: sono gli ospiti indesiderati più comuni nei condomini. Per questo, quando ci si imbatte in questi parassiti, è bene affidarsi a esperti che riescono ad affrontare la problematica con servizi evoluti, mirati e anche sostenibili dal punto di vista ambientale, per eliminare definitivamente il target individuato e tutte le conseguenze del caso. Mocit, azienda con base a Bergamo che estende le sue competenze anche a Milano, Cremona e Brescia, da 50 anni si propone come un punto di riferimento per la risoluzione di queste problematiche, avvalendosi di strategie efficaci di Pest Control, per prevenire, operare e controllare la presenza di organismi infestanti. La loro valutazione del problema avviene quasi sempre in tempo reale accompagnata da una consulenza mirata. L’intervento è effettuato da un team di operatori altamente formato e professionale, al quale segue un follow up immediato. A completamento del servizio, infatti, i tecnici si preoccupano di seguire e verificare i risultati dell’attività svolta, in maniera che sia risolutiva. Greta Guazzi, responsabile amministrativa Mocit e Stefano Ziglioli, spiegano il funzionamento dell’attività, specialmente all’interno degli stabili. Domanda. Da quanto tempo Mocit si occupa di disinfestazione?
Risposta. Mocit Vanta una consolidata esperienza nel settore della disinfestazione dal 1975. Quest’anno infatti abbiamo festeggiato i 50 anni di operatività. La nostra azione si estende attraverso uno spettro mirato di interventi: ci occupiamo di derattizzazione, disinfestazione per contrastare i parassiti dannosi, sanificazione e disinfezione, allontanamento dei volatili, consulenze mirate e di monitoraggi, poiché la prevenzione è il primo passo per conseguire i migliori risultati. La nostra presenza è capillare in tutta la provincia di Bergamo, ma siamo presenti anche a Milano, Crema, Cremona e Brescia.
D. Quali problematiche si manifestano con maggiore frequenza?
R. In condominio principalmente riscontriamo infestazioni di roditori e di blatte.



D. Quali possono essere i problemi che causano questi animali infestanti?
R. Sicuramente la presenza di queste creature pone seri rischi per la salute, in quanto possono agire come vettori di virus e agenti patogeni, veicolando diverse malattie trasmissibili all’uomo. Basti pensare alla febbre dengue, trasmessa dalla zanzara tigre, malattia pericolosa e altamente infettiva.
D. Qual è la procedura che un condomino deve seguire in caso di infestazione?
R. Il condòmino è tenuto a segnalare tempestivamente la presenza dell’infestante all’amministratore di condominio, che provvede successivamente a formalizzare la richiesta di intervento, che può essere sia scritta che telefonica. La segnalazione viene poi recepita dai nostri referenti, che procedono a effettuare un sopralluogo preliminare assieme all’amministratore. Successivamente pianifichiamo l’intervento, cercando di essere efficaci e tempestivi. L’amministratore condominiale rappresenta il nostro principale interlocutore, è da lui che transitano tutte le istanze del caso ed è questa figura che funge da tramite diretto.
D. Quali misure devono essere adottate per garantire

la sicurezza durante un intervento di disinfestazione?
R. Al fine di mitigare potenziali rischi connessi all’impiego di sostanze chimiche, generalmente si raccomanda ai condomini di astenersi dal frequentare le aree sottoposte al trattamento durante l’esecuzione, specialmente quando vengono utilizzati prodotti liquidi per la disinfestazione antizanzare. Per quanto concerne invece gli interventi di derattizzazione, chiediamo di non manomettere o manipolare le esche rodenticide, che sono sempre collocate all’interno di contenitori di sicurezza sigillati.
D. La sanificazione interessa solo le aree comuni oppure si estende anche nelle unità abitative?
R. Solitamente riguarda le aree comuni, in quanto queste rientrano nella contrattualizzazione stipulata con l’amministratore. In specifiche circostanze e qualora ci sia necessità, si può procedere anche con interventi mirati all’interno delle abitazioni dei privati.
D. Chi paga le spese extra? Il proprietario dell’unità abitativa oppure tutto il condominio?
R. In linea generale, l’onere economico per gli interventi di disinfestazione nelle aree comuni è a carico dell’intero condominio. Possono verificarsi anche richieste particolari da parte dei singoli, che desiderano un’attenzione specifica per la propria abitazione. In questo caso il costo è sostenuto individualmente dal richiedente.
D. Ricevete richieste di intervento direttamente da parte dei condomini, al di fuori del canale amministrativo?
R. Sì, occasionalmente. Tuttavia, la nostra operatività è strettamente collegata alla collaborazione con gli amministratori condominiali, quindi la maggior parte dei nostri interventi riguarda le parti comuni degli edifici.
D. La disinfestazione suscita spesso domande legate all’utilizzo delle sostanze che possono essere nocive anche per le persone: come vi ponete di fronte a questa problematica?
R. Cerchiamo di selezionare prodotti con un profilo tos-


sicologico minimo, ovviamente in relazione alla specifica problematica da risolvere. A volte, però, l’utilizzo di prodotti a basso impatto potrebbe non essere efficace. In tutte le situazioni che affrontiamo forniamo sempre indicazioni dettagliate e prescrittive, comunicate attraverso un apposito modulo: si tratta di un documento che ha lo scopo di guidare sia l’amministratore sia i condomini su azioni e comportamenti da adottare durante l’intervento. Per esempio, mentre effettuiamo la disinfestazione zanzaricida, raccomandiamo di ritirare il bucato steso all’esterno e di mantenere chiuse sia porte che finestre.
D. Per quanto riguarda il rispetto dell’ambiente, quali precauzioni adottate durante le vostre operazioni?
R. Prediligiamo prodotti a basso impatto ambientale. Inoltre, adottiamo una tecnica di applicazione puntuale, per minimizzare la dispersione del prodotto nell’ambiente. Tutti i rifiuti derivanti dalle operazioni in cantiere, inoltre, sono smaltiti in conformità con le norme vigenti, trattati quindi come speciali.
D. Mocit interviene solamente a seguito di una segnalazione oppure effettua anche interventi preventivi?
R. Per quanto riguarda le infestazioni da zanzare, generalmente veniamo contattati a problema conclamato. La situazione è diversa per la disinfestazione contro le blatte, dove generalmente sono richiesti interventi preventivi. La nostra azienda, infatti, offre un pacchetto con formule di abbonamenti che prevedono interventi programmati all’inizio della stagione calda. Un approccio vantaggioso per i residenti, insomma, che generalmente preferiscono mantenere questo servizio piuttosto che il continuo ripresentarsi di un problema.
D. Come si articolano i vostri interventi?
R. Ogni intervento è preceduto da un sopralluogo, che può essere di natura fisica per le casistiche più complesse, sia telefonico per quelle più semplici. Si procede quindi con l’organizzazione dell’intervento, concordando le tempistiche con il cliente. Qualora si verificassero esigenze particolari, emettiamo schede tecniche e di sicurezza, con le indicazioni e le specifiche prescrizioni da osservare prima, durante e dopo. Dopodiché si svolge la disinfezione vera e propria, alla quale segue una fase di monitoraggio e valutazione, con report sui risultati conseguiti.
D. Quali certificazioni avete?
R. Siamo certificati Iso9001, a garanzia del nostro sistema di gestione per la qualità, Iso14001, che attesta il nostro impegno per sicurezza e ambiente, abbiamo la certificazione 11636, specifica per aziende professionali nel settore del Pest Control e da aprile 2025 siamo certificati anche Ecovadis, un network che raccoglie aziende virtuose sotto al profilo ambientale ed etico.
D. Chi ha un problema può contattarvi anche in rete?
R. Certamente. Sia privati che amministratori possono contattarci attraverso il nostro sito internet, mocit.it, rinnovato in occasione del nostro 50esimo anniversario. All’interno del sito si possono trovare le informazioni dettagliate su tutti i nostri servizi, i contatti, la storia dell’azienda e, molto importante, l’area riservata e dedicata ai clienti, che possono tenere traccia di documenti, storico e programmazione dei loro interventi. Per richiedere le disinfestazioni, inoltre, è stato predisposto un format apposito, compilabile direttamente sul sito, dove è possibile inserire nome, cognome e tipologia infestante riscontrata. Noi procederemo a ricontattare la persona che ha fatto richiesta.
Monitoraggio ed eventuale
intervento rapido per scongiurare il pericolo di contaminazione del pericoloso batterio negli impianti condominiali: è la mission dell’azienda che ha alle spalle 40 mila campionamenti annui
Franco Saro
Mai il legislatore fu più previdente nell'impostare il decreto 18/23. Ormai sappiamo tutti che è una realtà e che va applicato in tutti i condomini per tutelarli. I riferimenti normativi sono molteplici e spaziano da quanto espresso palesemente nel 18/23 agli articoli del Codice civile di riferimento sull ’obbligo di sorveglianza e tutela che l ’ amministratore deve avere. A due anni dall ’ inizio dell ’ applicazione del 18/23 l ’esperienza, gli effetti e le conseguenze sono la legionella, uno dei parametri obbligatori per il controllo della salubrità delle acque destinate al consumo umano, è presente nei condomini, spesso nei limiti legge, altre volte oltre, e in molti casi, purtroppo, con dei parametri gravemente non conformi.
I casi di persone decedute, oppure ospedalizzati a causa della legionellosi, sono noti a tutti, spinti anche dalla cronaca e da quotidiani di settore. Ha fatto clamore, inoltre, l'avviso di garanzia per omicidio colposo di un amministratore in Friuli lo scorso autunno. La realtà è che la legionella ovviamente è stata presente nella quotidianità, ma ora possiamo mettere in campo misure di gestione e di risoluzione della problematica collaborando e supportando gli studi amministrativi che hanno il compito di gestire tante altre situazioni sulla sicurezza all'interno dello stabile. Con l’esperienza che abbiamo maturato con oltre 40 mila campionamenti annui di legionella siamo organizzati per aiutare l’amministratore su tutto ciò che riguarda il problema della salubrità dell'acqua in condominio, in modo particolare della legionella.
I problemi non si vedono all’inizio, sorgono quando si individua la problematica o quando ci sono gravi situazioni riguardanti la salute dei condomini e bisogna gestirli nella maniera più opportuna. Csdm è specializzata in questo e l’amministratore non solo non è mai solo, ma con delle deleghe e fiducia può non occuparsi del problema, perché ci saranno a disposizione persone competenti che gestiranno con lui e per lui tutte le problematiche relative alla messa in sicurezza dell'edificio e dei condomini dove si presenta problematica.
Dunque, è fondamentale assistere l’amministratore e garantire una gestione a livello comunicativo nei confronti dei condomini, nei confronti degli enti preposti al controllo e soprattutto per orientarli nella scelta più adatta degli interventi tecnici a disposizione per la risoluzione del problema, senza dimenticare le attività di monitoraggio a breve, medio e lungo periodo in seguito agli interventi correttivi effettuati, affinché l’amministratore sia sempre considerato intoccabile dal punto di vista giuridico. Uno studio amministrativo inevitabilmente sarà sempre al centro delle problematiche, ma con i giusti consigli e il giusto supporto si trasformerà da primo imputato a semplice gestore di documenti, affinché le autorità giudiziarie possano fare la loro attività con la competenza che è ampiamente riconosciuta nel settore.
L’azienda, attiva in tutto il Nord Italia, è entrata a far parte del gruppo Vivienergia, sviluppando nuove sinergie. Gestisce interamente il servizio, garantendo attenzione e il controllo completo su tutto il processo
Partner e fornitori: scegliere quelli giusti è difficile, quanto mai fondamentale per gli amministratori di condominio e dei condomìni, che hanno bisogno di puntualità nel servizio, un rapido supporto e un rapporto di fiducia solido per quanto riguarda le utenze. Ma anche di qualcuno che si preoccupi di finanze e consumi. Bergamo Gas e Luce, con base nella città orobica, opera anche in tutto il Nord Italia con un format sartoriale per ogni centro. Presenta competenze per muoversi all’interno della filiera e si piazza come punto di riferimento per molte realtà, come racconta Antonio Bucci, direttore generale e socio dell’azienda. Domanda. Bergamo Gas&Luce è un’azienda radicata nel territorio: l’operatività si estende in quali aree geografiche?
Risposta. Sebbene le nostre radici affondino nel terreno bergamasco, origine che rivendico con orgoglio in quanto sono nato e cresciuto nella città, abbiamo ideato una strategia di sviluppo di replicazione del modello in

diverse province del Nord Italia. L’adozione di cover personalizzate con i nomi delle città si è rivelata una mossa efficace nel contesto, permettendoci di capitalizzare sul valore identitario dei singoli territori. Oggi la nostra presenza è significativamente concentrata nell’Italia settentrionale, come testimoniato dalle nostre sedi operative: abbiamo aperto infatti diversi distaccamenti con lo stesso format come Verona Gas e Luce, Torino Gas e Luce, Firenze Gas e Luce…
D. Il vostro progetto contempla un’espansione su scala nazionale?
R. Attualmente il nostro focus è il Nord Italia, che è il fulcro dello sviluppo. Ci stiamo espandendo anche nel Centro-Nord e non escludiamo comunque strategie di ampio respiro.
D. Quando è nata l’azienda?
R. Bergamo Gas e Luce è nata nell’ottobre del 2018, anche se le origini della società affondano in un’esperienza precedente, Milano Gas e Luce, fondata qualche anno prima dai miei attuali soci, appunto nel capoluogo lom -
bardo. Proprio loro mi proposero di adottare un modello di leadership efficace per crescere, per intraprendere un progetto ancora più ambizioso di sviluppo commerciale. Avendo maturato un buon portafoglio di clienti e un solido know-how, ho accettato la proposta di costruire una realtà analoga, ma con una nuova identità. Da questo incontro è nata così Bergamo Gas e Luce, successivamente Brescia Gas e Luce, anche in virtù del mio legame con la Franciacorta, dove attualmente risiedo. Tutte le nostre realtà operative sono caratterizzate da un profondo legame con ogni territorio: la nostra strategia, appunto, è stata quella di impiegare professionisti locali, dotati di competenze comprovate, una forte credibilità e saldi legami con il tessuto sociale e amministrativo. È questo che ci permette di operare con qualità e quindi, segnare un’ovvia differenza sul mercato.
D. La recente integrazione nel gruppo Vivienergia segna un punto di svolta per voi: quali sono i principali cambiamenti che state affrontando?
R. Il settore energetico è dinamico, complesso, soggetto a molti cambiamenti, dove la finanza riveste un ruolo predominante. Le turbolenze geopolitiche hanno scosso il mercato, generando conseguenze imprevedibili e mettendo alla prova la stabilità degli operatori e anche degli azionisti, che si sono trovati a fronteggiare qualcosa di insolito, in un contesto, quello dell’energia, che è sempre stato solido. La nostra azienda ha sempre retto, non abbiamo avuto momenti di particolare difficoltà, anche negli anni della pandemia. Tuttavia, in questo particolare momento storico
abbiamo incontrato Vivienergia, grande e solida azienda, animata dall’ambizione di sbarcare in specifici segmenti di mercato, trovando in noi il partner ideale. Forti della nostra presenza in contesti come quello condominiale, dove gestiamo un portafoglio di circa 20 punti vendita come gruppo, mentre loro sono focalizzati sul domestico e sulle Pmi, Vivienergia ha trovato in noi quello che cercava e viceversa. La visione è stata condivisa sin da subito. I loro investimenti nei nostri confronti ci hanno conferito una maggiore solidità: con un fatturato di circa 900 milioni di euro, questa integrazione ci proietta in una competizione di un altro livello, dove la solidità finanziaria sancisce un fattore cruciale. Abbiamo dunque chiuso gli ultimi anni con una crescita significativa, attestandoci a +54%.
D. Quali sono state le sinergie più significative generate dall’unione con Vivienergia?
R. I nostri mercati di riferimento sono compatibili, cosa che ha consentito una facile integrazione. La nostra specializzazione nei condomini e nelle aziende, dove gestiamo una vasta gamma di esigenze, ha trovato in Vivienergia un partner privo di knowhow specifico, ma dotato di una solida struttura. Una compatibilità che si è estesa anche in termini di territorialità e a livello manageriale, dove le competenze sono differenti, ma in questo caso, complementari.
D. Come società avete sempre dimostrato un forte impegno nel sociale: quali iniziative avete intrapreso nel passato e che cosa state facendo adesso? Quali collaborazioni sono previste anche con Vivienergia?

R. Vivienergia è molto forte sul tema della beneficenza, come testimoniano i numerosi eventi che organizzano e partnership con associazioni importanti. Come Bergamo Gas e Luce abbiamo sempre promosso diverse iniziative sociali, analizzando e scegliendo situazioni specifiche, e andando oltre le logiche di marketing. Generalmente, contribuiamo a raccolte fondi per aiutare persone bisognose e cerchiamo di organizzare almeno due o tre eventi all’anno dedicate al tema. Il prossimo giugno appunto, ospiteremo un evento a sostegno di una famiglia in difficoltà, in passato abbiamo supportato un bambino affetto da una grave malattia, fornito assistenza a una ragazza costretta a letto da anni a causa di un raro problema degenerativo e abbiamo mobilitato diverse realtà. I capitali raccolti, inoltre, li reinvestiamo nei territori nei quali siamo presenti, attuando iniziative di cura per valorizzare le comunità, cercando di creare un benessere collettivo.
D. Come si articola la vostra organizzazione aziendale?
R. A livello territoriale disponiamo di un ufficio a Bergamo con una parte di backoffice e la divisione commerciale, ai quali si affiancano le linee indirette. A Bergamo ci avvaliamo di dipendenti commerciali diretti, selezionati per competenza e capacità, giovani che sono una squadra e una famiglia. Inoltre, gestiamo interamente la filiera del gas, garantendo attenzione e controllo completo su tutto il processo. Per quanto riguarda amministrazione, finanza e logistica, l’integrazione con Vivienergia ha
apportato benefici significativi, semplificando le nostre operazioni e permettendomi di dedicare più risorse alla definizione delle strategie aziendali.
D. Quali sono i servizi che offrite ai vostri clienti?
R. Ci impegniamo a offrire solidità e qualità. Prendiamo in carico la gestione completa della fornitura, analizzando tutti gli aspetti, da quelli economici che riguardano alla bolletta, sino agli elementi tecnici. Avviamo analisi approfondite, ci focalizziamo sulle dispersioni di energia per ridurle, sugli aspetti fiscali e sui consumi della materia prima. Disponendo di una squadra altamente qualificata e grazie al knowhow che abbiamo consolidato, siamo in grado di aggregare gruppi di clienti e fornire una formazione adeguata attraverso tutoriale e assistenza continua.
D. Operate senza intermediazione, che cosa significa?
R. Questa modalità viene utilizzata solo in alcuni territori. Significa che implica l’utilizzo di agenti commerciali o procacciatori che operano direttamente sul territorio e il cui guadagno è legato in base alle vendite effettuate, distinguendosi da un dipendente diretto. Il rapporto diretto con l’azienda offre il vantaggio di poter interagire direttamente con l’imprenditore e di gestire le situazioni in maniera più efficace, che consente di avere margini di manovra per offrire benefit non indifferenti. Nel contesto condominiale poi, la puntualità nei pagamenti rappresenta un plus significativo.
D. Quali sono i vantaggi che potete offrire al mondo del condominio?


R. Elasticità nelle condizioni di pagamento, un supporto finanziario rilevante e una comprovata credibilità nell’attività di fornitura, aspetto fondamentale se si pensa alla crisi che stiamo affrontando negli ultimi anni. Garantiamo al cliente finale una copertura sicura e per le attività importanti possiamo intervenire con degli accordi sempre più strutturati. Il nostro è un approccio «da medico» che fa la differenza, poiché riusciamo ad analizzare e comprendere meglio le esigenze, fornendo soluzioni in totale trasparenza.
D. È possibile ridurre le spese legate ai consumi energetici?
R. Certamente, attraverso l’ascolto delle esigenze del cliente e un’analisi dei costi passanti, riusciamo a intervenire sulla componente tecnica, potenziando l’efficientamento energetico e agendo sulle infrastrutture esistenti.
D. Chi svolge un ruolo determinante per quanto riguarda la scelta del fornitore di energia? L’amministratore condominiale o il condomino?
R. L’amministratore condominiale esercita un’influenza significativa, se non determinante, in tutto il processo, ma è indubbio che tenga in considerazione le esigenze e le opinioni dei condomini. L’azienda che l’amministratore sceglie, però, deve essere seria, con valori dimostrabili e misurabili.
D. Offrite anche un supporto ai condomini?
R. Ovviamente. Siamo sempre disponibili all’ascolto e
ad approfondire dubbi e richieste: c’è tutta la trasparenza del caso e abbiamo anche un customer service dedicato per rispondere a queste necessità, anche se queste situazioni non si verificano spesso.
D. Il costo dell’energia però, non è ancora stabile…
R. Si percepisce un calo dei prezzi, nonostante il contesto rimane incerto. È prematuro trarre conclusioni affrettate, ma si prospetta una discesa in primis per il gas, seguito dall’energia elettrica. Le guerre e le tensioni geopolitiche invitano a muoversi con cautela.
D. Quali sono le vostre previsioni per il business?
R. Prevediamo una crescita del 20% per il 2025 e stiamo espandendo la nostra presenza con nuove sedi operative: abbiamo aperto a Genova, ad Asti, a Torino due nuovi uffici, a Varese, a Trento. Insomma, stiamo crescendo e questo sviluppo graduale sta portando con sei nuove risorse e un incremento dei numeri.
D. Qual è la vostra posizione in merito all’energia verde?
R. È sicuramente una realtà concreta oggi, sebbene riscontriamo uno scarso interesse da parte del pubblico. La nostra azienda è in possesso di tutte le certificazioni necessarie in questo ambito e, nel contesto condominiale, offriamo l’installazione di colonnine per la ricarica di e veicoli elettrici e proponiamo anche pacchetti completi per i pannelli fotovoltaici.
Manutenzione degli impianti termoidraulici e di climatizzazione, edilizia in fune, riqualificazione edilizia, rifacimento delle coperture, gestione del fascicolo tecnico, protezione dei dati, sicurezza: tutti i servizi per il condominio
Manutenzione degli immobili da programmare, normative che cambiano in continuazione per le quali bisogna costantemente aggiornarsi, sicurezza e contabilità. Materie complesse, che rendono difficile essere un amministratore di condominio. È la mission di Condominio 360, oggi 360 Group, azienda che ha cambiato non solo denominazione, ma sta crescendo, specializzandosi in tutti i rami di questo settore. Lo spiega Antonio Vivenzi, Cfo di 360 Group.
Domanda. Che cosa è Condominio 360 e quali sono state le principali tappe nella storia dell’azienda? Risposta. Condominio 360, ora evoluta in 360 Group, è nata nel 2023 da un’intuizione imprenditoriale di Antonio Bucci e dalla sua conoscenza del mercato. Ha compreso che c’era la necessità di colmare un’esigenza specifica del mercato degli amministratori di condominio attraverso un’offerta di servizi integrati e specialistici come la manutenzione degli impianti di riscaldamento e raffrescamento, la produzione di tutta la documentazione necessaria agli amministratori condominiali per essere in regola con il mercato di riferimento, quindi la privacy, la sicurezza, le certificazioni e l’edilizia in fune. La sua intuizione ha condotto appunto alla creazione di divisioni operative specializzate: Eco 360, dedicata alla ma-

nutenzione degli impianti termotecnici, Ced 360, focalizzata sui servizi di contabilità e gestione amministrativa, Service 360, specializzata negli adempimenti normativi in materia di sicurezza e protezione dei dati e Funi 360, ultima nata, attiva nel settore dell’edilizia acrobatica a partire da luglio 2024. L’azienda ha avuto un’accelerazione nel 2024 con queste società operative, culminata con il raggiungimento di un fatturato di 2,5 milioni di euro. La nostra società ha affermato la sua presenza nel territorio lombardo, in particolare nelle aree di Milano, Monza Brianza, Varese e Legnano, ed ha visto l’ingresso nella compagine sociale del Gruppo Alfano.
D. Quali sono i servizi che richiedono maggiormente gli amministratori di condominio?
R. Sicuramente la manutenzione degli impianti termoidraulici e di climatizzazione assieme alle soluzioni innovative offerte dall’edilizia in fune per interventi specifici. La nostra proposta di valore si fonda sulla concretezza e sulla capacità di rispondere in maniera efficace sia alle esigenze ordinarie che alle situazioni di emergenza, estendendoci fino a interven-
ti strutturali di riqualificazione edilizia, come il rifacimento delle coperture. A questo si affiancano i servizi complementari, come la gestione del fascicolo tecnico dell’immobile, gli adempimenti in materia di protezione dei dati personali e la verifica della sicurezza degli impianti.
D. I vostri clienti sono solo amministratori di condominio?
R. No, abbiamo cambiato il nome da Condominio 360 a 360 Group a dimostrazione dell’ampliamento del nostro raggio d’azione. La nostra offerta di servizi si rivolge anche a gruppi industriali, strutture sanitarie e assistenziali, nonché a quasi tutte le realtà che gestiscono patrimoni immobiliari. Inoltre, alcuni servizi, come la consulenza per la privacy e la gestione contabile, sono disponibili anche per alcuni clienti privati.
D. Avete cavalcato la fine del 110%: quanto ha influito sul vostro business e che cosa è cambiato da allora?
R. Non abbiamo vissuto quella stagione di euforia, ci siamo concentrati solo nella fase conclusiva del superbonus, gestendo le dinamiche di completamento di cantieri ormai avviati. Abbiamo registrato un incremento dell’attività alla fine del 2024: siamo imprenditori, dobbiamo seguire il mercato e cogliere tutte le opportunità, oltre agli incentivi statali.
D. Quali strategie state mettendo in atto per ottimizzare il rapporto con gli amministratori di condominio?
R. Il mercato degli amministratori condominiali si sta evolvendo verso una maggiore consapevolezza e partecipazione dei condomini nei processi decisionali. Per questo, qualità e affidabilità dei servizi erogati sono un punto di svolta, assumendo grande importanza. 360 Group si posiziona per gli amministratori come partner strategico in un mercato di transizione, orientandosi verso modelli operativi più industrializzati e improntati alla trasparenza, mettendo anche, normativamente parlando, l’amministratore stesso in sicurezza.

D. Siete in grado di risolvere qualsiasi tipo di problema all’amministratore condominiale, quindi, anche per il condomino?
R. Supportiamo gli amministratori di condominio strutturati, quelli che hanno molti condomini da gestire e che necessitano di partner affidabili e competenti per delegare la gestione di servizi specialistici. L’amministratore che si rivolge a noi ci conosce, predilige la qualità e la fiducia reciproca dove il prezzo non è il punto di caduta.
D. Prevedete iniziative di formazione dedicate agli amministratori di condominio?
R. Siamo partner attivi delle associazioni di categoria, con le quali c’è un mutuo scambio di informazioni, aggiornamenti normativi, unitamente alla presentazione dei nostri servizi specialistici. Un esempio concreto è rappresentato dalla nostra expertise in materia di protezione contro le scariche atmosferiche, un ambito normativo in evoluzione per il quale offriamo soluzioni mirate. È stata una fetta di mercato scoperta, che abbiamo studiato, personalizzato, professionalizzato e offerto al cliente finale, per il quale è una necessità alla quale deve adeguarsi.
D. Il passaggio generazionale in atto nella professione di amministratore di condominio presenta delle sfide: quali sono le vostre azioni in merito?
R. Il lavoro dell’amministratore condominiale non è semplice: richiede pazienza e continua formazione, insieme a una grande dedizione. La nostra struttura organizzativa e la gamma di servizi che offriamo sono concepiti per supportare una nuova generazione di professionisti che si affaccia a un mercato in continuo cambiamento, dove i paradigmi oggi sono molto differenti da quelli di allora, dove la capacità di partnership per ottenere servizi più performanti rappresenta un tratto distintivo.
D. L’Italia è ancora indietro con le manutenzioni programmate: quali sono le vostre strategie per risolvere questa problematica?
R. La nostra strategia è orientata alla promozione di soluzioni di servizio integrate e complete. Attraverso la nostra società di servizi Funi 360, proponiamo pacchetti che includono la manutenzione di linee vita, la pulizia di pannelli fotovoltaici e delle gronde, i più richiesti dagli immobili e quelli obbligatori. La programmazione degli interventi manutentivi rappresenta un valore aggiunto, significativo per l’amministratore. Noi ci stiamo specializzando anche in questo segmento e vediamo un mercato in crescita.
D. Come vede il futuro del condominio?
R. 360 Group fornisce al condominio delle risposte complete: offriamo servizi specializzati, veloci e fortemente orientati alla costruzione di relazioni di fiducia durature. Ambiamo a essere partner strategici per la gestione efficiente e sicura del patrimonio immobiliare.
AFFITTI BREVI
Gli affitti brevi richiedono una corretta comunicazione con l’amministratore di condominio, in conformità all’art. 1130 c.c.
La mancata trasmissione dei dati entro i termini può comportare responsabilità e sanzioni, influenzando la gestione condominiale e la sicurezza degli occupanti
Alberti
Nel mercato immobiliare odierno, gli affitti brevi rappresentano una realtà sempre più diffusa e apprezzata. Tuttavia, dietro la semplicità di un contratto di locazione turistica si nasconde una serie di obblighi giuridici, spesso sottovalutati, che coinvolgono direttamente il rapporto tra il locatore e l’amministratore di condominio.
OBBLIGHI DI COMUNICAZIONE
Una corretta gestione delle comunicazioni non è solo una buona prassi: è un vero e proprio obbligo di legge, con ricadute pratiche e responsabilità precise. L’art. 1130 n. 6 del Codice civile stabilisce che l’amministratore ha il compito di curare la tenuta dell’anagrafe condominiale, registrando le generalità dei proprietari e dei titolari di diritti reali o personali di godimento sulle unità immobi -

liari. Queste informazioni devono comprendere non solo il nome, ma anche il codice fiscale, la residenza o il domicilio. Ecco perché, ogni volta che un’unità immobiliare viene destinata ad affitti brevi, il locatore ha l’obbligo di comunicare tempestivamente all’amministratore i dati relativi ai conduttori. La legge fissa tempi precisi: entro sessanta giorni dalla variazione, il locatore deve inviare all’amministratore, in forma scritta, tutte le informazioni necessarie. Se richiesto, dovrà rispondere a eventuali integrazioni entro trenta giorni. Non rispettare queste tempistiche non è una semplice dimenticanza: è una violazione degli obblighi condominiali, come evidenziato dal Tribunale di Napoli nella sentenza n. 8344/2024.
RISCHI DERIVANTI DA OMISSIONI O RITARDI
In caso di omissioni o ritardi, l’amministratore ha la facoltà di sollecitare formalmente le informazioni mancanti tramite raccomandata. Se il locatore persiste nell’inadempimento, l’amministratore può acquisire autonomamente i dati, addebitandone il costo al condomino responsabile. Una misura che mira a tutelare l’interesse generale del condominio, a fronte di comportamenti individuali disattenti. La gestione degli affitti brevi presenta ulteriori implicazioni. La Corte d’Appello di Milano, con sentenza n. 93/2021, ha ribadito che la locazione breve è una forma di locazione turistica e non un’attività alberghiera. Tuttavia, pur rimanendo una locazione civile, essa deve rispettare gli stessi obblighi di comunicazione previsti per qualsiasi variazione nei titolari di diritti personali di godimento. Sul piano pratico, la mancata o incompleta comunicazione può comportare conseguenze significative. Per il locatore, oltre all’addebito dei costi per l’acquisizione dei dati mancanti, si aprono scenari di contestazioni formali da parte dell’amministratore e di responsabilità indirette in caso di problematiche di sicurezza o di gestione condominiale. Per l’amministratore, come precisato dal Tribunale di Rieti nella sentenza n. 329/2024, vi è l’obbligo di documentare ogni richiesta di informazioni e di mantenere l’anagrafe aggiornata, pena la propria responsabilità verso il condominio.
PRIVACY E GESTIONE DEI DATI
Non bisogna dimenticare gli aspetti legati alla privacy. Secondo la sentenza del Tribunale di Roma n. 15964/2024, la raccolta dei dati da parte dell’amministratore, finalizzata all'aggiornamento dell’anagrafe condominiale, è pienamente conforme al Gdpr. La richiesta di informazioni personali non costituisce violazione della riservatezza, bensì adempimento di un obbligo legale.
BUONE PRATICHE PER UNA GESTIONE EFFICACE
Per evitare rischi, sono raccomandate buone pratiche operative sia da parte dei locatori che degli ammini -

stratori. Il locatore deve predisporre un sistema interno per comunicare tempestivamente ogni nuova locazione breve, conservando copia delle comunicazioni inviate e rispondendo puntualmente a eventuali richieste di integrazione. L’amministratore, dal canto suo, deve implementare procedure snelle ed efficienti per la gestione dell’anagrafe, documentare tutte le richieste e aggiornare costantemente i dati raccolti. Le conseguenze di un inadempimento sono chiare: come ha evidenziato il Tribunale di Pisa nella sentenza n. 1337/2022, il locatore che omette di fornire i dati o li comunica in modo incompleto è responsabile degli effetti negativi che da ciò derivano. L’interesse primario alla corretta gestione delle informazioni condominiali è del condomino stesso, che risponde delle proprie omissioni anche economicamente. In definitiva, l’affitto breve non si esaurisce nel mero rapporto tra proprietario e inquilino: ha riflessi diretti sulla gestione condominiale e coinvolge obblighi precisi nei confronti dell’amministratore e della collettività condominiale. Chi opera in questo settore deve sapere che una corretta comunicazione non è un optional: è una responsabilità giuridica concreta. La tempestività, la completezza e la trasparenza nelle informazioni sono oggi le chiavi per garantire una gestione serena e conforme degli affitti brevi all’interno del condominio. Un investimento minimo in organizzazione che evita rischi molto più grandi in futuro.

Il Registro Anagrafe Sicurezza (RAS) è un obbligo normativo fondamentale per gli amministratori di condominio.
La sua corretta gestione garantisce sicurezza, tutela legale e riduzione dei rischi, migliorando la qualità del servizio e proteggendo il valore patrimoniale degli immobili

Il Registro Anagrafe Sicurezza (RAS) si sta imponendo come uno strumento imprescindibile nella gestione professionale degli immobili condominiali. Introdotto dalla Legge 220/2012 e potenziato dal dl 145/2013 (convertito con legge 9/2014), il RAS non è solo un documento amministrativo: è il sistema operativo della sicurezza condominiale.
OBBLIGO NORMATIVO
L’art. 1130 n. 6 del Codice civile impone all’amministratore di documentare ogni dato rilevante sulle condizioni di sicurezza delle parti comuni, ma la portata pratica di questa previsione va ben oltre la mera registrazione. Per gli amministratori di condominio, i tecnici e gli operatori del settore, il RAS rappresenta oggi un obbligo normativo che implica responsabilità civili e penali, ma anche un’opportunità per qualificare il servizio offerto, migliorare la gestione e ridurre il rischio di contenziosi. Il recente orientamento giurisprudenziale rafforza ulteriormente questo quadro.
RESPONSABILITÀ E RIS CHI LEGALI
La Cassazione penale, con la sentenza n. 33114/2024, ha chiarito che l’amministratore ha l’obbligo giuridico di presentare la Scia antincendio ove richiesta e risponde penalmente per l’omessa presentazione, anche con riferimento a situazioni pregresse non ancora regolarizzate. È quindi evidente che chi assume la gestione di un condominio deve procedere immediatamente alla verifica dello stato documentale e tecnico degli immobili amministrati.
IMPIANTI
Anche gli impianti elettrici sono oggi al centro dell’attenzione. La Cassazione civile, con la sentenza n. 3109/2024, ha richiamato la necessità di garantire la qualità e la sicurezza della distribuzione interna dell’energia elettrica, imponendo all’amministratore un obbligo di vigilanza e di intervento

diretto per mantenere gli impianti conformi agli standard di legge. Il Tribunale di Santa Maria Capua Vetere, con la sentenza n. 4279/2023, ha ulteriormente specificato che l’amministratore ha un obbligo di compiere tutti gli atti conservativi delle parti comuni, comprese le verifiche antincendio e l’acquisizione delle certificazioni necessarie. In caso di omissione, egli può essere chiamato a rispondere dei danni patrimoniali subiti dal condominio. Una linea di continuità si ritrova anche nell'ordinanza n. 8415/2024 della Cassazione civile: la mancata ottemperanza agli obblighi di certificazione si traduce non solo nella responsabilità personale dell’amministratore, ma anche nella responsabilità solidale del condominio, con conseguente obbligo di risarcimento danni a terzi.
APPROCCIO SISTEMATICO
Operativamente, la gestione del RAS richiede un approccio sistematico: ispezioni periodiche sugli impianti elettrici, sui sistemi antincendio, sulle strutture portanti, sugli impianti idrici e sugli ascensori devono essere pianificate e documentate secondo un cronoprogramma rigoroso. Il RAS prevede verifiche mensili (estintori, illuminazione di emergenza), trimestrali (impianti elettrici, sistemi di pompaggio), semestrali (manutenzione estintori, controllo ascensori) e annuali (analisi strutturale).
RISCHIO COPERTURE ASSICURATIVE
Le implicazioni di una gestione non conforme sono pesanti: sanzioni amministrative, responsabilità civili, ipotesi di responsabilità penale per infortunio o danno a persone, revoca dell’amministratore, invalidazione delle coperture assicurative condominiali. Il Tribunale di Milano, con la sentenza n. 3881/2024, ha infatti ribadito che la mancata o irregolare tenuta del RAS può compromettere il diritto del condominio
a far valere le proprie coperture assicurative. Il Tribunale di Aosta, con la sentenza n. 307/2021, ha inoltre precisato che l’amministratore è obbligato a effettuare controlli aggiuntivi e specifici in presenza di cisterne, impianti di accumulo o sistemi di trattamento dell’acqua centralizzati, situazioni che richiedono verifiche periodiche aggiuntive e aggiornamenti puntuali del Registro.
Guardando in avanti, l’evoluzione normativa e giurisprudenziale è chiara: la gestione della sicurezza condominiale sarà sempre più integrata con sistemi di controllo documentale digitali e laboratori di analisi certificati. La Cassazione civile, con l’ordinanza n. 29493/2023, ha infatti indicato che l’amministratore dovrà organizzare controlli tecnici strutturati e caricare i dati all’interno di piattaforme centralizzate.
Per gli operatori del settore, il RAS rappresenta quindi una sfida ma anche una straordinaria opportunità di crescita. La sua corretta gestione consente di elevare il livello di qualità del servizio offerto, di costruire una documentazione che tutela l’amministratore in caso di contestazioni, e di garantire agli utenti finali – i condòmini – una maggiore sicurezza dell’ambiente in cui vivono. La sicurezza condominiale non è più un tema marginale. È diventata un asset fondamentale di gestione immobiliare, un elemento di valutazione delle competenze professionali e un parametro di valore patrimoniale degli immobili. Perché la vera sicurezza non si limita ad essere dichiarata: si documenta, si misura e si certifica. Giorno dopo giorno, controllo dopo controllo, pagina dopo pagina del Registro Anagrafe Sicurezza.

Avv. Roberto Tomassoni*
Esperto condominialista,
Ordine Avvocati
Roma
È nulla per contrarietà a norma imperativa la delibera condominiale che nomini o confermi amministratore un soggetto privo dei requisiti di professionalità, inclusa la frequentazione dei corsi obbligatori di formazione, essendo tali requisiti dettati a tutela degli interessi generali della collettività

La figura dell’amministratore di condominio riveste un ruolo centrale nella gestione degli interessi della collettività condominiale. Data l’importanza e la complessità dell’incarico, il legislatore ha previsto requisiti specifici di professionalità e onorabilità per chi intenda esercitare tale funzione. Ma cosa succede quando l’amministratore non possiede i requisiti di formazione obbligatori? La questione ha diviso dottrina e giurisprudenza per anni, ma recenti pronunce hanno definitivamente chiarito le conseguenze giuridiche della mancanza di tali requisiti.
REQUISITI SOGGETTIVI E PROFESSIONALI
L’articolo 71-bis delle disposizioni di attuazione del Codice Civile stabilisce, tra l’altro, che possono svolgere l'incarico di amministratore coloro che hanno frequentato un corso di formazione iniziale e svolgono attività di formazione periodica. I requisiti di diploma e formazione non sono necessari se l’amministratore è nominato tra i condomini dello stabile. Inoltre, chi aveva già svolto attività di amministrazione per almeno un anno nei tre anni precedenti l’entrata in vigore della norma (18 giugno 2013) è esonerato solo dal corso iniziale, ma deve comunque effettuare l’aggiornamento annuale.
MANCANZA DI FORMAZIONE
Nel tempo si sono delineate due posizioni interpretative:
• tesi meno rigorosa (oggi minoritaria): sosteneva che la mancanza dei requisiti di formazione rendesse la nomina solo revocabile, non nulla. I suddetti requisiti, infatti, tutelerebbero non la collettività generale, ma esclusivamente la collettività condominiale (cfr. Tribunale di Padova, 24 marzo 2017, n. 818).
• tesi rigorosa (oggi prevalente): afferma che l’articolo 71bis è norma imperativa posta a tutela di interessi generali della collettività. Il difetto originario dei requisiti comporta la nullità radicale della delibera di nomina, poiché contraria all’ordine pubblico.
PREVALE LA TESI DELLA NULLITÀ
Il punto di svolta si è avuto con la pronuncia della Cassazione civile, sez. II, 31 ottobre 2024, n. 28196 con la quale si è chiarito come:
• il requisito della formazione iniziale non è un adempimento formale, ma un presupposto di capacità sostanziale;
• la nullità deriva dalla violazione dell'ordine pubblico;
• l’amministratore senza requisiti non può chiedere il pagamento del compenso;
• è nulla anche la proroga tacita dell’incarico (principio quod nullum est nullum producit effectum).
Recentemente, sul punto, anche la sentenza del Tribunale di Castrovillari del 14 marzo 2025 n. 470 che ha affermato come, nel caso a esso sottoposto:
• l'amministratore non aveva frequentato i corsi di formazione periodica;
• l'articolo 71-bis delimita chi può assumere incarichi condominiali per ragioni di ordine pubblico;
• tale norma è imperativa e inderogabile;
• la nullità deriva dal principio generale dell’articolo 1418 c.c. sulla nullità degli atti contrari a norme imperative.
COMMENTO E CONCLUSIONI
La giurisprudenza recente ha tracciato un percorso chiaro:

la formazione iniziale e l’aggiornamento annuale non sono mere formalità, ma condizioni essenziali per l’esercizio della professione. I requisiti dell’amministratore di condominio non sono opzionali, ma rappresentano un presidio a tutela dell’intera comunità condominiale.
L’assemblea, nel momento della nomina o della conferma, non può prescindere dalla verifica del possesso di tutti i requisiti previsti. Ignorarli espone il condominio non solo al rischio di una delibera nulla, ma anche alle conseguenze negative derivanti dall’affidamento della gestione a un soggetto non pienamente qualificato.



La consegna della lista dei condomini morosi è disciplinata dall’art. 63 disp. att. c.c., imponendo all’amministratore l’obbligo di fornire i dati ai creditori insoddisfatti. La recente sentenza della Cassazione n. 1002/2025 ha attribuito la responsabilità in capo all’amministratore in proprio, con possibili risvolti risarcitori
La consegna della lista dei condomini morosi potrebbe, a oggi, rappresentare il titolo o la trama di uno dei film più visti nel “cinema” condominiale. L’art. 63 delle disposizioni di attuazione al codice civile è la norma di riferimento, vera croce e delizia per l’amministratore, per i motivi che si diranno di seguito.
NORMA DI RIFERIMENTO
Stiamo parlando dell’art. 63 delle disposizioni di attuazione del codice civile, comma 1. La norma citata dispone che l’amministratore “è tenuto a comunicare ai creditori non ancora soddisfatti che lo interpellino i dati dei condomini morosi”. La ratio voluta dal legislatore (L. 220/2012) si rinviene nella necessità di assicurare che l’amministratore effettivamente e concretamente si ado -
peri e collabori con i terzi creditori del condominio, in forza dei principi di buona fede e correttezza.
Se l’amministratore non consegna la “lista dei condomini morosi”? Chiaramente, in caso di inottemperanza dell’amministratore, il creditore del condominio dovrà rivolgersi all’Autorità Giudiziaria. Ma qui subentra un’altra problematica più volte oggetto di problematiche: Chi convenire in giudizio? L’amministratore in proprio o il Condominio in persona dell’amministratore? Le problematiche sorgono perché due sono le tesi, contrapposte.
La prima, sino ad oggi decisamente minoritaria, è quella che ritiene sussistente la legittimazione passiva dell’amministratore in proprio, trattandosi di obbligo posto dalla legge a carico dello stesso (cfr. Tribunale di Catania, Ordinanza del 16.01.2018; Tribunale di Napoli, Ordinanze del 01.02.2017 e del 05.09.2016, Tribunale di Torre Annunziata, Ordinanza del 13.07.2018). Secondo, invece, la tesi maggioritaria, la legittimazione passiva, in caso di mancata consegna spontanea, da parte dell’amministratore, della citata lista, sarebbe del condominio in persona dell’amministratore. Una tesi più volte
Obbligo di legge? Ci pensiamo noi.
Il Decreto Legislativo 18/2023 impone il controllo periodico dell’acqua potabile nei condomìni. ista ti aiuta a rispettare la norma, proteggendo residenti e amministratori da rischi e sanzioni. Cosa ti offriamo:
• Prelievi certificati Tecnici specializzati eseguono analisi professionali. Tutta la filiera ista è certificata.
• Gestione su misura Pianifichiamo gli interventi per garantire conformità costante alla normativa.
• Assistenza completa Ti supportiamo anche in caso di ispezioni e controlli da parte delle autorità.
Servizio professionale, gestito da esperti ista.


ribadita da varie pronunce di merito nel corso del tempo. Basti citare il Tribunale di Napoli, con un’ordinanza del 12.3.2022 ove si legge “che peraltro il legittimato passivo deve ritenersi il Condominio in persona dell’amministratore p.t., potendo quest’ultimo essere revocato in ogni momento e dunque non obbligato ad adempiere l’ordi -

Scansiona ora il QR code e metti in regola il tuo condominio.

nanza che si chiede di pronunciare”. O, ancora, l’ordinanza del Tribunale di Roma del 1° febbraio 2017, Sezione Quinta Civile, Giudice Dott. Mario Bertuzzi secondo cui “ritenuto che il ricorso appare fondato, atteso che, ai sensi dell'art. 63 disp. att., cod. civ., il condominio e per esso il suo amministratore ha l'obbligo di comunicare al proprio creditore insoddisfatto i dati dei condomini morosi nel pagamento dei contributi condominiali relativi al credito stesso”; oppure ancora, per rendere l’idea della frequenza di tale tesi, la sentenza del Tribunale di Roma, n. 10424/2018 che ha condannato il condominio (e non l’amministratore) alla consegna dei dati richiesti, sulla base che “le relazioni interne al condominio e i rapporti intercorsi tra i condomini e i vari amministratori non interessano e non possono avere rilevanza sulla società creditrice che da anni non vede soddisfatto il proprio credito per lavori effettuati in favore del Condomino. Deve pertanto ritenersi la carenza di legittimazione pas -
siva, nel presente procedimento, del precedente amministratore” (cfr. ordinanza del 17.2.2020 del Tribunale di Roma, Sez. Quinta, Giudice Miccio; sentenza del Tribunale di Roma, n. 1190/2024).
NOVITÀ GIURISPRUDENZIALE
Suprema Corte di Cassazione, sentenza n. 1002 del 15 gennaio 2025. Con la citata sentenza n. 1002/2025, la Suprema Corte ribalta l’orientamento maggioritario sopra descritto e afferma che “la legittimazione passiva deve ravvisarsi in capo alla persona dell’amministratore in proprio”.
Secondo la Suprema Corte, “la consegna dei dati dei morosi al terzo creditore non rientra tra le attribuzioni dispositive e i poteri rappresentativi dell’amministratore riferibili al condominio alla luce degli artt. 1130 e 1131 c.c.”; ne consegue che “dall’omessa o intempestiva esecuzione di essa non può ridondare alcuna responsabilità
ricadente nella sfera giuridica del condominio, e la conseguente condanna deve essere emessa in danno dell’amministratore in proprio”.
Il principio espresso dalla Suprema Corte è pertanto il seguente : “in tema di condominio negli edifici, la domanda volta a conseguire l’ordine di comunicare al creditore non soddisfatto i dati dei condomini morosi, ai sensi dell’art. 63, comma 1, disp. att. c.c., deve essere rivolta nei confronti dell'amministratore, e non del condominio, trattandosi di obbligo posto dalla legge all’amministratore del condominio in proprio”.
Il rischio per l’amministratore di condominio: ipotesi di responsabilità aquiliana. Chiarito il cambio di orientamento indicato dalla Corte di Cassazione, quello che, ad avviso di chi scrive, rappresenta un vero e proprio “rischio” per l’amministratore (se non adeguatamente tutelato), è la massima desumibile dalla sentenza 1002/2025 citata, che di seguito si riporta: L’obbligo di comunicazione previsto dal primo comma dell'art. 63 delle disp. att. c.c. è “un obbligo derivante dalla legge e gravante sull’amministratore in proprio e non quale amministratore del condominio, la cui violazione integra un’ipotesi di responsabilità aquiliana” posto che “il ritardo dell'amministratore nella comunicazione al terzo creditore dei dati dei condomini morosi è, infatti, potenzialmente idoneo a causare un danno allo stesso creditore, per via del rallentamento provocato alla realizzazione coattiva delle sue ragioni”.
Corollario della valutazione della condotta dell’amministratore che non consegni la “lista dei condomini morosi” al terzo creditore che ne abbia fatto richiesta, seguendo la tesi della Suprema Corte (responsabilità aquiliana), è il seguente : rilevato che l’obbligo di comunicazione ex art. 63 delle disp. att. c.c. è “un obbligo derivante dalla legge e gravante sull’amministratore in proprio e non quale amministratore del condominio, la cui violazione integra un’ipotesi di responsabilità aquiliana”, allora la diretta conseguenza porta ad affermare che l’amministratore è a rischio di richiesta di risarcimento danni. Sarebbe, quindi, ravvisabile nella sua condotta (ritardo e/o mancata consegna della lista) a giustificare un’azione di richiesta di risarcimento del danno, da parte del terzo creditore del condominio, nei confronti dell’amministratore in proprio, ove ne ricorrano i presupposti.


Avv. Carlo Pikler* Vicepresidente de Il Foro Immobiliare
La nomina dell’amministratore di condominio è soggetta a regole formali rigorose. La mancata indicazione del compenso comporta la nullità della delibera, ma gli atti successivi restano validi grazie alla prorogatio imperii, garantendo la continuità gestionale fino alla nomina del successore
Avv. Carlo Pikler*

La gestione condominiale richiede stabilità e certezza nei rapporti giuridici. Per questo, la legge disciplina in modo rigoroso la nomina dell’amministratore, imponendo precisi requisiti formali. L’articolo 1129, comma 14, del codice civile stabilisce che, all’atto dell’accettazione della nomina o del suo rinnovo, l’amministratore debba specificare analiticamente l’importo del compenso dovuto, a pena di nullità della nomina stessa. Ma cosa accade agli atti compiuti da un amministratore se la sua nomina viene dichiarata nulla per la mancata indicazione del compenso? La risposta è stata recentemente fornita dal Tribunale di Caltanissetta, con la sentenza n. 186 del 10 marzo 2025.
LA VICENDA PROCESSUALE
A promuovere il giudizio sono stati due condòmini, proprietari di sei unità immobiliari, che hanno impugnato tre delibere condominiali. Essi chiedevano:
• la dichiarazione di nullità delle delibere nella parte in cui si era proceduto alla nomina e al rinnovo dell’amministratore;
• la conseguente dichiarazione di nullità di tutti gli atti posti in essere da quest’ultimo.
La doglianza si fondava sulla violazione dell’articolo 1129, comma 14, c.c., per l’omessa indicazione analitica del compenso dovuto all’amministratore al momento della nomina e del rinnovo.
Il condominio, di contro, difendeva la legittimità delle delibere sostenendo:
• che si trattasse di un rinnovo, e non di una nuova nomina;
• che il compenso potesse desumersi dall'approvazione del bilancio consuntivo.
IL VALORE DEL REQUISITO FORMALE
Il Tribunale di Caltanissetta ha accolto la tesi degli at -
tori in relazione alla nullità delle delibere. Richiamando l'interpretazione rigorosa dell'articolo 1129 c.c., il giudice ha ribadito che il requisito formale della nomina dell’amministratore dev’essere soddisfatto attraverso:
• una specifica indicazione analitica del compenso, da riportare nel verbale di nomina o nel preventivo allegato e richiamato espressamente;
• una chiarezza preventiva rispetto all’obbligazione economica assunta dal condominio nei confronti dell’amministratore.
Secondo il Tribunale, non è sufficiente che il compenso emerga indirettamente da documenti come il bilancio consuntivo o che venga dedotto da prassi consolidate all'interno della gestione condominiale. La ratio della norma è quella di tutelare il diritto dei condòmini alla piena consapevolezza dei costi della gestione, evitando sorprese o discrezionalità in fase successiva alla nomina. In questo senso, l'assenza dell'indicazione specifica comporta la nullità della nomina o del rinnovo dell'incarico, con effetti rilevanti sulla regolarità dell'atto assembleare e sulla stabilità dell’amministrazione stessa. Per giunta, sul punto si ricorda anche come il Tribunale di Oristano, con sentenza n. 451 del 07/08/2023, ha chiarito come sia irrilevante che il compenso sia rimasto invariato rispetto al passato o che l’assemblea sia già al corrente del suo



ammontare. Anche l'inserimento dell'importo nel bilancio preventivo non è sufficiente, in quanto rappresenta una mera stima delle spese future soggetta a variazioni in sede di consuntivo.
Gli atti compiuti dall'amministratore sono validi grazie alla prorogatio imperii. Pur riconoscendo la nullità delle delibere, il Tribunale ha ritenuto pienamente validi gli atti compiuti dall’amministratore successivamente alla nomina invalida. La decisione si fonda sul principio, consolidato nella giurisprudenza di legittimità, della prorogatio imperii. In particolare, la proroga dei poteri dell’amministratore opera automaticamente in tutte le ipotesi in cui il condominio rimane privo di amministratore, sia per scadenza naturale del mandato, sia per dimissioni, revoca o dichiarazione di nullità della nomina. Tale meccanismo è finalizzato a garantire la continuità della gestione condominiale, preservando l’interesse comune dei condòmini a non lasciare vacante l’ufficio di amministratore. Durante il periodo di proroga, l’amministratore conserva: il potere di compiere atti ordinari di gestione (pagamenti, riscossione delle quote, manutenzioni urgenti); il potere di rappresentanza legale e processuale del condominio; il potere di convocare l'assemblea per la nomina del successore. La validità degli atti compiuti si fonda, dunque, sulla
presunzione di conformità alla volontà assembleare, che, sebbene implicita, è orientata a garantire la funzionalità della struttura condominiale. È importante sottolineare che la prorogatio imperii cessa soltanto con la nomina di un nuovo amministratore da parte dell’assemblea o in presenza di una delibera esplicita di revoca dei poteri all’amministratore cessato. In assenza di tali interventi, l’amministratore continua ad agire legittimamente e validamente, senza interruzioni di operatività.
CONCLUSIONI
L'assenza dell'indicazione analitica del compenso comporta la nullità della delibera di nomina o di rinnovo dell’amministratore. Tuttavia, gli atti da lui compiuti successivamente sono pienamente validi, grazie al principio della proroga dei poteri fino alla nomina del successore. L’amministratore, anche se formalmente cessato o nominato invalidamente, mantiene la legittimazione a gestire gli interessi del condominio e a rappresentarlo anche in giudizio. La perpetuatio imperii garantisce così un equilibrio tra la rigorosa osservanza delle regole formali e l’esigenza pratica di assicurare continuità ed efficienza nella gestione condominiale. Un principio che evita il rischio di paralisi amministrativa, proteggendo l’interesse comune dei condòmini e confermando la centralità dell'amministratore nella vita del condominio.
Abbonati a Lattoneria
Periodico per il settore della lattoneria edile e della copertura metallica

1 anno 4 numeri
1 anno 4 numeri
https://www.virginiagambinoeditore.it/riviste/lattoneria/ 6 numeri
€ 18,00 anziché € 20,00
€ 22,00 anziché € 28,00

Per abbonarsi è possibile sottoscrivere l’abbonamento online al link http://www.youtradeweb.com/abbonati-alle-riviste/ oppure, fare richiesta a abbonamenti@vgambinoeditore.it o telefonando al numero + 039 02 47761275
CUMULO DI INCARICHI

Negli ultimi anni, il dibattito sulla possibilità di esercitare contemporaneamente le attività di agente immobiliare e amministratore di condominio ha suscitato interesse nel settore. La giurisprudenza non prevede un divieto assoluto, ma evidenzia il rischio di conflitto di interessi, richiedendo trasparenza e separazione operativa tra le attività

Negli ultimi anni, il dibattito sulla possibilità di esercitare contemporaneamente le attività di agente immobiliare e amministratore di condominio ha suscitato notevole interesse nel mondo immobiliare.
SENTENZE ITALIANE ED EUROPEE
Recenti pronunce giurisprudenziali, sia italiane sia europee, hanno progressivamente delineato i contorni giuridici di questa possibilità, mettendo in luce sia le opportunità sia le criticità che un eventuale cumulo di incarichi può comportare. Secondo la sentenza n. 1684/2021 del Tribunale di Genova, non esiste, nell'ordinamento italiano, un divieto assoluto che impedisca a un soggetto di svolgere simultaneamente l’attività di agente immobiliare e quella di amministratore di condominio. Nessuna norma del Codice civile né delle leggi speciali in materia di mediazione o di gestione condominiale vieta espressamente il doppio incarico. Tuttavia, la compatibilità formale non esaurisce la questione. È il rischio di conflitto di interessi a rappresentare la vera linea di attenzione. Come ha evidenziato il Tar Emilia-Romagna nella sentenza n. 7/2022, il conflitto può emergere quando l’attività di amministrazione assume una dimensione imprenditoriale prevalente, con una struttura organizzata e una gestione di numerosi immobili. In tali casi, il rischio è che l'amministratore-agente possa trovarsi nella condizione di promuovere la compravendita o la locazione di unità immobiliari che egli stesso gestisce, minando la propria neutralità professionale. La Corte di Giustizia dell'Unione Europea, con la sentenza del 4 ottobre 2024 (causa C-638/23), ha aggiunto un'importante chiave di lettura. Secondo i giudici europei, un divieto generale di cumulo delle due attività sarebbe sproporzionato rispetto agli obiettivi di tutela del consumatore

e di concorrenza. Tuttavia, gli Stati membri e le autorità nazionali sono legittimati a imporre regole di vigilanza stringenti e controlli rigorosi caso per caso, al fine di prevenire e sanzionare effettive situazioni di conflitto di interessi. La libertà di esercizio delle professioni non può sacrificare l’imparzialità dovuta ai clienti e ai condomini amministrati. In tale contesto, il rispetto della trasparenza, della separazione operativa tra le attività e della corretta informativa preventiva diventa imprescindibile. Il professionista deve adottare misure organizzative tali da rendere evidente e tracciabile ogni operazione svolta, mantenendo banche dati separate, separando gli strumenti di comunicazione e assicurando che l'una attività non condizioni l’altra, né in modo diretto né indiretto. Anche sotto il profilo delle responsabilità, i rischi non sono trascurabili. Il Tribunale di Nocera Inferiore, con la sentenza n. 1702/2022, ha ribadito che l’amministratore di condominio è tenuto a operare con la diligenza qualificata prevista dall’art. 1176, comma 2, del Codice civile, a giustificare il proprio operato mediante adeguata documentazione e a rispondere ex art. 1218 c.c. per eventuali inadempimenti. Un comportamento che favorisca, anche
solo indirettamente, interessi commerciali personali a scapito della correttezza nell’amministrazione condominiale può quindi generare responsabilità contrattuali, risarcitorie e disciplinari. A ciò si aggiunge l'obbligo, per gli amministratori di condominio, di garantire il rispetto dei requisiti di professionalità e onorabilità imposti dall'art. 71-bis disp. att. c.c. La Corte di Cassazione, con la sentenza n. 28196/2024, ha chiarito che tali requisiti sono inderogabili: la loro assenza comporta la nullità della nomina e l'invalidità dell'attività svolta.
OBBLIGHI NORMATIVI
E FORMAZIONE PROFESSIONALE
Non meno importante è l’obbligo di formazione continua, introdotto dal D.M. 140/2014. Questo decreto prevede che l’amministratore debba frequentare annualmente corsi di aggiornamento della durata minima di 15 ore, su materie giuridiche, tecniche e gestionali attinenti al condominio e alla sicurezza degli edifici. L’inadempimento a tale obbligo di aggiornamento professionale può comportare la decadenza dall’incarico. Pertanto, chi svolge contemporaneamente attività di agente immobiliare e di amministratore deve organizzarsi per mantenere aggiornata la propria preparazione in entrambe le discipline, senza deroghe né sovrapposizioni superficiali.
GESTIONE CORRETTA PER EVITARE RISCHI PROFESSIONALI
Dal punto di vista pratico, la gestione del doppio ruolo richiede quindi grande attenzione: protezione dei dati personali dei condomini, gestione separata delle informazioni commerciali, trasparenza nei rapporti contrattuali, adozione di codici di condotta e, in caso di dubbio, astensione da ogni attività che possa configurare anche solo potenzialmente una violazione dell’imparzialità dovuta. Nonostante le complessità, è giusto evidenziare anche gli aspetti positivi. Il cumulo delle due attività, come riconosciuto dal TAR Emilia-Romagna, può arricchire il bagaglio professionale del soggetto, migliorandone la capacità di analisi tecnica degli immobili, la comprensione delle dinamiche condominiali e la completezza delle informazioni fornite ai clienti.
In definitiva, sebbene l'ordinamento non preveda un divieto assoluto al cumulo dei due ruoli, la coesistenza delle attività di agente immobiliare e amministratore di condominio richiede un approccio organizzativo rigoroso, un elevato livello di professionalità e una costante attenzione ai principi di trasparenza, correttezza e imparzialità. Solo così sarà possibile evitare rischi di conflitto, di contenzioso e di danno reputazionale, garantendo al tempo stesso un servizio di qualità sia ai clienti acquirenti che ai condomini amministrati.


Il Superbonus 110% ha generato opportunità e criticità per i professionisti tecnici, spesso non pagati per incarichi eseguiti su cantieri mai avviati. Tra mediazioni, inadempimenti e giurisprudenza in evoluzione, emerge la necessità di garantire compensi chiari e strumenti efficaci per il recupero crediti
Negli ultimi anni, il Superbonus 110% ha rappresentato una delle principali leve di rilancio dell’economia italiana nel settore edilizio, promettendo riqualificazioni energetiche e antisismiche a costo zero per i cittadini. In questo scenario di grande entusiasmo, migliaia di professionisti – ingegneri, architetti, geometri, tecnici specializzati – si sono mobilitati con impegno e competenza per realizzare studi di fattibilità, progetti esecutivi, diagnosi energetiche, pratiche amministrative e asseverazioni tecniche, indispensabili per dare avvio ai lavori.
xTuttavia, al di sotto di questa superficie di opportunità si è andata progressivamente formando una crisi silenziosa e profonda: quella dei professionisti che, a distanza di mesi o anni, non sono stati pagati per il loro lavoro a causa del blocco o del mancato avvio dei cantieri. Gli ostacoli normativi, i continui cambiamenti delle regole, la saturazione del mercato del credito fiscale e il conseguente blocco della cessione dei crediti hanno generato una situazione paradossale: il progetto veniva commissionato, il professionista lo realizzava, ma poi il cantiere non partiva e il pagamento veniva rinviato, contestato o addirittura negato. In molti casi, il compenso dei tecnici era subordinato all’effettivo avvio dei lavori o alla monetizzazione dei crediti fiscali. Ma con il sistema paralizzato, il rischio operativo si è interamente riversato sui professionisti, che hanno dovuto sostenere costi vivi – visite in loco, rilievi, documentazione, polizze assicurative – senza ricevere alcun corrispettivo. Il principio basilare della prestazione professionale, secondo cui il compenso è dovuto al momento dell’esecuzione dell’opera, è stato disatteso, trasformando i liberi professionisti in finanziatori involontari di un sistema in crisi. Questa situazione ha avuto conseguenze drammatiche. Studi tecnici, anche di lunga tradizione, si sono trovati sull'orlo del fallimento; giovani professionisti, che avevano investito tempo CANTIERI
e risorse confidando nelle prospettive offerte dal Superbonus, hanno accumulato debiti o sono stati costretti ad abbandonare l'attività. Si è creata una crisi di fiducia profonda, non solo nei confronti delle istituzioni, ma anche nei rapporti tra professionisti e committenti, spesso entrambi vittime di un meccanismo legislativo incerto e instabile. A complicare ulteriormente il quadro è intervenuta l’ambiguità contrattuale. In assenza di contratti chiari che definissero in modo autonomo il diritto al pagamento della prestazione professionale, molti tecnici si sono trovati in difficoltà a far valere le proprie ragioni. Le cause civili, lunghe e costose, non sempre rappresentano una soluzione praticabile, specialmente per importi che, pur significativi nel bilancio di uno studio, possono apparire "modesti" all’interno dei costi generali di un cantiere. Le associazioni di categoria hanno più volte lanciato l’allarme, chiedendo interventi urgenti: riconoscimento esplicito dell'autonomia del diritto al compenso rispetto all’andamento dell’opera, garanzie finanziarie obbligatorie per l'affidamento degli incarichi professionali, procedure semplificate per il recupero dei crediti. Tuttavia, gli interventi normativi sono stati finora insufficienti o tardivi, lasciando migliaia di tecnici in una situazione di stallo. In questo contesto, emerge l'urgenza di una riflessione più ampia sul valore del lavoro professionale e sulla tutela dei diritti di chi, con competenza e responsabilità, mette la propria firma su documenti fondamentali per la sicurezza e la qualità delle opere. Non si può più permettere che il peso dell’instabilità normativa e finanziaria ricada interamente su chi ha già svolto la propria parte con correttezza. Il caso dei cantieri Superbonus non partiti non è solo una vicenda tecnica o amministrativa: è una questione di dignità professionale e di sostenibilità economica di un intero comparto. Questo fenomeno, che inizialmente poteva sembrare una criticità occasionale, si è trasformato in una vera emergenza: i professionisti si sono ritrovati a fronteggiare la necessità di recuperare crediti spesso di rilevante entità, senza disporre di strumenti rapidi ed efficaci. A peggiorare la situazione ha contribuito la natura dei rapporti instaurati: in molti casi, l'incarico è stato regolato da un contratto d’opera intellettuale, talvolta in forma orale o con accordi scritti non dettagliati, rendendo più complesso l'accertamento giudiziale del credito.
MEDIAZIONE E RECUPERO CREDITI
In questo quadro, assume particolare rilievo la disciplina in materia di mediazione introdotta dal decreto legislativo 4 marzo 2010, n. 28, che, all’articolo 5, più volte rivisto, ha previsto l’obbligatorietà del tentativo di mediazione in alcune materie specifiche, tra cui, a partire dal 30 giugno 2023, anche le controversie derivanti da
contratti d’opera intellettuale. In altre parole, prima di poter adire il Tribunale per ottenere il pagamento del proprio compenso, il professionista è oggi obbligato ad esperire un procedimento di mediazione. La mediazione rappresenta un passaggio non solo obbligato, ma, nonostante le buone intenzioni alla base della normativa, restano però criticità operative. I professionisti, infatti, già provati dal mancato pagamento delle proprie parcelle, si trovano ulteriormente gravati dai costi e dai tempi di un procedimento ulteriore rispetto al processo civile. Inoltre, il successo della mediazione dipende in larga misura dalla disponibilità delle parti e dalla qualità dell’organismo di mediazione scelto, elementi che non sempre sono prevedibili o controllabili. Tra l’altro, in assenza di contratti scritti chiari e completi, la fase di mediazione può trasformarsi in un ulteriore terreno di scontro interpretativo, anziché agevolare una soluzione rapida. Per questo motivo, assume importanza vitale per i professionisti – anche in vista di eventuali future controversie – formalizzare per iscritto ogni incarico, definendo in modo puntuale l'oggetto della prestazione, il compenso pattuito, le condizioni di pagamento e le eventuali clau -


sole relative alla sospensione o risoluzione del rapporto. Secondo i dati pubblicati dall'Osservatorio Nazionale sulla Mediazione Civile, nel 2023 sono stati registrati 178.182 procedimenti di mediazione civile e commerciale, segnando un aumento rispetto ai 155.122 del 2022. Tra le controversie maggiormente trattate in mediazione si confermano quelle in tema di diritti reali (15%), contratti bancari (13%), condominio (13%) e locazione (10%). Sebbene non siano disponibili dati specifici sulle controversie relative ai contratti d'opera intellettuale, l'inclusione di questa materia tra quelle soggette a mediazione obbligatoria lascia presumere un incremento delle procedure avviate dai professionisti per il recupero dei loro crediti.
La giurisprudenza recente ha affrontato il tema del pagamento dei compensi ai professionisti per progetti legati al Superbonus 110% non realizzati. Ad esempio, il Tribunale di Monza, con la sentenza n. 3106 del 28 dicembre 2024, ha condannato un condominio al pagamento della parcella di un architetto, nonostante i lavori non fossero stati avviati. Il giudice ha ritenuto che la delibera assembleare che conferiva l'incarico e stabiliva il compenso costituisse un impegno vincolante, indipendentemente dall'effettiva esecuzione dei lavori. In un'altra pronuncia, il Tribunale di Ancona ha affermato che il professionista che pretende l'onorario per lo studio di fattibilità deve provare il conferimento dell'incarico ricevuto dai condomini. Il Tribunale di Brescia ha confermato l'obbligo di pagamento al geometra, chiarendo che le difficoltà economiche e i problemi con i bonus edilizi non erano imputabili al professionista. Il Giudice ha stabilito che il
professionista aveva svolto correttamente il proprio lavoro e che le difficoltà economiche della committente non potevano essere imputate all'operato del geometra. Queste sentenze, per quanto la giurisprudenza in materia sia ancora in continua evoluzione, evidenziano l'importanza delle delibere assembleari nel determinare l'obbligo di pagamento dei compensi ai professionisti, anche in assenza dell'effettiva realizzazione dei lavori. Generalmente, la giurisprudenza tende a riconoscere il diritto al compenso quando l'incarico è stato conferito formalmente e il professionista ha svolto le attività previste, indipendentemente dall'esito finale del progetto.
COMPENSO STRAORDINARIO
PER GLI AMMINISTRATORI DI CONDOMINIO
Un altro scenario estremamente complesso è quello che si apre per gli amministratori di condominio coinvolti nei cantieri Superbonus 110% e che richiedono il pagamento delle proprie competenze anche per tutta la fase “preliminare” di ricerca dei professionisti e delle imprese, con i contatti continui con i tecnici, con la raccolta dei dati dei condomini anche per i lavori trainati, nella convocazione delle necessarie assemblee, coordinando le attività preliminari, gestendo le pratiche burocratiche e interfacciandosi con i professionisti coinvolti. Tali attività, che eccedono le ordinarie mansioni amministrative, giustificano il riconoscimento di un compenso straordinario, distinto da quello ordinario previsto per la gestione corrente del condominio. L'amministratore, all'atto dell'accettazione della nomina o del rinnovo, deve specificare analiticamente l'importo dovuto a titolo di compenso per l'attività svolta. Per le attività straordinarie legate al Superbonus, è fondamentale che l'assemblea condominiale deliberi un compenso aggiuntivo, approvando preventivamente l'importo o la modalità di calcolo. Il compenso straordinario può essere determinato secondo diverse modalità: una questione rilevante riguarda il diritto dell'amministratore a percepire il compenso straordinario anche nel caso in cui i lavori non vengano effettivamente avviati. La giurisprudenza ha riconosciuto che, se l'amministratore ha svolto attività preparatorie e gestionali in vista dell'intervento, ha diritto al compenso per le prestazioni effettivamente rese, indipendentemente dall'esito finale del progetto. Pertanto, l'amministratore di condominio ha diritto a un compenso straordinario per le attività connesse al Superbonus, anche in caso di mancato avvio dei lavori, purché tali attività siano state effettivamente svolte e correttamente documentate. La formalizzazione preventiva del compenso e la chiarezza nei ruoli assunti dall'amministratore sono fondamentali per evitare controversie e per garantire la corretta gestione delle risorse condominiali.


Nuova edizione nell’era del superbonus: nuove schede, nuovi suggerimenti, nuovi commenti: l’edizione 2023 della Guida ha sempre il comodo formato tascabile (cm. 15 X 21) e rappresenta un indispensabile strumento di consultazione sulle novità normative, su tutti gli incentivi fiscali e, attraverso schede sintetiche, fornisce informazioni sui principali interventi per l’efficientamento e la manutenzione dei condomini.
COMPRA LA TUA COPIA € 9,00

Attraverso l’esclusivo contributo di importanti esperti, la Guida affronta i problemi del condominio partendo dalle soluzioni tecnicamente ed economicamente più valide per migliorare la qualità della vita nei condomini. L’abbonamento a CONDOMINIO Sostenibile e Certificato comprende anche l’edizione digitale per sfogliare in anteprima tutto quanto c’è di più nuovo nel mercato e avere sempre a portata di clic la rivista.
ABBONATI ADESSO
1 anno
6 numeri
€ 31,00
anziché € 39,00
STUDIO GESTIONI IMMOBILIARI

Studio Gestioni Immobiliari, Roma
La pandemia ha trasformato la gestione condominiale, aumentando il contenzioso e ridefinendo le aspettative verso gli amministratori. Stefano Bianchi racconta come reperibilità, tempestività e ascolto siano diventati requisiti essenziali per mantenere la fiducia dei condomini e affrontare nuove sfide
La pandemia ha cambiato il condominio e dopo come si resta un punto di riferimento? Negli ultimi anni, la pandemia di Covid-19 ha modificato profondamente il panorama condominiale. Oltre alle responsabilità tradizionali, gli amministratori si sono trovati a fronteggiare nuove sfide legate alle difficoltà nei rapporti umani e all'aumento del contenzioso tra condomini. Vi proponiamo il racconto che ci ha fatto
Stefano Bianchi, fondatore dell’omonimo Studio Gestioni Immobiliari nell’intervista che ci ha concesso. “Abbiamo mantenuto la fiducia dei nostri condomini – esordisce Stefano - grazie alla nostra esperienza trentennale e alla capacità di essere un punto di riferimento solido.
Addirittura, alcuni clienti che avevano scelto altre realtà sono tornati, non trovando altrove la stessa professionalità, rapidità e puntualità”.
La lezione che ne hai ricavato?
Reperibilità, tempestività e attenzione alle comunicazioni non sono più optional: sono la chiave di successo per ogni studio di amministrazione.
Non basta il bilancio: quali sono i nuovi parametri di scelta per l'amministratore?
Un’amministrazione impeccabile non si basa solo sulla precisione contabile o sull’osservanza della normativa. Oggi sono la rapidità di intervento, la disponibilità e il rispetto delle comunicazioni. È questo che davvero fa la differenza. In un mercato dove il prezzo più basso spesso prevale,


la professionalità richiede di essere valorizzata adeguatamente.
Aspettative elevate devono coincidere con risultati di alto livello. Esperienza e titoli devono rappresentare un marchio di qualità, non un costo da comprimere. La casa: bene primario e motore della vocazione professionale. Perché scegliere proprio il settore condominiale?
La casa è un bene primario, amato dalla stragrande maggioranza degli italiani. Proprio questo valore ha motivato la scelta di un settore ancora oggi bisognoso di miglioramenti normativi. Auspico la creazione di un ordine professionale che possa garantire standard di qualità più alti e limitare l'accesso indiscriminato a una professione così delicata.
Conflittualità condominiale: quando l'ascolto è l’arma vincente
Oggi più che mai l’amministratore deve essere anche un abile mediatore. La gestione corretta ed efficiente e la disponibilità all'ascolto sono essenziali per dirimere controversie e ridurre i conflitti. Le emergenze, poi, regalano sempre aneddoti indimenticabili. Come quello raccontato da un collega. Durante una disostruzione, la troppa
pressione del mezzo autospurgo ha finito per allagare un appartamento di acque nere! Da qui la sottolineatura di un altro aspetto imprescindibile: è obbligo dell’amministratore verificare la professionalità di ogni ditta chiamata a operare nel condominio. Una negligenza può trasformarsi in responsabilità diretta.
Il futuro: oltre l'amministrazione, verso una gestione evoluta?
La figura dell’amministratore di condominio si sta trasformando profondamente. Oggi è richiesto un vero esperto, capace di unire conoscenze tecniche, capacità relazionali e prontezza d’intervento. Guardando alle esperienze estere, si intravede una gestione sempre più strutturata e orientata a costruire un rapporto di fiducia con i condomini, il famoso intuitus personae. Professionalità, rapidità e reperibilità non sono più plus: sono requisiti minimi. Solo chi saprà investire su sé stesso e sulla qualità potrà vincere la sfida della nuova gestione condominiale. Solo su queste basi sarà possibile arricchire l'offerta con nuovi servizi e affrontare un mercato sempre più competitivo. Lo Studio Gestioni Immobiliari Stefano Bianchi dimostra che l’eccellenza è possibile anche nella complessa giungla romana.

Avv. Carlo Pikler* Vicepresidente de Il Foro Immobiliare
La nuova classificazione Ateco modifica l’inquadramento fiscale dei condomìni e degli amministratori. L’aggiornamento dei codici è essenziale per evitare sanzioni e garantire la conformità con gli obblighi previdenziali e assicurativi. Verifica e adeguamento sono fondamentali per una gestione corretta
Avv. Carlo Pikler*

Nel mondo immobiliare e condominiale, l'attenzione agli aggiornamenti normativi non è solo una buona pratica: è una vera e propria necessità. Negli ultimi mesi, uno dei cambiamenti più rilevanti riguarda l'entrata in vigore della nuova classificazione Ateco 2025, che ha ridisegnato alcuni fondamentali parametri anche per i condomìni e per gli amministratori di condominio. Conoscere e comprendere queste modifiche è oggi imprescindibile per garantire una gestione corretta e priva di rischi. Il 1° aprile 2025 è entrata in vigore la nuova classificazione delle attività economiche, nota come Ateco 2025. Questa revisione ha portato modifiche significative anche per i condomìni e per gli amministratori di condominio, implicando la necessità di adeguarsi rapidamente per evitare rischi e sanzioni.
Tra le principali novità si segnala la soppressione del codice Ateco 97.00.02, che in passato identificava i condomìni privi di personale dipendente. Tale codice è stato sostituito, con l'effetto che oggi tutti i condomìni, a prescindere dalla presenza o meno di lavoratori subordinati, rientrano nel codice 97.00.10, relativo alle attività di famiglie e convivenze come datori di lavoro per personale domestico. Questo cambiamento comporta una conseguenza importante: ogni condominio viene automaticamente considerato, ai fini previdenziali e assicurativi, un datore di lavoro. L’impatto operativo di questa novità non è trascurabile. I condomìni sono infatti tenuti a verificare il proprio codice Ateco e, se necessario, procedere all’aggiornamento della propria posizione presso l’Agenzia delle Entrate. La corretta indicazione del codice è fondamentale anche per assicurare la conformità con gli obblighi Inps e Inail, ed è determinante per accedere a eventuali agevolazioni fiscali o contributive. Una classi -
ficazione errata o un’omissione dell’adeguamento, oltre a generare incertezza nei rapporti con enti previdenziali e fiscali, può comportare l’irrogazione di sanzioni amministrative, il ricalcolo dei contributi e l’esclusione da bandi e bonus destinati al settore immobiliare. Tra i principali pericoli, vi è il rischio di vedersi contestare contributi non versati o versati in misura errata, con conseguente richiesta di pagamenti arretrati maggiorati di sanzioni e interessi. Se, ad esempio, un condominio impiega un dipendente, ma il codice Ateco dichiarato non rispecchia l'attività di datore di lavoro, l’Inps o l’Inail possono contestare il corretto inquadramento e ricalcolare i contributi dovuti sulla base delle tariffe e delle aliquote più appropriate, con aggravio economico rilevante. Un errore nel codice Ateco può poi causare la mancata copertura assicurativa per infortuni sul lavoro: ciò significa che, in caso di incidente occorso a un portiere, a un addetto alle pulizie o a un manutentore, il condominio potrebbe trovarsi esposto a un'azione di risarcimento danni diretta, senza la tutela dell'assicurazione obbligatoria. A livello fiscale, un codice errato può comportare conseguenze anche sulla corretta presentazione delle dichiarazioni periodiche. Le comunicazioni errate potrebbero invalidare pratiche di accesso a crediti d’imposta, bonus edilizi o altre agevolazioni. Infatti, molte misure di sostegno prevedono la coerenza tra l'attività dichiarata e il beneficio richiesto; un disallineamento potrebbe comportare la revoca dell’agevolazione, con obbligo di restituzione delle somme percepite, maggiorate di sanzioni e interessi.
OBBLIGHI
DEGLI AMMINISTRATORI
Accanto ai cambiamenti che riguardano direttamente i condomìni, rilevano anche le modifiche introdotte per l’attività degli amministratori. Il codice 68.32.00, che fino al 2025 descriveva l’attività di gestione di immobili per conto terzi, è stato sostituito dal nuovo codice 68.32.01. Quest'ultimo non si limita a individuare genericamente l’amministrazione di immobili, ma offre una descrizione più dettagliata, comprendendo l’amministrazione di condomìni, la gestione di multiproprietà, la riscossione di canoni di locazione e altre attività affini. Per gli amministratori, il cambiamento implica l’obbligo di verificare la propria posizione fiscale. Coloro che risultano iscritti nel Registro delle Imprese devono aggiornare il codice Ateco attraverso la procedura di Comunicazione Unica (ComUnica). I soggetti non iscritti, invece, dovranno procedere all’aggiornamento tramite i modelli AA7/10, AA9/12 o AA5/6, a seconda della loro configurazione fiscale. È essenziale compiere questo adempimento per mantenere la regolarità fiscale e assicurativa, in quanto la mancata correzione del codice potrebbe comportare

errori nella gestione contributiva dei dipendenti del condominio e pregiudicare la corretta copertura assicurativa, con rilevanti conseguenze in caso di infortuni o contestazioni ispettive.
DELLA NUOVA CLASSIFICAZIONE
La nuova classificazione Ateco 2025, dunque, non dev’essere sottovalutata. La tempestiva verifica e l’adeguamento dei codici rappresentano un dovere imprescindibile per chi opera nell’ambito condominiale. Mantenere aggiornata la propria posizione non solo tutela contro il rischio di sanzioni, ma consente anche di beneficiare di eventuali agevolazioni previste per il settore immobiliare e condominiale.
Adeguarsi oggi significa prevenire problemi domani: chi si occupa della gestione dei condomìni sa bene quanto sia importante non lasciare nulla al caso. La sfida della nuova classificazione Ateco può diventare un'opportunità per dimostrare professionalità, attenzione e competenza, elementi sempre più determinanti nel complesso panorama della gestione immobiliare moderna.

Avv. Vincenzo Nasini
Cassazionista Foro
di Genova
Vicepresidente
Confedilizia
Nazionale

Una sentenza che fa chiarezza sul confine tra responsabilità individuale e collettiva in condominio
Violazioni condominiali e responsabilità giuridica
Una recente pronuncia del Tribunale di Genova (sentenza n. 3313 del 19 dicembre 2024) offre l’occasione per riflettere, con rigore giuridico e concretezza, su un tema di costante attualità nella vita condominiale: la violazione delle regole comuni da parte di singoli condomini e il ruolo – spesso equivocato – dell’amministratore e del condominio stesso.
Il problema dell’accesso ai box auto
Il caso sottoposto all’attenzione del giudice ligure riguarda la difficoltà di accesso a un box auto, causata da ripetuti parcheggi impropri da parte di altri condomini negli spazi di manovra antistanti. Tali spazi, secondo quanto previsto espressamente dal regolamento condominiale, avrebbero dovuto rimanere liberi proprio per consentire un’agevole fruizione delle autorimesse. Nonostante un tentativo di mediazione, conclusosi con l’accordo bonario di installare una fioriera come deterrente, il problema si è ripresentato. Il proprietario del box ha quindi deciso di adire il Tribunale per ottenere la condanna del condominio all’adozione di misure strutturali atte a impedire la sosta abusiva (come dissuasori o altri presidi), oltre alla rimozione di un cartello che autorizzava – in modo ambiguo – la sosta ai soli residenti, e persino un risarcimento per la ridotta fruibilità del proprio bene.
La responsabilità individuale dei condomini
La risposta della giurisprudenza è netta: il condominio, in quanto ente di gestione privo di personalità giuridica, non può essere chiamato a rispondere degli illeciti posti in essere dai singoli condomini in modo autonomo e individuale. Si tratta di una pronuncia che richiama i principi fondanti della responsabilità civile condominiale, ribadendo come le violazioni del regolamento da parte di alcuni non possano essere automaticamente imputate alla compagine nella sua interezza. Il Tribunale ha infatti evidenziato l’infondatezza della pretesa attorea, dichiarando le domande inammissibili e condannando il ricorrente alle spese di giudizio. Sotto il profilo tecnico, il punto centrale è quello della legittimazione passiva. In termini semplici, questo principio stabilisce che si può essere chiamati a rispondere in giudizio solo se si è effettivamente – o quantomeno presuntivamente – titolari dell’obbligo giuridico oggetto della causa. Nel caso di specie, il condominio non era parte direttamente obbligata a impedire i comportamenti lesivi, poiché le infrazioni erano riconducibili a soggetti specifici, ossia alcuni condomini, e non al condominio nel suo complesso. Non basta affermare che il regolamento condominiale è stato violato: occorre individuare chi materialmente ha posto in essere la condotta lesiva. E se si intende agire contro l’intera compagine, occorre dimostrare una responsabilità collettiva, ad esempio derivante

da una deliberazione assembleare, oppure da un’omissione dell’amministratore in presenza di reiterate segnalazioni. Il regolamento, laddove preveda obblighi a carico dei singoli, impone che le azioni giudiziarie vengano intraprese direttamente contro i trasgressori, senza scorciatoie.
Il ruolo dell’amministratore e i suoi doveri
La pronuncia, tuttavia, non deresponsabilizza l’amministratore, anzi ne definisce con precisione il perimetro dei doveri. È compito dell’amministratore – ex art. 1130 c.c. – curare l’osservanza del regolamento. Per farlo, ha a disposizione strumenti progressivi: può iniziare con un richiamo verbale, proseguire con una diffida formale e, in caso di inerzia, può e deve agire in giudizio per far cessare l’abuso. Questo è un potere che si traduce anche in un obbligo, specie quando la violazione lede in modo diretto e continuativo i diritti di altri condomini. Tuttavia, la sua eventuale inattività non determina la responsabilità dell’intero condominio, ma può far sorgere, al più, una responsabilità personale per mala gestio. In casi estremi, ciò può giustificare persino la revoca giudiziale dell’amministratore, se integrano le “gravi irregolarità” di cui all’art. 1129 c.c.
Uso delle parti comuni e limiti giuridici
Un ulteriore aspetto chiarito dalla sentenza riguarda l’uso delle parti comuni. Il giudice ricorda che,
in assenza di accordo assembleare, non si può chiedere al Tribunale – in sede contenziosa – di imporre misure gestionali o regolamentari. Questo perché la gestione della cosa comune spetta all’assemblea dei condomini, e non può essere surrogata dal giudice, se non nei casi previsti dalla legge, e comunque solo in sede di volontaria giurisdizione. Il Tribunale ha richiamato in proposito un orientamento consolidato secondo cui il singolo non può ottenere dal giudice provvedimenti diretti a organizzare l’uso delle cose comuni, poiché tale funzione appartiene esclusivamente all’organo collegiale.
chiare per una gestione corretta
In definitiva, il Tribunale di Genova ci restituisce un quadro limpido: il diritto condominiale non ammette soluzioni semplificate. Chi subisce una lesione deve individuare con precisione l’autore del comportamento illecito. L’amministratore è il primo garante del rispetto delle regole, ma non può essere trasformato in un capro espiatorio passivo delle negligenze altrui, né il condominio può essere chiamato a rispondere in blocco per colpe individuali. La strada per tutelare i propri diritti, insomma, c’è – ma va percorsa con gli strumenti giusti, nel rispetto delle competenze e dei ruoli di ciascun attore della complessa dinamica condominiale.

Attraverso i moduli BTdin with Netatmo sono gestibili tutte le funzioni legate al concetto di casa green, come il controllo dei carichi per l’autoconsumo da fonti rinnovabili, il monitoraggio flussi energetici
LFranco Saro
In alto, con il Quadro elettrico Smart BTDIN with Netatmo si ottiene il pieno controllo della casa, dalle luci ai dispositivi ad elevato consumo energetico attraverso lo smartphone
a digitalizzazione passa attraverso l’informazione condotta da circuiti, processori e memorie nei diversi dispositivi. Ma può passare anche attraverso l’impianto elettrico, anzi, può contribuire alla gestione di carichi elettrici e consumi nelle abitazioni. Un traguardo importante non solo per diminuire gli oneri sulla bolletta, ma anche in vista degli obiettivi di sostenibilità contenuti nella direttiva Case green. Temi affrontati nel workshop tematico intitolato La prospettiva del Real Estate sugli Smart Building della Community Smart Building, organizzato con The European HouseAmbrosetti, e che ha coinvolto gli operatori della filiera, tra cui BTicino, per indagare l’evoluzione del parco immobiliare italiano in termini di efficienza energetica.
GLI OBIETTIVI GREEN
In vista dell’attuazione della direttiva europea, dunque, dal 2026 è prevista la riduzione del consumo di energia degli edifici residenziali del 16% entro il 2030 e del
20-22% entro il 2035. Il 55% di questa riduzione dovrà essere ottenuta tramite la ristrutturazione. Secondo la ricerca del centro studi Ambrosetti, gli interventi di efficienza energetica migliorano notevolmente il valore degli immobili sul mercato, che possono valere fino al 43% in più rispetto a uno abitabile e fino all'80% in più rispetto a uno da ristrutturare. Inoltre, l'efficientamento energetico può aiutare anche nella riduzione dei consumi fino al 29%, con un risparmio economico netto tra i 17 e i 19 miliardi di euro all'anno.
In quest’ottica, BTicino vuole accrescere la consapevolezza su quanto consumano le abitazioni e su come efficientare al meglio la propria casa. Una soluzione, secondo l’azienda, è offrire all’utente un unico strumento, semplice da utilizzare, per garantire la gestione dei consumi al 100% e la massima riduzione degli sprechi. La progettazione di sistemi Building & Automation Control System (Bacs) elaborati da BTicino includono gli strumenti digitali di automazione e regolazione intelligente, che permettono di controllare e rendere automatiche alcune operazione al fine ultimo della riduzione dei consumi energetici complessivi.
Tra le soluzioni che consentono il controllo dei carichi in ambito residenziale, BTicino ha sviluppato Btdin with Netatmo, la gamma di moduli Din intelligenti da installare direttamente nel quadro elettrico, che comprendono soluzioni per la gestione dei carichi e misuratori dei consumi.
Attraverso i moduli BTdin with Netatmo sono gestibili

tutte le funzioni legate al concetto di casa green, come il controllo dei carichi per l’autoconsumo da fonti rinnovabili, il monitoraggio flussi energetici (produzione e consumo) e la gestione della ricarica dei veicoli elettrici. Tramite smartphone con l’app Home + Control di BTicino, inoltre, è possibile gestire luci ed elettrodomestici, monitorare i consumi totali della casa, ricevere notifiche circa lo stato dell’impianto e soprattutto definire carichi prioritari e secondari, che il sistema gestirà automaticamente per evitare il blackout. Per una scelta dei moduli utili per la gestione dell’impianto con la produzione fotovoltaica, BTicino ha creato il nuovo kit per il fotovoltaico residenziale (che contiene un modulo di misura monofase, uno di controllo carichi e un gateway) per la gestione della produzione energetica tramite automazioni e la visualizzazione in tempo reale dei dati energetici. Il sistema supporta anche l’integrazione con la piattaforma Home + Control per una gestione avanzata, attraverso l’impostazione di scenari: per esempio, in concomitanza con l’avvio di un elettrodomestico, l’accensione e lo spegnimento dei carichi può essere programmata in modo tale da non attingere dalla rete ma dall’energia autoprodotta dal sistema fotovoltaico.

Per porre quesiti a Gaia Cigognini potete scrivere a info@vgambinoeditore.it
Egregia dottoressa, scrivo per chiederle un parere sul discutibile atteggiamento del condomino che si è assunto l’onere di fare l’amministratore del nostro condominio. Può darsi che il suo comportamento derivi dal fatto che non è un professionista, ma sta di fatto che questo signore si rifiuta, nella sostanza, di affrontare qualsiasi problema, anche il più banale. O lo minimizza, oppure dichiara che l’ostacolo si aggiusterà da sé. Potrebbe anche essere vero in qualche caso, ma il diniego anche di fronte all’evidenza, come guasti o necessaria manutenzione, mi sembra stiano assumendo una evidenza patologica. Potrebbe essere così?
Alvaro
S., via e-mail
Potrebbe trattarsi di una negazione cognitiva, con cui convincersi che un problema non esista o non sia importante. Si tratterebbe, se un medico lo confermasse, di un evitamento cognitivo, un meccanismo di difesa simile al diniego, per cui un individuo si rifiuta di fronteggiare situazioni, oggetti o persone che generano angoscia. Le cause, secondo la psicanalisi, possono essere diverse. Come disturbo d’ansia, l’evitamento è anche il meccanismo principale di formazione delle fobie. L’evitamento impedisce il riprodursi di condizioni spiacevoli per il soggetto, come comportamento o stile di pensiero che riesce a escludere il confronto con uno stimolo ansiogeno o doloroso. Ma, naturalmente, questa ipotesi andrebbe confermata da una diagnosi psicologica.
Cara rubrica Psicondominio, nel nostro stabile (un supercondominio composto da quattro edifici), le periodiche assemblee sono piuttosto complesse. Come sempre, ognuno vuole dire la sua e spesso i pareri contrastano. Ma questo è il minore dei mali. Il vero problema è la presenza di un proprietario di unità immobiliare che si è assunto il ruolo di bastian contrario. E non si tratta di sporadiche rivendicazioni, ma di una costante, assoluta, rigida presa di posizione contro qualsiasi proposta o decisione, perfino quelle più banali e di normale routine. Dato che le sue prese di posizione sono evidentemente assurde, cadono nel vuoto. Ma il
disturbo rimane. Sono arrivata a pensare che si tratti di una turbolenza mentale. Che ne dice?
Gianna N., via e-mail
Ci sono persone che devono sempre prendere la parola per controbattere, polemizzare, rimarcare una differenza, portare l’esempio che contraddice chi ha appena parlato. Contraddire può far sentire più forti, mentre dare ragione all’altro è vissuto come una sottomissione o l’ammissione di una dipendenza che fa paura. Premesso questo, all’origine di questo atteggiamento bellicoso possono esserci diverse motivazioni, impossibili da determinare in base al caso descritto. Il condomino in questione, per esempio, potrebbe avere subito carenze nella relazione con le figure genitoriali, oppure aver subito traumatiche ingiustizie o umiliazioni. Ancora, l’atteggiamento potrebbe essere paradossalmente provocato da insicurezza e paura di sbagliare e il confronto con il mondo essere vissuto come un ring in cui si gioca la sopravvivenza.
Psicologa, da pochi mesi si è trasferita a vivere nel nostro condominio C.B., una giovane donna che sembra una persona per bene. Forse fin troppo. È affetta, per dirla tutta, da una timidezza che sulle prime ci è sembrata causata dalla poca confidenza con il nuovo ambiente. Ma, con il passare del tempo, ora assume l’aspetto di una ritrosia poco giustificata. Qualsiasi incontro casuale sembra essere una sofferenza per questa donna, che arrossisce e riesce appena a balbettare qualche parola, come se temesse chissà che cosa. Questo atteggiamento, inoltre, non è riservato solo al nostro condominio, ma è una caratteristica costante della sua vita. Tanto che abbiamo considerato l’idea di suggerirle di affrontare il problema da uno specialista. Che ne pensa?
Laura S., via e-Mail
Sembra la descrizione del disturbo evitante di personalità. Questa patologia provoca un sentimento di inadeguatezza e inferiorità verso sé stessi, ipersensibilità al giudizio degli altri e tendenza sia ad evitare le interazioni sociali sia attività che comportano il rischio di essere criticati o rifiutati, per timore delle reazioni negative degli altri. Questa estrema timidezza e la sensazione di vergogna e imbarazzo in situazioni sociali conducono chi soffre di questo disturbo a un isolamento dal quale non riescono a uscire. In psicologia questo problema si cura con antidepressivi, naturalmente sotto prescrizione medica, e una psicoterapia.











